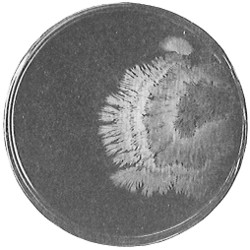

The Project Gutenberg EBook of The Fundamentals of Bacteriology, by Charles Bradfield Morrey This eBook is for the use of anyone anywhere at no cost and with almost no restrictions whatsoever. You may copy it, give it away or re-use it under the terms of the Project Gutenberg License included with this eBook or online at www.gutenberg.org Title: The Fundamentals of Bacteriology Author: Charles Bradfield Morrey Release Date: July 16, 2013 [EBook #43227] Language: English Character set encoding: UTF-8 *** START OF THIS PROJECT GUTENBERG EBOOK THE FUNDAMENTALS OF BACTERIOLOGY *** Produced by Jennifer Linklater, Jason Isbell and the Online Distributed Proofreading Team at http://www.pgdp.net
The first edition seems to have fulfilled a need for a general text-book on the subject of bacteriology. The original method of presentation is preserved. The text-book idea is adhered to, so that the individual instructor may have full liberty to expand on topics in which he is especially interested. A number of illustrations have been added, the text has been improved in many instances by the addition of further explanatory matter and the most recent general advances in the Science. Examples are the System of Classification of the Society of American Bacteriologists, which is used throughout the text, their Key to the Genera of Bacteria, a discussion of the H-ion concentration method of standardization, the selective action of anilin dyes, the mechanism of entrance of pathogenic organisms into the body, a more detailed explanation of the origin of antibodies, the nature of antigens and a table of antigens and antibodies.
Professor Vera McCoy Masters has assisted in the revision by aiding in the preparation of manuscript and the reading of proof and in the making of the index, for which services the author’s thanks are hereby expressed.
An experience of nearly twenty years in the teaching of Bacteriology has convinced the author that students of this subject need a comprehensive grasp of the entire field and special training in fundamental technic before specializing in any particular line of work. Courses at the University are arranged on this basis. One semester is devoted to General Bacteriology. During the second semester the student has a choice of special work in Pathogenic, Dairy, Soil, Water, or Chemical Bacteriology. A second year may be devoted to advanced work in any of the above lines, to Immunity and Serum Therapy, or to Pathogenic Protozoa.
This text-book is intended to cover the first or introductory semester’s work, and requires two classroom periods per week. Each student is compelled to take two laboratory periods of three hours per week along with the class work. The outline of the laboratory work is given at the end of the text. Results attained seem to justify this plan. A text-book is but one of many pedagogical mechanisms and is not intended to be an encyclopedia of the subject.
The author makes no claim to originality of content, since the facts presented are well known to every bacteriologist, though the method of presentation is somewhat different from texts in general. During the preparation of this work he has made a thorough review of the literature of Bacteriology, covering the standard text-books as well as works of reference and the leading periodicals dealing with the subject. Thus the latest information has been incorporated.
No attempt has been made to give detailed references in a work of this character.
The photomicrographs are original except where otherwise indicated and are all of a magnification of one thousand diameters where no statement to the contrary appears. These photographs were made with a Bausch & Lomb Projection Microscope fitted with a home-made camera box. Direct current arc light was used and exposures were five to ten seconds. Photographs of cultures are also original with a few indicated exceptions. All temperatures are indicated in degrees centigrade.
For use of electrotypes or for prints furnished the author is indebted to the following: A. P. Barber Creamery Supply Company, Chicago, Ill.; Bausch & Lomb Optical Company, Rochester, N. Y.; Creamery Package Manufacturing Company, Chicago, Ill.; Davis Milk Machinery Company, North Chicago, Ill.; Mr. C. B. Hoover, Superintendent of Sewage Disposal Plant, Columbus, O.; Mr. C. P. Hoover, Superintendent of Water Filtration Plant, Columbus, O.; The Hydraulic Press Manufacturing Company, Mt. Gilead, O.; Loew Manufacturing Company, Cleveland, O.; Metric Metal Works, Erie, Pa.; Sprague Canning Machine Company, Chicago, Ill.; U. S. Marine Hospital Service; Wallace and Tiernan Company, New York City, N. Y.
For the preparation of many cultures and slides, for great assistance in the reading of proof and in the preparation of the index, Miss Vera M. McCoy, Instructor in Bacteriology, deserves the author’s thanks.
The author trusts that the book will find a place in College and University courses in Bacteriology.
| Historical Introduction—Spontaneous Generation—Causation of Disease—Putrefaction and Fermentation—Study of Forms—Chronological Table | 17 |
| CHAPTER I. | |
| Position of Bacteria—Relationships to Algæ—Yeasts—Molds—Protozoa | 37 |
| PART I. MORPHOLOGY. |
|
|---|---|
| CHAPTER II. | |
| Cell Structures—Cell Wall—Protoplasm—Plasmolysis—Plasmoptysis—Nucleus—Vacuoles—Capsules—Metachromatic Granules—Flagella—Spores | 41 |
| CHAPTER III. | |
| Cell Forms—Coccus—Bacillus—Spirillum—Involution Forms | 52 |
| CHAPTER IV. | |
| Cell Groupings | 55 |
| CHAPTER V. | |
| Classification—Migula’s—Society of American Bacteriologists’—Key to the Latter | 59 |
| PART II. PHYSIOLOGY. |
|
| CHAPTER VI. | |
| Occurrence—General Conditions for Growth—Moisture—Temperature—Light—Oxygen—Osmotic Pressure—Electricity—X-rays and Radium Emanations—Pressure—Mechanical Vibration | 71 |
| CHAPTER VII. | |
| Chemical Environment—Reaction of Medium—Chemical Composition | 81 |
| CHAPTER VIII. | |
| Chemical Environment (Continued)—General Food Relationships—Metabolism of Elements | 86 |
| CHAPTER IX. | |
| Physiological Activities—Fermentation of Carbohydrates—Splitting of Fats | 93 |
| CHAPTER X. | |
| Physiological Activities (Continued)—Putrefaction of Proteins—Cycles of Nitrogen, Carbon, Sulphur, Phosphorus | 102 |
| CHAPTER XI. | |
| Physiological Activities (Continued)—Production of Acids, Gases, Esters, Alcohols, Aldehydes, Aromatic Compounds—Phosphorescence—Chromogenesis—Reduction—Oxidation—Production of Heat—Absorption of Free Nitrogen—Nitrogen Nutrition of Green Plants | 110 |
| CHAPTER XII. | |
| Physiological Activities (Continued)—Production of Enzymes—Discussion on Enzymes—Toxins—Causation of Disease | 121 |
| CHAPTER XIII. | |
| Disinfection—Sterilization—Disinfectants—Physical Agents—Pasteurization | 130 |
| CHAPTER XIV. | |
| Disinfection and Sterilization (Continued)—Chemical Agents—Anilin Dyes | 156 |
| CHAPTER XV. | |
| Disinfection and Sterilization (Continued)—Choice of Agent—Standardization of Disinfectants—Phenol Coefficient—Practical Sterilization and Disinfection | 164 |
| PART III. THE STUDY OF BACTERIA. |
|
| CHAPTER XVI. | |
| Culture Media—Broth, Milk, Gelatin, Agar, Potatoes, Blood Serum—Standardization of Media—H-ion Concentration Method—Synthetic Media | 171 |
| CHAPTER XVII. | |
| Methods of Using Culture Media—Culture Tubes—Plates—Anaërobic Cultures—Vignal Tubes—Fermentation Tubes—Deep Culture Tubes—Novy Jars—Inoculation of Culture Media | 184 |
| CHAPTER XVIII. | |
| Isolation of Bacteria in Pure Culture—Dilution—Plating—Streaking—Barber Apparatus—Aids in Isolation—Heat—Selective Antiseptics—Selective Food—-Indicators—Animal Inoculation | 194 |
| CHAPTER XIX. | |
| Study of the Morphology of Bacteria—Bacteriological Microscope—Hanging Drop Slides—Staining—Gram’s Method—Spores—Acid-fast Bacilli—Capsules—Flagella—Metachromatic Granules | 200 |
| CHAPTER XX. | |
| Study of the Physiology of Bacteria—Temperature—Incubators—Thermal Death Point—Oxygen Relationships—Study of Physiological Activities—Appearance of Growth on Culture Media—Appearance of Molds on Plate Cultures | 213 |
| CHAPTER XXI. | |
| Animal Inoculation—Material for Bacteriological Examination | 227 |
| PART IV. GENERAL PATHOGENIC BACTERIOLOGY. |
|
| CHAPTER XXII. | |
| Introduction—Infection—Acute Infection—Chronic Infection—Specific—Non-specific—Koch’s Postulates—Virulence—Susceptibility | 231 |
| CHAPTER XXIII. | |
| Pathogenic Bacteria Outside the Body—As Saprophytes—As Facultative Saprophytes—Latent—Carriers—Universal Carriers—Accidental Carriers—Necessary Intermediate Hosts | 237 |
| CHAPTER XXIV. | |
| Channels of Infection—Skin—Mucosæ—Respiratory Tract—Alimentary Tract—Mechanism of Entrance of Organisms—Dissemination in the Body—Paths of Elimination—Specificity of Location | 243 |
| CHAPTER XXV. | |
| Immunity—Natural—Artificial—Active—Passive—Production of Immunity—Vaccine—Antiserum—Practical Applications of Immunity Reactions | 250 |
| CHAPTER XXVI. | |
| Theories of Immunity—Pasteur—Chauveau—Baumgärtner—Metchnikoff—Ehrlich—Principles of Ehrlich’s Theory | 256 |
| CHAPTER XXVII. | |
| Ehrlich’s Theory (Continued)—Receptors of the First Order—Antitoxin—Antienzyme—Preparation of Antitoxins—Units | 261 |
| CHAPTER XXVIII. | |
| Ehrlich’s Theory (Continued)—Receptors of the Second Order—Agglutinins—Agglutination Reaction—Precipitins—Precipitin Test | 265 |
| CHAPTER XXIX. | |
| Ehrlich’s Theory (Continued)—Receptors of the Third Order—Cytolysins—Amboceptor—Complement—Anti-amboceptors—Antisnake Venoms—Failure of Cytolytic Serums in Practice—Complement-fixation Test | 271 |
| CHAPTER XXX. | |
| Phagocytosis—Opsonins—Opsonic Index—Bacterial Vaccines—Preparation of—Use of—Lipovaccines—Aggressins | 280 |
| CHAPTER XXXI. | |
| Anaphylaxis—Author’s Theory—Tuberculin Test—Table of Antigens and Antibodies—Summary of Immunity as Applied to Protection from Disease | 289 |
Bacteriology as a science is a development of the latter half of the nineteenth century. It may be said to have begun in the decade between 1870 and 1880, due largely to the wide circulation given to Koch’s work in proving that Bacillus anthracis is the cause of Anthrax in 1876, in devising new culture methods and in demonstrating that wound infections are due to microörganisms, 1878. Associated with this work were the great improvements in the microscope by Abbé and the introduction of anilin dyes for staining bacteria by Weigert. These results attracted workers throughout the world to the “new science.” Nevertheless, this work of Koch’s was preceded by numerous observations and experiments which led up to it. Certainly the most important discoveries immediately responsible were those of Pasteur. He must be considered as the greatest of the pioneer bacteriologists since he worked in all fields of the subject. Some of the antecedent work was done in attempting to disprove the old “spontaneous generation” theory as to the origin of organisms; some in searching for the causes of disease and some in the study of fermentation and putrefaction.
Speculation as to the first origin of life is as old as history and doubtless older. Every people of antiquity had its own legends, as for example, the account in Genesis. This question never can be definitely settled, even though living matter should be made in the laboratory.
The doctrine of the “spontaneous origin” of particular animals or plants from dead material under man’s own observation is a somewhat different proposition and may be subjected to experimental test. The old Greek philosophers believed it. Anaximander (B.C. 610–547) taught that some animals are derived from moisture. Even Aristotle (B.C. 384–322) said that “animals sometimes arise in soil, in plants, or in other animals,” i.e., spontaneously. It can be stated that this belief was general from his day down through the Dark and Middle Ages and later. Cardano (A.D. 1501–1576) wrote that water gives rise to fish and animals and is also the cause of fermentation. Van Helmont (1578–1644) gives directions for making artificial mice. Kircher (1602–1680) describes and figures animals produced under his own eyes by water on plant stems.
However, many thinkers of the seventeenth century doubted the truth of this long-established belief. Francesco Redi (1626–1698) made a number of experiments which tended to prove that maggots did not arise spontaneously in meat, as was generally believed, but developed only when flies had an opportunity to deposit their eggs on the meat. It seems that by the latter part of this century the idea that organisms large enough to be seen with the naked eye could originate spontaneously was generally abandoned by learned men.
The work of Leeuwenhoek served to suspend for a time the subject of spontaneous generation, only to have it revived more vigorously later on. He is usually called “The Father of the Microscope,” though the compound microscope was invented probably by Hans Zansz or his son Zacharias, of Holland, about 1590. Leeuwenhoek used a simple lens, but his instruments were so much more powerful that they opened up an entirely new and unknown world. (Fig. 1.)
Anthony van Leeuwenhoek (1632–1723) was apprenticed to a linen draper and accumulated a comfortable fortune in this business. He became interested in the grinding of spectacle lenses, then an important industry in Delft, Holland, where he lived, and did a great deal of experimental work in this line, mainly for his own enjoyment. Finally he succeeded in making a lens so powerful that he could see in water and various infusions very minute living bodies never before observed. Leeuwenhoek contributed 112 papers to the Royal Society of Great Britain, the first in 1673, many of them accompanied by such accurate descriptions and drawings, for example a paper submitted September 12, 1683, that there is no doubt that he really saw bacteria and was the first to do so (Fig. 2). Rightly may he be styled “The Father of Bacteriology,” if not of the microscope. He says in one paper: “With the greatest astonishment I observed that everywhere through the material I was examining were distributed animalcules of the most microscopic dimness which moved themselves about in a remarkably energetic way.” Thus he considered these living objects to be animals, from their motion, and this belief held sway for nearly two hundred years.

Leeuwenhoek was a pure observer of facts and made no attempt at speculation, but his discoveries soon started the theorists to discussing the origin of these minute organisms. Most observers, as was probably to be expected, believed that they arose spontaneously. Needham, in 1749, described the development of microörganisms around grains of barley in water. Bonnet, in 1768, suggested that probably Needham’s animalcules came from ova in the liquid. The Abbot Spallanzani, in 1769, called attention to the crudeness of Needham’s methods and later, in 1776, attempted to disprove spontaneous origin by heating infusions of organic material in flasks and then sealing them. His critics raised the objections that heating the liquids destroyed their ability to support life, and that sealing prevented the access of fresh air which was also necessary. The first objection was disproved by the accidental cracking of some of the flasks which thereafter showed an abundant growth. This accident seemed also to support the second objection, and Spallanzani did not answer it. Though Spallanzani’s experiments failed to convince his opponents, they led to important practical results, since François Appert, in 1810, applied them to the preserving of fruits, meats, etc., and in a sense started the modern canning industry.


From Spallanzani to Schultze, there were no further experiments to prove or disprove spontaneous generation. Schultze, in 1836, attempted to meet the second objection to Spallanzani’s experiment, i.e., the exclusion of air, by drawing air through his boiled infusions, first causing it to bubble through concentrated sulphuric acid to kill the “germs” (Fig. 3.). His flasks fortunately showed no growths, but his critics claimed that the strong acid changed the properties of the air so that it would not support life. This experiment of Schultze’s, though devised for a different purpose, was really the first experiment in the use of chemical disinfectants, though Thaer (page 31) had used chemicals in a practical way. Schwann, in 1837, modified this experiment, by drawing the air through a tube heated to destroy the living germs (Fig. 4). His experiments were successful but the “spontaneous generation” theorists raised the same objection, i.e., the change in the air by heating. This was the first experiment in which the principle of “dry heat” or “hot air” sterilization was used. Similar arguments were brought forward, also to the use of cotton plugs as filters by Schroeder and Dusch in 1859 (Fig. 5). This was the first use of the principle of sterilization by filtration. It remained for Chevreuil and Pasteur to overcome this objection in 1861 by the use of flasks with long necks drawn out to a point and bent over. These permitted a full access of air by diffusion but kept out living germs, since these cannot fly but are carried mechanically by air currents or fall of their own weight (Fig. 6.). Hoffman, the year before (1860), had made similar experiments but these remained unnoticed. The Pasteur flasks convinced most scientists that “spontaneous generation” has never been observed by man, though some few, notably Dr. Charlton Bastian, of England, vigorously supported the theory from the early seventies until his death in November, 1915.




John Tyndall, in combating Bastian’s views showed that boiled infusions left open to the air in a closed box through which air circulated did not show any growth of organisms provided the air was so free of particles that the path of a ray of light sent through it from side to side could not be seen (Fig. 7). Or if such sterilized infusions were exposed to dust-free air, as in the high Alps, the majority showed no growth, while all infusions in dusty air did show an abundance of organisms. Tyndall’s experiments confirmed those of Pasteur and his predecessors and showed that the organisms developed from “germs” present in the air falling into the liquids and not spontaneously.
While Tyndall’s experiments were of great value as indicated, they probably were harmful in another way. These “germs in the air” were considered by bacteriologists as well as laymen to include necessarily many disease germs and to indicate the very general, if not universal, presence of these latter in the air. This idea led to many erroneous practices in sanitation and disinfection which even to this day are not eliminated.
The transmission of disease from person to person was recognized by the ancients of European and Asiatic countries. Inoculation of smallpox was practiced in China and India probably several thousand years ago and was introduced by Lady Mary Wortley Montague into England in 1721, from Constantinople. These beliefs and practices do not seem to have been associated with any speculations or theories as to the cause of the disease.
Apparently the first writer on this subject was Varo, about B.C. 70, who suggested that fevers in swampy places were due to invisible organisms. The treatment of wounds during the thirteenth and fourteenth centuries by hot wine fomentations and by the application of plasters was based on the theory that the air brought about conditions in the wounds which led to suppuration. These practices were indeed primitive antisepsis, yet were not based on a germ theory of the conditions which were partially prevented. Fracastorius (1484–1553), in a work published in 1546, elaborated a theory of “disease germs” and “direct and indirect contagion” very similar to modern views, though based on no direct pathological knowledge. Nevertheless Kircher (mentioned already) is usually given undeserved credit for the “contagium vivum” theory. In 1657 by the use of simple lenses he observed “worms” in decaying substances, in blood and in the pus from bubonic plague patients (probably rouleaux of corpuscles in the blood, certainly not bacteria in any case). Based on these observations and possibly also on reading the work of Fracastorius, his theory of a “living cause” for various diseases was published in 1671, but received little support.
The discoveries of Leeuwenhoek which proved the existence of microscopic organisms soon revived the “contagium vivum” idea of Kircher. Nicolas Andry in a work published in 1701 upheld this view. Lancisi in 1718 advanced the idea that “animalcules” were responsible for malaria, a view not proved until Laveran discovered the malarial parasite in 1880.1 Physicians ascribed the plague which visited Southern France in 1721 to the same cause, and many even went so far as to attribute all disease to animalcules, which brought the theory into ridicule. Nevertheless the “contagium vivum” theory survived, and even Linnaeus in his Systema Naturæ (1753–6) recognized it by placing the organisms of Leeuwenhoek, the contagia of diseases and the causes of putrefaction and fermentation in one class called “Chaos.”
Plenciz, a prominent physician and professor in the Vienna Medical School, published in 1762 a work in which he gave strong arguments for the “living cause” theory for transmissable diseases. He taught that the agent is evidently transmitted through the air and that there is a certain period of incubation pointing to a multiplication within the body. He also believed that there was a specific agent for each disease. His writings attracted little attention at the time and the “contagium vivum” theory seems to have been almost lost sight of for more than fifty years. Indeed, Oznam, in 1820, said it was no use to waste time in refuting hypotheses as to the animal nature of contagium.
Isolated observers, were, however, keeping the idea alive, each in his own locality. In 1787 Wollstein, of Vienna, showed that the pus from horses with glanders could infect other horses if inoculated into the skin. Abilgaard, of Copenhagen, made similar experiments at about the same time. In 1797 Eric Viborg, a pupil of Abilgaard’s, published experiments in which he showed the infectious nature not only of the pus but also of the nasal discharges, saliva, urine, etc., of glandered horses. Jenner in 1795–98 introduced vaccination as a method of preventing smallpox. This epoch-making discovery attracted world wide attention and led to the overcoming of this scourge which had devastated Europe for centuries, but contributed little or nothing to the question of the causation of disease. Prevost’s discovery of the cause of grain rust (Puccinia graminis) in 1807 was the first instance of an infectious disease of plants shown to be due to a microscopic plant organism, though not a bacterium in this case.
Doubtless one reason why the work on glanders and grain rust attracted little attention among the practitioners of human medicine was owing to the prevalent belief in man’s complete separation from all lower forms of life. The evolutionists had not yet paved the way for experimental medicine.
In 1822 Gaspard showed the poisonous nature of material from infected wounds by injecting it into animals and causing their death. Tiedemann (1822), Peacock (1828) described “little bodies” in the muscles of human cadavers which Hilton (1832) considered to be parasitic in nature. Paget (1835) showed that these bodies were round worms and Owen (1835) described them more accurately and gave the name Trichina spiralis to them. Leidy (1846) found organisms in the muscles of hogs which he considered to be the same as Owen’s Trichina and paved the way for the work of Zenker (1860) in showing the pathological relation between the Trichina of pork and human Trichinosis. Bearing on the “contagium vivum” theory was the rediscovery of the “itch mite” (Sarcoptes scabiei) by Renucci (1834), an Italian medical student. This had been declared several hundred years before but had been lost sight of. Chevreuil and Pasteur, in 1836, showed that putrefaction did not occur in meat protected from contamination, and suggested that wound infection probably resulted from entrance of germs from without. Bassi, investigating a disease of silkworms in Italy, demonstrated that a certain mold-like fungus (Botrytis bassiana) was the cause in 1837. This was the first instance of a microscopic vegetable organism proved to be capable of causing disease in an animal.
Boehm, in 1838, observed minute organisms in the stools of cholera patients and conjectured that they might have a causal connection with the disease. Dubini of Milan in 1838 discovered the Ankylostoma duodenale which later was further described by Omodei in 1843 and shown to be the cause of Egyptian chlorosis by Griesinger (1851). The fungous nature of favus, a scalp disease, was recognized by Schönlein in 1839, and the organism was afterward called “Achorion schoenleinii.” Berg, in 1839–41, showed that thrush is likewise due to a fungus, “Oidium albicans.”
These discoveries led Henle, in 1840, to publish a work in which he maintained that all contagious diseases must be due to living organisms, and to propound certain postulates (afterward restated by Koch and now known as “Koch’s postulates” p. 233) which must be demonstrated before one can be sure that a given organism is the specific cause of a given disease. The methods then in vogue and the instruments of that period did not enable Henle to prove his claims, but he must be given the credit for establishing the “contagium vivum” theory on a good basis and pointing the way for men better equipped to prove its soundness in after years.
In 1842–43 Gruby showed that Herpes tonsurans, a form of ringworm, is due to the fungus Trichophyton tonsurans. Klencke, in 1843, produced generalized tuberculosis in a rabbit by injecting tuberculous material into a vein in the ear, but did not carry his researches further. In 1843, Doctor Oliver Wendell Holmes wrote a paper in which he contended that puerperal fever was contagious. Liebert identified the Peronospora infestans as the cause of one type of potato rot in 1845. The skin disease Pityriasis (tinea) versicolor was shown to be due to the Microsporon furfur by Eichstedt in 1846. In 1847 Semmelweiss of Vienna recommended disinfection of the hands with chloride of lime by obstetricians because he believed with Holmes in the transmissibility of puerperal fever through poisons carried in this way from the dissecting room but his theories were ridiculed.
Pollender, in 1849, and Davaine and Rayer, in 1850, independently observed small rod-like bodies in the blood of sheep and cattle which had died of splenic fever (anthrax). That Egyptian chlorosis, afterward identified with Old World “hookworm disease,” is caused by the Ankylostoma duodenale was shown by Greisinger in 1851. In the same year the Schistosomum hematobium was shown to be the cause of the “Bilharzia disease” by Bilharz. Küchenmeister discovered the tapeworm, Tænia solium, in 1852, Cohn, an infectious disease of flies due to a parasitic fungus (Empusa muscæ) in 1855, and Zenker showed the connection between trichinosis of pork (“measly pork”) and human trichinosis (1860) as indicated above. The organisms just mentioned are, of course, not bacteria, but these discoveries proved conclusively that living things of one kind or another, some large, most of them microscopic, could cause disease in other organisms and stimulated the search for other “living contagiums.” In 1863 Davaine, already mentioned, showed that anthrax could be transmitted from animal to animal by inoculation of blood, but only if the blood contained the minute rods which he believed to be the cause. Davaine later abandoned this belief because he transmitted the disease with old blood in which he could find no rods. It is now known that this was because the bacilli were in the “spore” form which Davaine did not recognize. He thus missed the definite proof of the bacterial nature of anthrax because he was not familiar with the life history of the organism which was worked out by Koch thirteen years later. In 1865 Villemin repeatedly caused tuberculosis in rabbits by subcutaneous injection of tuberculous material and showed that this disease must be infectious also. In the same year Lord Lister introduced antiseptic methods in surgery. He believed that wound infections were due to microörganisms getting in from the air, the surgeon’s fingers, etc., and without proving this, he used carbolic acid to kill these germs and prevent the infection. His pioneer experiments made modern surgery possible. In this year also, Pasteur was sent to investigate a disease, Pebrine, which was destroying the silkworms in Southern France. He showed the cause to be a protozoan which had been seen previously by Cornalia and described by Nägeli under the name Nosema bombycis and devised preventive measures. This was the first infectious disease shown to be due to a protozoan. In 1866 Rindfleisch observed small pin-point-like bodies in the heart muscle of persons who had died of wound infection. Klebs, in 1870–71, published descriptions and names of organisms he had found in the material from similar wounds, though he did not establish their causal relation. Bollinger, in 1872, discovered the spores of anthrax and explained the persistence of the disease in certain districts as due to the resistant spores. In 1873 Obermeier observed in the blood of patients suffering from recurrent fever long, flexible spiral organisms which have been named Spirochæta obermeieri. Lösch ascribed tropical dysentery to an ameba, named by him Amœba coli, in 1875. Finally, Koch, in 1876, isolated the anthrax bacillus, worked out the life history of the organism and reproduced the disease by the injection of pure cultures and recovered the organism from the inoculated animals, thus establishing beyond reasonable doubt its causal relationship to the disease. This was the first instance of a bacterium proved to be the cause of a disease in animals. Pasteur, working on the disease at the same time, confirmed all of Koch’s findings, though his results were published the next year, 1877. Bollinger determined that the Actinomyces bovis (Streptothrix bovis) is the cause of actinomycosis in cattle in 1877. Woronin in the same year discovered a protozoan (Plasmodiophora brassicæ) to be the cause of a disease in cabbage, the first proved instance of a unicellular animal causing a disease in a plant. In 1878 Koch published his researches on wound infection in which he showed beyond question that microörganisms are the cause of this condition, though Pasteur in 1837, had suggested the same thing and Lister had acted on the theory in preventing infection.
These discoveries, especially those of Koch, immediately attracted world-wide attention and stimulated a host of workers, so that within the next ten years most of the bacteria which produce disease in men and animals were isolated and described. It is well to remember that the first specific disease of man proved to be caused by a bacterium was tuberculosis, by Koch in 1882.
Progress was greatly assisted by the introduction of anilin dyes as suitable stains for organisms by Weigert in 1877, by Koch’s application of special technic and gelatin cultures for isolation and study, 1881, and the great improvements in the microscope by Prof. Abbé, of Jena.
Laveran’s discovery of the malarial parasite in 1880 turned attention to protozoa as the causes of disease and led to the discovery of the various piroplasmoses and trypanosomiases in man and the lower animals.
Pasteur’s protective inoculations in chicken cholera and anthrax directed attention to the possibility of using bacteria or their products as a specific protective or curative means against particular diseases. This finally led to the discovery of diphtheria antitoxin by Behring, and independently by Roux, in 1890, a discovery which opened up the wide field of immunity which is so persistently cultivated at the present time.
While the causation of disease by bacteria has probably attracted most attention, especially in the popular mind, it should not be forgotten that this is but one of the numerous ways in which these organisms manifest their activities, and in a sense it is one of their least-important ways, since other kinds are essential in many industries (dairying, agriculture) and processes (sewage purification) and are even indispensable for the very existence of all green plants and hence of animals, including man himself.
The idea that there is a certain resemblance between some infectious diseases and the processes of putrefaction and fermentation seems to have originated during the discussion on spontaneous generation and the “contagium vivum” theory which followed Leeuwenhoek’s discoveries. Plenciz (1762) appears to have first formulated this belief in writing. He considered putrefaction to be due to the “animalcules” and said that it occurred only when there was a coat of organisms on the material and only when they increased and multiplied. Spallanzani’s experiments tended to support this view since his infusions did not “spoil” when boiled and sealed. Appert’s practical application of this idea has been mentioned.
Thaer, in his Principles of Rational Agriculture, published in the first quarter of the nineteenth century, expressed the belief that the “blue milk fermentation” was probably due to a kind of fungus that gets in from the air, and stated that he had prevented it by treating the milk cellars and vessels, with sulphur fumes or with “oxygenated hydrochloric acid” (hypochlorous acid).
In 1836 Chevreuil and Pasteur showed that putrefaction did not occur in meat protected from contamination. In 1837 Caignard-Latour, in France, and Schwann, in Germany, independently showed that alcoholic fermentation in beer and wine is due to the growth of a microscopic plant, the yeast, in the fermenting wort. C. J. Fuchs described the organism which is commonly called the “blue milk bacillus” in 1841 and conjectured that the souring of milk was probably bacterial in origin. It remained for Pasteur to prove this in 1857. During the following six or seven years Pasteur also proved that acetic acid fermentation, as in vinegar making, butyric acid fermentation (odor of rancid butter and old cheese) and the ammoniacal fermentation of urea, so noticeable around stables, were each due to different species of bacteria. Pasteur also, during the progress of this work, discovered the class of organisms which can grow in the absence of free oxygen—the anaërobic bacteria. There is no question that Pasteur from 1857 on did more to lay the foundations of the science of bacteriology than any other one man. Influenced by Pasteur’s work von Hesseling, in 1866, stated his belief that the process of cheese ripening, like the souring of milk, was associated with the growth of fungi, and Martin also, in 1867, stated that cheese ripening was a process which was akin to alcoholic, lactic and butyric fermentations. Kette, in 1869, asserted the probability of Pasteur’s researches furnishing a scientific basis for many processes of change in the soil. In 1873 Schlösing and Müntz showed that nitrification must be due to the action of microörganisms, though the discovery of the particular ones remained for Winogradsky in 1889. Thus the belief that fermentation and putrefaction are due to microörganisms was as well established by the early eighties of the last century as that similar organisms are the causes of infectious diseases.
An important part of the scientific knowledge of living organisms is dependent on a study of their forms and relationships. As has been stated, Leeuwenhoek considered bacteria to be “animalcules” because they showed independent movement. But little attention was paid to the natural history of these animalcules for nearly a hundred years after Leeuwenhoek. During the last quarter of the eighteenth century, however, workers busied themselves chiefly with the discovery and description of new forms. Among these students were Baron Gleichen, Jablot, Lesser, Reaumur, Hill and others. Müller, of Copenhagen, in 1786 published the first attempt at classification, a most important step in the study of these organisms. Müller introduced the terms Monas, Proteus and Vibrio, which are still in use. Ehrenberg, in his work on Infusoria, or the organisms found in infusions, published in 1838, introduced many generic names in use at present, but still classed the bacteria with protozoa. Joseph Leidy, the American naturalist, considered that the “vibrios” of previous writers were plants and not “animalcules.” He seems to have been the first to have made this distinction (1849). Perty (1852) recognized the presence of spores in some of his organisms. Ferdinand Cohn (1854) classed the bacteria among plants. Nägeli (1857) proposed the name “Schizomycetes” or “fission fungi,” which is still retained for the entire class of bacteria. Cohn in the years 1872–1875 established classification on a modern basis and added greatly to the knowledge of morphology and natural history of bacteria. He described spore formation and the development of spores into active bacteria, and showed the close relationships as well as differences between the bacteria and the lower algæ. Robert Koch was a pupil of Cohn.
An examination of the accompanying chronological table will show how the investigations and discoveries in connection with “spontaneous generation,” the “contagium vivum” theory and putrefaction and fermentation must have been mutually suggestive:
Bacteria are considered to belong to the plant kingdom not because of any one character they possess, but because they most nearly resemble organisms which are generally recognized as plants. While it is not difficult to distinguish between the higher plants and higher animals, it becomes almost, if not quite, impossible to separate the lowest, forms of life. It is only by the method of resemblances above mentioned that a decision is finally reached. It has even been proposed to make a third class of organisms neither plants nor animals but midway between in which the bacteria are included, but such a classification has not as yet been adopted.
In many respects the bacteria are most nearly related to the lowest algæ, since both are unicellular organisms, both reproduce by transverse division and the forms of the cell are strikingly similar. The bacteria differ in one important respect, that is, they do not contain chlorophyl, the green coloring matter which enables all plants possessing it to absorb and break up carbon dioxide in the light, and hence belong among the fungi. Bacteria average much smaller than even the smallest algæ.
Bacteria are closely connected with the fission yeasts and the yeasts and torulæ. All are unicellular and without chlorophyl. The bacteria, as has been stated, reproduce by division but the others characteristically by budding or gemmation, though the fission yeasts also by division.
There is a certain resemblance to the molds in their absence of chlorophyl. But the molds grow as branching threads and also have special fruiting organs for producing spores as a means of reproduction, neither of which characteristics is found among the true bacteria. The higher thread bacteria do show true branching and rudimentary fruiting bodies (Streptothrix) and appear to be a link connecting the true bacteria and the molds.





Further the chemical composition of bacteria is more like that of other fungous plants than of any of the forms classed as animals.


The food of bacteria is always taken up in solution by diffusion through the outer covering of the cell as it is in all plants. Plant cells never surround and engulf particles of solid food and digest them within the cell as many single-celled animals do, and as the leukocytes and similar ameboid cells in practically all multicelled animals do.2

One of the most marked differences between animals and plants is with respect to their energy relationships. Plants are characteristically storers of energy while animals are liberators of it. Some bacteria which have the power of swimming in a liquid certainly liberate relatively large amounts of energy, and in the changes which bacteria bring about in the material which they use as food considerable heat is evolved (“heating” of manure, etc.). Nevertheless the evidence is good that the bacteria as a class store much more of the energy contained in the substances actually taken into the body cell as food than is liberated in any form.
Bacteria do show some resemblance to the protozoa, or single-celled animal forms, in that the individuals of each group consist of one cell only and some bacteria have the power of independent motion from place to place in a liquid as most “infusoria” do, but here the resemblance ceases.
Bacteria are among the smallest of organisms, so small that it requires the highest powers of the microscope for their successful study, and the use of a special unit for their measurement. This unit is the one-thousandth part of a millimeter and is called the micro-millimeter or micron. Its symbol is the Greek letter mu (µ).
The size varies widely among different kinds but is fairly constant in the same kind. The smallest described form is said to be only 0.18µ long by 0.06µ thick and is just visible with the highest power of the microscope, though it is possible and even probable that there are forms still smaller which cannot be seen. Some large rare forms may measure 40µ in length, but the vast majority are from 1µ to 4µ or 5µ long, and from one-third to one-half as wide.
From the above description a bacterium might be said to be a microscopic, unicellular plant, without chlorophyl, which reproduces by dividing transversely.
The essential structures which may by appropriate means be distinguished in the bacterial cell are cell wall and cell contents, technically termed protoplasm, cytoplasm. The cell wall is not so dense, relatively, as that of green plants, but is thicker than the outer covering of protozoa. It is very similar to the cell wall of other lower fungi. Diffusion takes place readily through it with very little selective action on substances absorbed as judged by the comparative composition of bacteria and their surrounding medium.
Cytoplasm.—The cytoplasm according to Bütschli and others is somewhat different and slightly denser in its outer portion next to the cell wall. This layer is designated the ectoplasm, as distinguished from the remainder of the cell contents, the endoplasm. When bacteria are suddenly transferred from a given medium into one of decidedly greater density, there sometimes results a contraction of the endoplasm, due to the rapid diffusion of water. This phenomenon is designated plasmolysis (Fig. 17), and is similar to what occurs in the cells of higher plants when subjected to the same treatment. This is one of the methods which may be used to show the different parts of the cell just described.
If bacteria are suddenly transferred from a relatively dense medium to one which is of decidedly less density, it occasionally happens that water diffuses into the cell and swells up the endoplasm so much more rapidly than the cell wall that the latter ruptures and some of the endoplasm exudes in the form of droplets on the surface of the cell wall. This phenomenon is called plasmoptysis. Students will seldom observe the distinction between cell wall and cell contents, except that in examining living bacteria the outer portion appears more highly refractive. This is chiefly due to the presence of a cell wall, but is not a proof of its existence.


Nucleus.—Douglas and Distaso3 summarize the various opinions with regard to the nucleus in bacteria as follows:
1. Those who do not admit, the presence of a nucleus or of anything equivalent to it. (Fischer, Migula, Massart).
2. Those who consider that the entire bacterial cell is the equivalent of a nucleus and contains no protoplasm. (Ruzicka).
3. Those who admit the presence of nuclein but say that this is not morphologically differentiated from the protoplasm as a nucleus. (Weigert).
4. Those who consider the bacterial protoplasm to consist of a central endoplasm throughout which the nuclein is diffused and an external layer of ectoplasm next to the cell wall. (Bütschli, Zettnow).
5. Those who say that the bacterial cell contains a distinct nucleus, at least in most instances. These authors base their claims on staining with a Giemsa stain. (Feinberg, Ziemann, Neuvel, Dobell, Douglass and Distaso).
That nucleoproteins are present in the bacterial cell in relatively large amounts is well established. Also that there are other proteins and that the protoplasm is not all nuclein.
Some workers as noted above have been able to demonstrate collections of nuclein by staining, especially in very young cells. In older cells this material is in most instances diffused throughout the protoplasm and can not be so differentiated.
The following statement probably represents the generally accepted view at the present time:
A nucleus as such is not present in bacterial cells, except in a few large rare forms and in very young cells. Nuclein, the characteristic chemical substance in nuclei, which when aggregated forms the nucleus, is scattered throughout the cell contents and thus intimately mingled with the protoplasm, and cannot be differentiated by staining as in most cells.
The close association of nuclein and protoplasm may explain the rapid rate of division of bacteria (Chapter VIII, p. 91).
The chemical composition of the bacterial cell is discussed in Chapter VII.
In addition to the essential parts just described the bacterial cell may show some of the following accidental structures: vacuoles, capsules, metachromatic granules, flagella, spores.
Vacuoles.—Vacuoles appear as clear spaces in the protoplasm when the organism is examined in the living condition or when stained very slightly (Fig. 18). During life these are filled with liquid or gaseous material which is sometimes waste, sometimes reserve food, sometimes digestive fluids. Students are apt to confuse vacuoles with spores (p. 47). Staining is the surest way to differentiate (Chapter XIX, p. 209). If vacuoles have any special function, it is an unimportant one.


Capsule.—The capsule is a second covering outside the cell wall and probably developed from it (Fig. 19). It is usually gelatinous, so that bacteria which form capsules frequently stick together when growing in a fluid, so that the whole mass has a jelly-like consistency. The term zoöglœa was formerly applied to such masses, but it is a poor term and misleading (zoön = an animal) and should be dropped. The masses of jelly-like material frequently found on decaying wood, especially in rainy weather, are in some cases masses of capsule-forming bacteria, though a part of the jelly is a product of bacterial activity, a gum-like substance which lies among the capsulated organisms. When these masses dry out, they become tough and leathery, but it is not to be presumed that capsules are of this consistency. On the contrary, they are soft and delicate, though they certainly serve as an additional protection to the organism, doubtless more by selective absorption than mechanically. Certain bacteria which cause disease form capsules in the blood of those animals which they kill and not in the blood of those in which they have no effect (Bacterium anthracis in guinea pig’s blood and in rat’s blood). The presence of capsules around an organism can be proved only by staining the capsule. Many bacteria when stained in albuminous fluids show a clear space around them which appears like a capsule. It is due to the contraction of the fluid away from the organism during drying.
Metachromatic Granules.—The term “metachromatic” is applied to granules which in stained preparations take a color different from the protoplasm as a whole (Fig. 20). They vary widely in chemical composition. Some of them are glycogen, some fat droplets. Others are so-called “granulose” closely related to starch but probably not true starch. Others are probably nuclein. Of many the chemical composition is unknown. They are called “Babes-Ernst corpuscles” in certain bacteria (typhoid bacillus). Since they frequently occur in the ends of cells the term “polar granules” is also applied. Their presence is of value in the recognition of but few bacteria (“Neisser granules” in diphtheria).
Flagellum.—A flagellum is a very minute thread-like process growing out from the cell wall, probably filled with a strand of protoplasm. The vibrations of the flagella move the organism through the liquid medium. Bacteria which are thus capable of independent movement are spoken of as “motile bacteria.” The actual rate of movement is very slight, though in proportion to the size of the organism it may be considered rapid. Thus Alfred Fischer determined that some organisms have a speed for short periods of about 40 cm. per hour. This is equivalent to a man moving more than 200 miles in the same time.
It is obvious that bacteria which can move about in a liquid have an advantage in obtaining food, since they do not need to wait for it to be brought to them. This advantage is probably slight.


An organism may have only one flagellum at the end. It is then said to be monotrichic (Fig. 21) (μόνος = alone, single; τριχος = hair). This is most commonly at the front end, so that the bacterium is drawn through the liquid by its motion. Rarely it is at the rear end. Other bacteria may possess a bundle of flagella at one end and are called lophotrichic (Fig. 22) (λοφος = tuft). Sometimes at approaching division the flagella may be at both ends and are then amphitrichic (Fig. 23) (αμφι = both). It is probable that this condition does not persist long, but represents the development of flagella at one end of each of a pair resulting from division of an organism which has flagella at one end only. In many bacteria the flagella arise from all parts of the surface of the cell. Such bacteria are peritrichic (Fig. 24) (περι = around). The position and even the number of the flagella are very constant for each kind and are of decided value in identification.


Flagella are too fine and delicate to be seen on the living organism, or even on bacteria which have been colored by the ordinary stains. They are rendered visible only by certain methods which cause a precipitate on both bacteria and flagella which are thereby made thick enough to be seen (Chapter XIX, p. 210). The movement of liquid around a bacterium caused by vibrations of flagella can sometimes be observed with large forms and the use of “dark-field” illumination.
Flagella are very delicate and easily broken off from the cell body. Slight changes in the density or reaction of the medium frequently cause this breaking off, so that preparations made from actively motile bacteria frequently show no flagella. For this reason and also on account of their fineness the demonstration of flagella is not easy, and it is not safe to say that a non-motile bacterium has no flagella except after very careful study.
The motion of bacteria is characteristic and a little practice in observing will enable the student to recognize it and distinguish between motility and “Brownian” or molecular motion. Dead and non-motile bacteria show the latter. In fact, any finely divided particles suspended in a liquid which is not too viscous and in which the particles are not soluble show Brownian motion or “pedesis.” This latter is a dancing motion of the particle within a very small area and without change of place, while motile bacteria move from place to place or even out of the field of the microscope with greater or less speed. There is a marked difference in the character of the motion of different kinds of bacteria. Some rotate around the long axis when moving, others vibrate from side to side.
Among the higher thread bacteria there are some which show motility without possessing flagella. Just how they move is little understood.
Spores.—Under certain conditions some bacterial cells undergo transformations which result in the formation of so-called spores. If the process is followed under the microscope, the changes observed are approximately these: A very minute point appears in the protoplasm which seems to act somewhat like the centrosome of higher cells as a “center of attraction” so that the protoplasm gradually collects around it. The spot disappears or is enclosed in the collected protoplasm. This has evidently become denser as it is more highly refractive than before. In time all or nearly all of the protoplasm is collected. A new cell wall is developed around it which is thicker than the cell wall of the bacterium. This thickened cell wall is called the “spore capsule.” Gradually the remnants of the former cell contents and the old cell wall disappear or dissolve and the spore becomes “free” (Fig. 25).

If the spore is placed in favorable conditions the protoplasm absorbs water, swells, the capsule bursts at some point, a cell wall is formed and the bacterium grows to normal size and divides, that is, it is an active growing cell again. This process is called “germination” of the spore. The point at which the spore capsule bursts to permit the new cell to emerge is characteristic for each kind of bacterium. It may be at the end when the germination is said to be polar (Fig. 26). It may be from the middle of one side which gives equatorial germination (Fig. 27). Rarely it is diagonally from a point between the equator and the pole, which type may be styled oblique germination. In one or two instances the entire spore swells up, lengthens and becomes a rod without any special germination unless this type might be designated bi-polar.




Spores are most commonly oval or elliptical in shape, though sometimes spherical. A spore may be formed in the middle of the organism without (Fig. 28) or with (Fig. 29) a change in size of the cell around it. If the diameter through the cell is increased, then the cell with the contained spore becomes spindle-shaped. Such a cell is termed a “clostridium.” Sometimes the spore develops in the end of the cell either without (Fig. 30) or with enlarging it (Fig. 31). In a few forms the spore is placed at the end of the rod and shows a marked enlargement. This is spoken of as the “plectridium” or more commonly the “drumstick spore” (Fig. 32). The position and shape of the spore are constant for each kind of bacteria. In one or two instances only, two spores have been observed in a single organism.



The fact that the protoplasm is denser and the spore capsule thicker (the percentage of water in each is decidedly less than in the growing cell) gives the spore the property of much greater resistance to all destructive agencies than the active bacterium has. For example, all actively growing cells are destroyed by boiling in a very few minutes, while some spores require several hours’ boiling. The same relation holds with regard to drying, the action of chemicals, light, etc. That the coagulation temperature of a protein varies inversely with the amount of water, it contains, is shown by the following table from Frost and McCampbell, “General Bacteriology”:
| Egg albumin | plus | 50 per cent. water | coagulates at | 56° |
| Egg albumin | plus | 25 per cent. water | coagulates at | 74–80° |
| Egg albumin | plus | 18 per cent. water | coagulates at | 88–90° |
| Egg albumin | plus | 6 per cent. water | coagulates at | 145° |
| Egg albumin | dry | water | coagulates at | 160–170° |
This resistance explains why it happens that food materials boiled and sealed in cans to prevent the entrance of organisms sometimes spoil. The spores have not been killed by the boiling. It explains also in part the persistence of some diseases like anthrax and black leg in pastures for years. From the above description it follows that the spore is to be considered as a condensation of the bacterial protoplasm surrounded by an especially thick cell wall. Its function is the preservation of the organism under adverse conditions. It corresponds most closely to the encystment of certain protozoa—the ameba for example. Possibly the spore represents a very rudimentary beginning of a reproductive function such as is gradually evolved in the higher thread bacteria, the fission yeasts, the yeasts, the molds, etc. Its characteristics are so markedly different, however, that the function of preservation is certainly the main one.
It must not be supposed that spores are formed under adverse conditions only, because bacteria showing vigorous growth frequently form spores rapidly. Special conditions are necessary for their formation just as they are for the growth and other functions of bacteria (Chapters VI and VII).
Though there is apparently a wide variation in the shapes of different bacterial cells, these may all be reduced to three typical cell forms. These are: first and simplest, the round or spherical, typified by a ball and called the coccus form, or coccus, plural cocci4 (Fig. 33). The coccus may be large, that is, from 1.5µ to 2µ in diameter. The term macrococcus is sometimes applied to these large cocci. If the coccus is less than 1µ in diameter, it is sometimes spoken of as a micrococcus; in fact, this term is very commonly applied to any coccus. When cocci are growing together, many of the cells do not appear as true spheres but are more or less distorted from pressure of their neighbors or from failure to grow to full size after recent division. Most cocci divide into hemispheres and then each half grows to full size. A few cocci elongate before division and then appear oval or elliptical.
The second cell form is that of a cylinder or rod typified by a section of a lead-pencil. The name bacillus, plural bacilli, is applied to this type (Fig. 34). The bacillus may be short (Fig. 35), 1µ or less in length, or long, up to 40µ in rare cases. Most bacilli are from 2µ to 5µ or 6µ long. The ends of the rod are usually rounded, occasionally square and very rarely pointed. It is evident that a very short rod with rounded ends approaches a coccus in form and it is not always easy to differentiate in such cases. Most bacilli are straight, but some are slightly curved (Fig. 36).
The third cell form is the spiral, typified by a section of a cork-screw and named spirillum, plural spirilla (Fig. 37). A very short spiral consisting of only a portion of a turn is sometimes called vibrio (Fig. 38). Vibrios when seen under the microscope look like short curved rods. The distinction between the two can be made only by examining the organism alive and moving in a liquid. The vibrio shows a characteristic spiral twisting motion. Very long, flexible spirals are usually named spirochetes (Fig. 39). The spirochetes are motile but flagella have not been shown to be present.




Besides the three typical cell forms bacteria frequently show very great irregularities in shape. They may be pointed, bulged, club-shaped or even slightly branched. These peculiar and bizarre forms practically always occur when some of the necessary conditions for normal growth, discussed in Chapters VI and VII, are not fulfilled. They are best regarded as involution or degeneration forms for this reason (Fig. 40). In a very few cases it is not possible to obtain the organism without these forms (the diphtheria group). It is probable that these cell forms are normal in such cases, or else conditions suitable for the normal growth have not been obtained.



It has been stated that bacteria reproduce by transverse division, that is, division across the long axis. Following repeated divisions the new cells may or may not remain attached. In the latter case the bacteria occur as separate isolated individuals. In the former, arrangements characteristic of the particular organism almost invariably result. These arrangements are best described as cell groupings or growth forms.


In the case of spiral forms it is obvious that there is only one possible grouping, that is, in chains of two or more individuals adherent end to end. A chain of two spirilla might be called a diplospirillum (διπλός = double); of three or more, a streptospirillum (στρεπτός = necklace, chain) (Fig. 41). These terms are rarely used, since spirilla do not ordinarily remain attached. Likewise the bacillus can grow only in chains of two or more, and the terms diplobacillus (Fig. 42), bacilli in groups of two, and streptobacillus (Fig. 43), bacilli in chains are frequently used. Still the terms thread, filament, or chain are more common for streptobacillus.




Since the coccus is spherical, transverse division may occur in any direction, though in three planes only at right angles to each other. Division might occur in one plane only as in spirilla and bacilli, or in two planes only or in all three planes. As a matter of fact these three methods of division are found among the cocci, but only one method for each particular kind of coccus. As a result there may be a variety of cell groupings among the cocci. When division occurs in one plane only, the possible groupings are the same as among the spirilla or bacilli. The cocci may occur in groups of two—diplococcus grouping (Fig. 44), or in chains—streptococcus grouping (Figs. 45 and 46). When the grouping is in diplococci, the individual cocci most commonly appear as hemispheres with the plane surfaces apposed (Fig. 44). Sometimes they appear as spheres and occasionally are even somewhat elongated. The individuals in a streptococcus grouping are most commonly elongated, either in the same direction as the length of the chain, or at right angles to it. The latter appearance is probably due to failure to enlarge completely after division. Streptococci frequently appear as chains of diplococci, that is, the pair resulting from the division of a single coccus remain a little closer to each other than to neighboring cells, as a close inspection of Fig. 45 will show.
If division occurs in two planes only, there may result the above groupings and several others in addition. The four cocci which result from a single division may remain together, giving the tetracoccus or tetrad grouping. Very rarely all the cocci divide evenly and the result is a regular rectangular flat mass of cells, the total number of which is a multiple of four. The term merismopedia (from a genus of algæ which grows the same way) is applied to such a grouping. If the cells within a group after a few divisions do not reproduce so rapidly (lack of food), as usually happens, the number of cells becomes uneven or at least not necessarily a multiple of four and the resultant flat mass has an irregular, uneven outline. This grouping is termed staphylococcus (σταφυλος = a bunch of grapes) (Fig. 47). It is the most common grouping among the cocci.
When division occurs in all three planes, there is in addition to all the groupings possible to one- and two-plane division a third grouping in which the cells are in solid packets, multiples of eight. The name sarcina is applied to this growth form (Fig. 48). The individual cells in a sarcina packet never show the typical coccus form so long as they remain together, but are always flattened on two or more sides.
The above descriptions indicate how the method of division may be determined. If in examining a preparation the sarcina grouping appears, that shows three-plane division. If there are no sarcina, but tetrads or staphylococci (rarely merismopedia), then the division is in two planes. If none of the foregoing is observed but only diplo- or streptococci, these indicate one-plane division only. Cocci show their characteristic groupings only when grown in a liquid medium, and such should always be used before deciding on the plane of division.


As the above description shows, these terms which are properly adjectives describing the cell grouping, are quite generally used as nouns. Thus the terms a diplococcus, a tetrad, a streptococcus, etc., are common, meaning a bacterium of the cell form and cell grouping indicated.
| Cell Form. | Cell Grouping. |
|---|---|
| coccus—round or spherical. |
|
| bacillus—rod-shaped or cylindrical. |
|
| spirillum—spiral-shaped. |
|
The arrangement of living organisms in groups according to their resemblances and the adoption of fixed names is of the greatest advantage in their scientific study. For animal forms and for the higher plants this classification is gradually becoming standardized through the International Congress of Zoölogists and of Botanists respectively. Unfortunately, the naming of the bacteria has not as yet been taken up by the latter body, though announced as one of the subjects for the Congress of 1916 (postponed on account of the war). Hence there is at present no system which can be regarded as either fixed or official.




Since Müller’s first classification of “animalcules” in 1786 numerous attempts have been made to solve the problem. Only those beginning with Ferdinand Cohn (1872–75) are of any real value. As long as bacteria are regarded as plants it appears that the logical method is to follow the well-established botanical principles in any system for naming them. Botanists depend on morphological features almost entirely in making their distinctions. The preceding chapters have shown that the minute plants which are discussed have very few such features. They are, to recapitulate, cell wall, protoplasm, vacuoles, metachromatic granules, capsules, flagella, spores, cell forms and cell groupings. Most bacteria show not more than three or four of these features, so that it is impossible by the aid of morphology alone to distinguish from each other the large number of different kinds which certainly exist. In the various systems which are conceded to be the best these characteristics do serve to classify them down to genera, leaving the “species” to be determined from their physiological activities. One of these systems was adopted by the laboratory section of the American Public Health Association and by the Society of American Bacteriologists and was practically the standard in this country until superseded by the Society’s own classification. It is that of the German Bacteriologist Migula and is given below for comparison. Since practically the entire discussion in this book is concerned with the first three families the generic characteristics in these only will be given. The full classification as well as a thorough discussion of this subject is given in Lafar’s Handbuch, whence the following is adopted:







Cells without nuclei, free from sulphur granules and from bacteriopurpurin (p. 112); colorless, or slightly colored.
| 1. Family: Coccaceæ (Zopf) Migula, all cocci. | |||
|---|---|---|---|
| Non-flagellated, Non-motile | |||
| Flagellated, motile |
|
||
| 2. Family: Bacteriaceæ Migula, all bacilli. | |||
| 3. Family: Spirillaceæ Migula, all spirilla. | |||
| Cells stiff | |||
| Cell flexible |
|
||
| 4. Family: Chlamydobacteriaceæ. | |||
| Cells cylindrical in long threads and surrounded by a sheath. Reproduction also by gonidia formed from an entire cell. | |||
Cells without a nucleus, but containing sulphur granules, may be colorless or contain bacteriopurpurin and be colored reddish or violet.
This has five subfamilies and twelve genera, most of which are due to the Russian bacteriologist Winogradsky who did more work than anyone else with the sulphur bacteria.
The Committee on Classification of the Society of American Bacteriologists at the meeting held in December, 1919, submitted its final report. This report has not been formally adopted as a whole, but in all probability will be substantially as outlined below. This outline does not attempt to give the detailed characterizations of the different groups as defined by the committee, but does show the names to be applied to the commoner organisms. These organisms are included in the 4th and 5th orders. Details of the first three orders have not been worked out. They are listed merely for completeness.
Unicellular, chlorophyl-free plants, reproducing by transverse division (some forms by gonidia also).
As compared with Migula’s classification it is to be noted that there are 38 genera listed by the Committee instead of 13 in the same general groups.
The following list of Genera conservanda submitted by the Committee was formally adopted by the Society and these are therefore its official names for the organisms included in these genera.
It is greatly to be desired that the Society’s Classification when finally completed shall become the standard in the United States at least.
Such names as have been adopted by the Society are used throughout this work.
The Committee also submitted the following artificial key for determining the genera in the two orders ACTINOMYCETALES AND EUBACTERIALES:
Bacteria are probably the most widely distributed of living organisms. They are found practically everywhere on the surface of the earth. Likewise in all surface waters, in streams, lakes and the sea. They occur in the air immediately above the surface, since they are carried up mechanically by air currents. They cannot fly of themselves. There is no reason to believe that any increase in numbers occurs to an appreciable extent in the air. The upper air, for example, on high mountains, is nearly free from them. So also is the air over midocean, and in high latitudes. As a rule, the greater the amount of dust in the air, the more numerous are the bacteria. Hence they are found more abundantly in the air in cities and towns than in the open country. The soil is especially rich in numbers in the upper few feet, but they diminish rapidly below and almost disappear at depths of about six feet unless the soil is very porous and open, when they may be carried farther down. Hence the waters from deep wells and springs are usually devoid of these organisms. In the sea they occur at all levels and have been found in bottom ooze dredged from depths of several miles. It is perhaps needless to add that they are found on the bodies and in the alimentary tract of human beings and animals; on clothing, utensils; in dwellings, stables, outhouses, etc. From one-fourth to one-half of the dry weight of the feces of animals and men is due to the bacteria present. The urine is practically free from them in health.
While bacteria are thus found nearly everywhere, it is an entirely mistaken idea to suppose that all are injurious to man. As a matter of fact, those which are dangerous are relatively few and are for the most part found only in close association with man. Most bacteria are harmless and the vast majority are beneficial or even essential to man’s existence on the earth. These facts must be constantly borne in mind, and it is hoped that the pages which follow will make them clear.
In order that any organism may thrive there are a number of general environmental conditions which must be fulfilled. These conditions vary more or less for each kind of organism. Bacteria are no exception to this general rule. These conditions may be conveniently considered under the general heads of moisture; temperature; light; oxygen supply; osmotic pressure; action of electricity; of Röntgen and radium rays; pressure; mechanical vibration; and chemical environment, including the reaction of the medium, the effect of injurious chemicals, and especially the food requirements of bacteria. For each of these conditions there is a maximum, meaning the greatest amount of the given condition which the organism can withstand, a minimum, or the least amount, and an optimum or that amount which is most favorable for development. Further, there might be distinguished a maximum for mere existence and a lower maximum for development; also a minimum for mere existence and a higher minimum for development. These maxima, minima, and optima for bacteria have been determined with exactness for only a very few of the general conditions and for comparatively few kinds.
The maximum moisture is absolutely pure water, and no organism can thrive in this alone owing to the factor of too low osmotic pressure and to the further factor of absence of food material. There are many bacteria which thrive in water containing only traces of mineral salts and a large class whose natural habitat is surface water. These “water bacteria” are of great benefit in the purification of streams. They are as a class harmless to men and animals. Some of the disease-producing bacteria like Bacterium typhosum (of typhoid fever) and Vibrio choleræ (of Asiatic cholera) were undoubtedly originally water bacteria, and it is rather striking that in these diseases conditions are induced in the intestine (diarrheas) which simulate the original watery environment. The minimum moisture condition is absolute dryness, and no organism can even exist, not to say develop, in such a condition since water is an essential constituent of living matter. Some bacteria and especially most spores may live when dried in the air or by artificial means for months and even years, while some are destroyed in a few hours or days when dried (typhoid, cholera, etc.). The optimum amount of moisture has not been determined with any great accuracy and certainly a rather wide range in percentage of water is permissible with many, though a liquid medium is usually most favorable for artificial growth. The “water bacteria” have been mentioned. In the soil a water content of 5 to 15 per cent. seems to be most suitable for many of the organisms which aid in plant growth. In animals and man the organisms infecting the intestinal tract prefer a high percentage of moisture as a rule, especially those causing disease here. Those found on the surface of the body (pus cocci) need a less amount of water, while those invading the tissues (tuberculosis, black-leg, etc.) seem to be intermediate in this respect. In artificial culture media a water content of less than 30 per cent. inhibits the growth of most bacteria.
As a general rule those bacteria which require the largest percentage of water are most susceptible to its loss and are most readily killed by drying. The typhoid and cholera organisms die in a few hours when dried, while pus cocci and tubercle bacilli live much longer.
The temperature conditions for bacterial existence and growth have been determined more accurately than any of the other general conditions. The maximum for existence must be placed at or near 100° since it is known that all bacteria including spores may be killed by boiling in time. Nevertheless, certain forms have been reported as thriving in hot springs where the water temperature was 93°. This is the highest known temperature for development. The minimum for existence lies at or near the absolute zero (-273°) since certain organisms have been subjected to the temperature produced by the sudden evaporation of liquid hydrogen (-256° to -265°) and have remained alive. Whether they could withstand such temperatures indefinitely is not known. The minimum for development is near the freezing-point of water, since reproduction by division has been observed in the water from melting sea-ice at a temperature of -1.5°. Thus bacteria as a class have a range for existence of about 373° (-273° to +100°) and for development of 94.5° (-1.5° to +93°) certainly much wider ranges than any other group of organisms.5
The optimum temperature for development varies within rather wide limits for different organisms. In general it may be stated that the optimum temperature is approximately that of the natural habitat of the organism, though there are exceptions. The optimum of the “hot spring” bacteria just mentioned is apparently that of the springs (93° in this case). Many soil organisms are known whose optimum is near 70° (a temperature rarely, if ever, attained in the soil), but only when grown in air or oxygen; but is very much lower when grown in the absence of oxygen. Many other soil organisms exhibit very little difference in rate or amount of growth when grown at temperatures which may vary as much as 10° or 15°, apparently an adaptation to their normal environment. The disease-producing organisms show much narrower limits for growth, especially those which are difficult to cultivate outside the body. For example, the bacterium of tuberculosis in man scarcely develops beyond the limits of 2° or 3° from the normal body temperature of man (37°), while the bacterium of tuberculosis in birds grows best at 41° to 45°, the normal for birds, and the bacterium of so-called tuberculosis of cold-blooded animals at 14° to 18°.
Those bacteria whose optimum temperature is above 40° are sometimes spoken of as the “thermophil” bacteria. The fixing of the “thermal death-point” that is, the minimum temperature at which the bacteria are killed is a matter of great practical importance in many ways and numerous determinations of this have been made with a great many organisms and by different observers. The factors which enter into such determinations are so many and so varied that unless all the conditions of the experiment are given together with the time of application, the mere statements are worthless. It may be stated that all young, actively growing (non-spore-containing) disease-producing bacteria, when exposed in watery liquids and in small quantities are killed at a temperature of 60° within half an hour. It is evident, that this fact has very little practical application, since the conditions stated are rarely, if ever, fulfilled except in laboratory experiments. (See Sterilization and Pasteurization, Chapter XIII.)
Speaking generally, it can be said that light is destructive to bacteria. Many growing forms are killed in a few hours when properly exposed to direct sunlight and die out in several days in the diffuse daylight of a well-lighted room. Even spores are destroyed in a similar manner, though the exposure must be considerably longer. Certain bacteria which produce colors may grow in the light, since the pigments protect them. Some few kinds, like the sulphur bacteria, which contain a purplish-red pigment that serves them to break up H2S, need light for their growth. Since disease-producing bacteria are all injuriously affected by light, the advantage of well-lighted habitations both for men and animals is obvious.
Oxygen is one of the constituents of protoplasm and is therefore necessary for all organisms. This does not mean that all organisms must obtain their supply from free oxygen, however, as animals and plants generally do. This fact is well illustrated by the differences among bacteria in this respect. Some bacteria require free oxygen for their growth and are therefore called aërobic bacteria or aërobes (sometimes strict aërobes, though the adjective is unnecessary). Others cannot grow in the presence of free oxygen and are therefore named anaërobic bacteria or anaërobes (strict is unnecessary). There are still other kinds which may grow either in the presence of free oxygen or in its absence, hence the term facultative anaërobes (usually) is applied to them. The distinction between facultative aërobe and facultative anaërobe might be made. The former means those which grow best in the absence of free oxygen, though capable of growing in its presence, while the latter term means those which grow best in the presence of free oxygen, but are capable of growing in its absence. The amount of oxygen in the atmosphere in which an organism grows may be conveniently expressed in terms of the oxygen pressure, i.e., in millimeters of mercury. It is evident that the maximum, minimum and optimum oxygen pressures for anaërobic bacteria are the same, namely, 0 mm. Hg. This is true only for natural conditions, since a number of anaërobic organisms have been gradually accustomed to increasing amounts of O, so that by this process of training they finally grew in ordinary air, that is, at an oxygen pressure of about 150 mm. Hg. (Normal air pressure is 760 mm. Hg. and oxygen makes up one-fifth of the air.) The minimum O pressure for facultative anaërobes is also 0 mm. Hg. Some experiments have been made to determine the limits for aërobes, but on a few organisms only, so that no general conclusions can be drawn from them. To illustrate: Bacillus subtilis (a common “hay bacillus”) will grow at 10 mm. Hg. pressure but not at 5 mm. Hg. It will also grow in compressed oxygen at a pressure of three atmospheres (2280 mm. Hg.), but not at four atmospheres (3040 mm. Hg.), though it is not destroyed.
Parodko has determined the oxygen limits for five common organisms as follows:
| Maximum. | Minimum | |||
| In atmospheres. | Mm. Hg. | Vol. per cent. | Mm. Hg. | |
| Bacterium fluorescens | 1.94 to 2.51 | 1474 to 1908 | 0.00016 = 0.0012 | |
| Sarcina lutea | 2.51 to 3.18 | 1908 to 2417 | 0.00015 = 0.0011 | |
| Proteus vulgaris | 3.63 to 4.35 | 2749 to 3306 | 0 | 0 |
| Bacterium coli | 4.09 to 4.84 | 3108 to 3478 | 0 | 0 |
| Erythrobacillus prodigiosus | 5.45 to 6.32 | 3152 to 4800 | 0 | 0 |
These few instances do not disclose any general principles which may be applied either for the growth or for the distinction of aërobes or facultative anaërobes.
It has been shown that compressed oxygen will kill some bacteria but this method of destroying them has little or no practical value. Oxygen in the form of ozone, O3, is rapidly destructive to bacteria, and this fact is applied practically in the purification of water supplies for certain cities where the ozone is generated by electricity obtained cheaply from water power. The same is true of oxygen in the “nascent state” as illustrated by the use of hypochlorites for the same purpose.
It was stated (p. 74) that certain thermophil bacteria in the soil have an optimum temperature for growth in the air which is much higher than is ever reached in their natural habitat and that they grow at a moderate temperature under anaërobic conditions. It has been shown that if these organisms are grown with aërobes or facultative anaërobes they thrive at ordinary room temperature. These latter organisms by using up the oxygen apparently keep the tension low, and this explains how such organisms grow in the soil.6
Like all living cells bacteria are very susceptible to changes in the density of the surrounding medium. If placed in a medium less concentrated than their own protoplasm water is absorbed and they “swell up”; while if placed in a denser medium, water is given off and they shrink (plasmoptysis or plasmolysis). Should these differences be marked or the transition be sudden, the cell walls may even burst and the organisms be destroyed. If the differences are not too great or if the transition is made gradually, the organisms may not be destroyed, but will either cease to grow and slowly die out, or will show very much retarded growth, or will produce abnormal cell forms. This is illustrated in the laboratory in attempting to grow bacteria on food material which has dried out. A practical application of osmotic effects is in the use of a high percentage of sugar in preserving fruits, etc., and in the salting of meats. Neither the cane-sugar nor the common salt themselves injure the bacteria chemically, but by the high concentration prevent their development. In drying material in order to preserve it there are two factors involved: first, the loss of water necessary for growth and second, the increased osmotic pressure.
In a medium of greater density diffusion of water is outward from the cell and this will continue until an equilibrium is established between cell contents and medium. Food for the organism must be in solution and enter the cell by diffusion. Therefore, growth ceases in a medium too dense, since water to carry food in solution does not enter the cell.
Careful experimenters have shown that the electric current, either direct or alternating, has no direct destructive effect on bacteria. In a liquid medium the organisms may be attracted to or repelled from one or the other pole or may arrange themselves in definite ways between the poles (galvanotaxis), but are not injured. However, electricity through the secondary effects produced, may be used to destroy bacteria. If the passage of the electric current increases the temperature of the medium sufficiently, the bacteria will be killed, or if injurious chemical substances are formed (ozone, chlorine, acids, bases, etc.), the same result will follow (see Ozone, pp. 77 and 157).
Röntgen or x-rays and radium emanations when properly applied to bacteria will destroy them. The practical use of these agents for the direct destruction of bacteria in diseases of man or animals is restricted to those cases where they may be applied directly to the diseased area, since they are just as injurious to the animal cell as they are to the bacteria, and even more so. Their skilful use as stimuli to the body cells to enable them to resist and overcome bacteria and other injurious organisms or cell growths is an entirely different function and will not be considered here.
Hydrostatic pressure up to about 10,000 pounds per square inch is without appreciable effect on bacteria as has been shown by several experimenters and also by finding living bacteria in the ooze dredged from the bottom of the ocean at depths of several miles.
Pressures from 10,000 to 100,000 pounds show variable effects. Some bacteria are readily killed and others, even non-spore formers, are only slightly affected. The time factor is important in this connection. The presence of acids, even CO2, or organic acids, results in the destruction of most non-spore formers.
Vibrations transmitted to bacteria in a liquid may be injurious to them under certain circumstances. Some of the larger forms like Bacillus subtilis may be completely destroyed by shaking in a rapidly moving shaking machine in a few hours. Bacteria in liquids placed on portions of machinery where only a slight trembling is felt, have been found to be killed after several days. Reinke has shown that the passing of strong sound waves through bacterial growths markedly inhibits their development.
Most bacteria are very susceptible to changes in the degree of acidity or alkalinity of the medium in which they grow. Some kinds prefer a slightly acid reaction, some a slightly alkaline, and some a neutral (with reference to litmus as indicator). The organism which is the commonest cause of the souring of milk thrives so well in the acid medium it produces that it crowds out practically all other kinds, though its own growth is eventually stopped by too much acid. Acid soils are usually low in numbers of bacteria and as a consequence produce poor crops. The disease-producing bacteria as a class grow best in a medium which is slightly alkaline.
Accurate determination of limits have been made on but few organisms. The reaction is a most important factor in growing bacteria on artificial media (see Making of Media, Chapter XVI).
The chemical composition is subject to wide variation chiefly for two reasons: First, the cell wall in most instances seems to exert only a slight selective action in the absorption of mineral salts so that their concentration within the cell is very nearly that of the surrounding medium. Second, the chief organic constitutents vary remarkably with the kind and amount of food material available—a rich protein pabulum increases the protein, a plentiful supply of carbohydrates or of fat results in the storing of more fat, especially and vice versa. These facts must be borne in mind in considering the chemistry of bacteria.
Of the chemical elements known, only the following seem to be essential in the structure of bacteria: carbon, hydrogen, oxygen, nitrogen, sulphur, phosphorus, chlorine, potassium, calcium, magnesium, iron, manganese. Other elements, as sodium, iodine, silicon, aluminum, lithium, copper, etc., have been reported by different analysts, but none of them can be regarded as essential, except possibly in isolated instances.
These elements exist in the bacterial cell in a great variety of combinations of which the most abundant is water. The amount of water varies in different species from 75 to 90 per cent. of the total weight in growing cells, and is less in spores. The amount of ash has been shown by different observers to vary from less than 2 per cent. to as much as 30 per cent. of the dry weight. The following table compiled from various sources will give an idea of the relative abundance of the different elements in the ash.
| S as SO3 | 7.64 per cent. (much more in sulphur bacteria) |
| P as P2O5 | 18.14 per cent. to 73.94 per cent. |
| Cl | 2.29 per cent. to 73.94 per cent. |
| K as K2O | 11.1 per cent. to 25.59 per cent. |
| Ca as CaO | 12.64 per cent. to 14.0 per cent. |
| Mg as MgO | 0.7 per cent. to 11.55 per cent. |
| Fe as Fe2O3 | 1.0 per cent. to 8.15 per cent. (iron bacteria) |
| Mn | traces |
As to the form in which the last six elements in the table exist in the cell, little is known. The sulphur and phosphorus are essential constituents of various proteins. The high percentage of phosphorus points to nuclein compounds as its probable source.
The carbon and nitrogen, together with most of the hydrogen and oxygen not united as water, make up the great variety of organic compounds which compose the main substances in the bacterial cell.
It has already been stated that the essential structures in the bacterial cell are cell wall and protoplasm, including the nuclein. These differ markedly in chemical composition. It is well known that the cell walls of green plants consist largely of cellulose and closely related substances.7 True cellulose has been recognized in but very few bacteria. (Sarcina ventriculi, Migula; Mycobacterium tuberculosis, Hammerschlag, Dreyfuss, Nishimura; Bacillus subtilis, Dreyfuss; Acetobacter xylinum, Brown; Acetobacter acidi oxalici, Banning; and a few others.) It is certainly not an important constituent of the cell wall in many. On the other hand, hemicellulose and gum-like substances have been identified in numerous organisms of this class as important constituents of the cell wall and of the capsule which is probably an outgrowth from the latter. Practically always associated with these substances are compounds containing nitrogen. One of these has been certainly identified as chitin or a closely similar substance. Chitin is the nitrogenous substance which enters largely into the composition of the hard parts of insects, spiders and crustaceans. It is an interesting fact to find this substance characteristic of these animals in bacteria, as well as other fungi.
Though it is extremely difficult to separate the cell wall of bacteria from the cell contents, in the light of our present knowledge it can be stated that the cell walls are composed of a carbohydrate body closely related to cellulose, though not true cellulose, probably in close combination with chitin.
Of the organic constituents of the cell contents the most abundant are various proteins which ordinarily make up about one-half of the dry weight of the entire cell. The “Mycoproteid” of Nencki, 1879, and other earlier workers is deserving of little more than historical interest, since these substances were certainly very impure and probably consisted of mixtures of several “proteins” in the more recent sense.
From later studies it seems probable that substances resembling the albumin of higher forms do not occur in bacteria, at least in appreciable quantities. Globulin has been reported by Hellmich in an undetermined bacterium, but is certainly not commonly found. The larger portion of the protein is of a comparatively simple type, in fact, consists of protamins most of which are in combination with nucleic acid as nucleoprotamins. Practically all recent workers find a high percentage of nuclein, both actually isolated and as indicated by the amounts of purin bases—xanthin, guanin, adenin—obtained, as well as by the abundance of phosphorus in the ash, already mentioned. Some of these nucleins have been shown to have poisonous properties.
Closely related to but not identical with the proteins are the enzymes and toxins which are formed in the cell and exist there as endo-enzymes or endo-toxins respectively. These substances will be discussed later under the heading “Physiological Activities of Bacteria” (Chapter XII).
Carbohydrates are not commonly present in the cell contents, though glycogen has been observed in a few and a substance staining blue with iodine in one or two others. This latter substance was at first considered to be starch “granulose,” but is probably more closely related to glycogen.
Fats seem to be very generally present. The commoner fats—tri-olein, tri-palmitin, tri-stearin have been found by many analysts. The “acid-fast bacteria” are particularly rich in fatty substances, especially the higher wax-like fats. Lecithins (phosphorized fats) and cholesterins (not fats but alcohols) have been repeatedly observed and probably occur in all bacteria as products of katabolism.
Organic acids and esters occur as cell constituents but will be discussed in connection with their more characteristic occurrences as products of bacterial activity, as will also pigments which may likewise be intracellular in some instances.
The following analysis of tubercle bacilli, from de Schweinitz and Dorset, while not intended as typical for all bacteria, still illustrates the high percentage of protein compounds which undoubtedly occurs in most, as well as showing the large amount of fatty substance in a typical “acid-fast” organism:
| In the dried organisms | 8.5 | per cent. tuberculinic acid | |||
| 24.5 | per cent. nucleoprotamin | 55.8 per cent. protein. | |||
| 23.0 | per cent. neucleoprotein | ||||
| 8.3 | per cent. proteinoid | ||||
| 26.5 | per cent. fat and wax | ||||
| 9.2 | per cent. ash | ||||
The foregoing brief review of the chemical composition of the bacterial cell illustrates the variety of compounds which necessarily occurs, but affords no definite clue as to the source of the elements which enter into these compounds. These elements come from the material which the organism uses as food. Under this term are included elements or compounds which serve as building material, either for new cell substance or to repair waste, or as sources of energy.
An organism which is capable of making use of an element in the free state is said to be prototrophic for that particular element. Thus aërobes and facultative anaërobes are prototrophic for O. The “root-tubercle bacteria” of leguminous and other plants and certain free living soil organisms are prototrophic for N.8
On the other hand, if the element must be secured from compounds, then the organism is metatrophic in respect to the element in question. Should the compound be inorganic, the term autotrophic is applied to the organism and heterotrophic if the compound is organic. It is very probable that anaërobes, exclusive of a few nitrogen absorbers, are metatrophic for all the elements they utilize. With the exception of the anaërobes it seems that all bacteria are mixotrophic, that is, prototrophic for one or two elements and auto- or heterotrophic for the others.9
Those bacteria whose food consists of dead material are spoken of as saprophytes, while those whose natural habitat, without reference to their food, is in or on other living organisms are called parasites. The host is the organism in or on which the parasite lives. Parasites may be of several kinds. Those which neither do injury nor are of benefit to the host are called non-pathogenic parasites or commensals; many of the bacteria in the intestines of man and other animals are of this class. Those which do injury to the host are called pathogenic or disease-producing, as the organisms causing the transmissible diseases of animals and plants.10 Finally, we have those parasites which are of benefit to and receive benefit from the host. These are called symbionts or symbiotic parasites and the mutual relationship symbiosis. Certain of the intestinal bacteria in man and especially in herbivorous animals are undoubted symbionts, as are also the “root-tubercle bacteria” already mentioned.
It is evident that all parasites that may be cultivated outside the body are for the time saprophytic, hence the terms strict parasites and facultative parasites, which should require no further explanation.
The changes which the above-mentioned types of food material undergo in the various anabolic and katabolic processes within the cell are as yet but very slightly known. Nevertheless there are a number of reactions brought about by bacteria acting on various food materials, partly within but largely without the cell which are usually described as “physiological activities” or “biochemical reactions.” Some of these changes are to be ascribed to the utilization of certain of the elements and compounds in these materials as tissue builders, some as energy-yielding reactions and still others as giving rise to substances that are of direct benefit to the organism concerned in its competition with other organisms.
Though all of the twelve elements already mentioned are essential for the growth of every bacterium, two of them are of especial importance for the reason that most of the “physiological activities” to be described in the next chapters are centered around their acquisition and utilization. These elements are carbon and nitrogen. Some few of the special activities of certain groups have to do with one or the other of the remaining nine, as will be shown later. But generally speaking when a bacterium under natural conditions secures an adequate supply of carbon and nitrogen, the other elements are readily available in sufficient amount.
Carbon is necessary not only because it is an essential constituent of protoplasm but because its oxidation is the chief source of the energy necessary for the internal life of the cell, though nitrogen and sulphur replace it in this function with a few forms. This latter use of carbon constitutes what may be called its respiratory function. Bacteria like other organisms in their respiration utilize oxygen and give off carbon dioxide. The amount of the latter given off from the cell in this way is very small as compared with that which is frequently produced as an accompaniment of other reactions (see Fermentation, next chapter). But there is no doubt of its formation and it has been determined by a few investigators. On account of this use of carbon, bacteria require relatively large amounts of this element. One group of bacteria concerned in the spontaneous heating of coal seems to be able to use free carbon from this material. Another group is said to be able to oxidize marsh gas, CH4, and use this as its source of carbon. The nitrite, nitrate and sulphur bacteria mentioned later utilize carbon dioxide and carbonates as their carbon supply, and one kind has been described which uses carbon monoxide. With these few exceptions bacteria are dependent on organic compounds for their carbon and cannot use CO2 as green plants do.
The oxygen requirement is high partly for the same reason that carbon is, i.e., respiration. Oxygen is one of the constituents of protoplasm, and combined with hydrogen forms water which makes up such a large part of the living cell. Anaërobic bacteria are dependent on so-called “molecular respiration” for their energy. That is, through a shifting or rearrangement of the atoms in the compounds used as food the oxidation of carbon is brought about. Enzymes are probably responsible for this action. Carbon dioxide is produced by anaërobes as well as by aërobes, and frequently in amounts readily collected. A carbohydrate is usually though not always essential for the growth of anaërobes and serves them as the best source of energy.
Nitrogen is the characteristic element of living material. Protoplasm is a chemical substance in unstable equilibrium and nitrogen is responsible for this instability. No other of the commoner elements is brought into combination with such difficulty, nor is so readily liberated when combined (all commercial explosives are nitrogen compounds). Bacteria, like other forms of protoplasm, require nitrogen. More marked peculiarities are shown by bacteria with reference to the sources from which they derive their nitrogen than for carbon. Some can even combine the free nitrogen of the air and furnish the only natural means of any importance for this reaction. Some few forms (the nitrite and nitrate formers, Chapter XI) obtain their energy from the oxidation of inorganic nitrogen compounds, ammonia and nitrites respectively, and not from carbon. These latter bacteria use carbon from carbon dioxide and carbonates. A great many bacteria can secure their nitrogen from nitrates but some are restricted to organic nitrogen. Many bacteria obtain their carbon from the same organic compounds from which their nitrogen is derived.
Sulphur serves mainly as a constituent of protein compounds in the protoplasmic structure. In some of the sulphur bacteria it is a source of energy, since either free sulphur or H2S is oxidized by them. Some of these bacteria can obtain their carbon from CO2 or carbonates, and their nitrogen from nitrates or ammonium salts.
Whether the iron bacteria, belonging to the genus Crenothrix of the higher, thread bacteria, use this element or its compounds as sources of energy is still a disputed question. The evidence is largely in favor of this view.
Free hydrogen has been shown to be oxidized by some forms which obtain their energy in this way.
Whether there is a special class of phosphorus bacteria remains to be discovered. That phosphorus is oxidized during the activity of many bacteria is undoubted, but whether this represents a source of energy or is the accidental by-product of other activities is undetermined.
Practically nothing is known about the metabolism of the other elements as such.
From the preceding brief review of the relation of certain bacteria to some of the elements in the free state and from the further fact that there is scarcely a known natural organic compound which cannot be utilized by some kind of bacterium, it is evident that this class of organisms has a far wider range of adaptability than any other class, and this adaptability helps to explain their seemingly universal distribution.
As to the metabolism within the cell, no more is known than is the case with other cells, nor even as much. The materials used for growth and as sources of energy are taken into the cell, built up into various compounds some of which have been enumerated and in part broken down again. Carbon dioxide and water are formed in the latter process. What other katabolic products occur it is not easy to determine. Certainly some of the substances mentioned in the next chapters are such products but it is not always possible to separate those formed inside the cell from those formed outside. Perhaps most of the latter should be considered true metabolic products. It would seem that on account of the simplicity of structure of the bacterial cell and of the compounds which they may use as food they would serve as excellent objects for the study of the fundamental problems of cell metabolism. Their minuteness and the nearly impossible task of separating them completely from the medium in or on which they are grown makes the solution of these problems one of great difficulty.
When all of the environmental conditions necessary for the best development of a given bacterium are fulfilled, it will then develop to the limit of its capacity. This development is characterized essentially by its reproduction, which occurs by transverse division. The rate of this division varies much with the kind even under good conditions. The most rapid rate so far observed is a division in eighteen minutes. A great many reproduce every half-hour and this may be taken as a good average rate. If such division could proceed without interruption, a little calculation will show that in about sixty-five hours a mass as large as the earth would be produced.
| ½ hour | = | 2 | ||
| 1 hour | = | 4 | ||
| 2 hours | = | 16 | ||
| 4 hours | = | 256 | ||
| 5 hours | = | 1024 | = | 103+ |
| 15 hours | = | 1,000,000,000 | = | 109 = 0.5 cc. |
| 35 hours | = | 1021+ | = | 500.0 cu.m. |
| About 65 hours | = | 2 × 1042+ | = | 5 × 1020 cu.m. = a mass as large as the earth. |
Such a rate of increase evidently cannot be kept up long on account of many limiting factors, chief of which is the food supply.
The foregoing calculation is based on the assumption that the organism divides in one plane only. If it divides in 2 or 3 planes, the rate is much faster, as is shown by the following formulæ, which indicate the theoretical rate of division:
With two-plane or three-plane division, assuming that each organism attains full size, as was assumed in the first calculation, the “mass as large as the earth” would be attained in about thirty-two and twenty-two hours respectively.
This extraordinary rate of increase explains in large measure why bacteria are able to bring about such great chemical changes in so short a time as is seen in the rapid “spoiling” of food materials, especially liquids. The reactions brought about by bacteria on substances which are soluble and diffusible are essentially “surface reactions.” The material diffuses into the cell over its entire surface with little hindrance. The bacteria are usually distributed throughout the medium, so that there is very intimate contact in all parts of the mass which favors rapid chemical action. The following calculation illustrates this:
It is not uncommon to find in milk on the point of souring 1,000,000,000 bacteria per cc.
Assuming these to be cocci of 1µ diameter the volume of these bacteria in a liter is only 0.05 cc. or in the liter there would be 19999 parts of milk and only 1 part bacteria. The surface area of these bacteria is 3141.6 sq. cm. With this large surface exposed, it is not strange that the change from “on the point of souring” to “sour” occurs within an hour or less.
Although large numbers of bacteria can and do cause great chemical changes the amount of material actually utilized for maintenance of the cell is very slight, infinitesimal almost, and yet is fairly comparable to that required for man, as is illustrated by the following computations:
E. Kohn has shown that certain water bacteria grew well in water to which there was added per liter 0.000002 mg. dextrose, 0.00000007 mg. (NH4)2SO4 and 0.0000000007 mg. (NH4)2HPO4. The bacteria numbered about 1000 per cc. Taking the specific gravity at 1 (a little too low) the mass of the bacteria in the liter was about 0.001 mg. Hence the bacteria used 0.002 of their weight of carbohydrate and 0.00007 of ammonium sulphate. A 150-pound (75-kilo) man can live on 375 g. of sugar (0.005 of his weight) and 52.5 g. of protein (0.0007 of his weight). From these figures it can be calculated that the man utilizes about two and a half times as much carbohydrate and about seven times as much nitrogen as the bacterium, relatively speaking.
The physiological activities of motion, reproduction and metabolism within the cell have been discussed in previous chapters. The objects in view in the discussion of the “physiological activities” (sometimes spoken of as “biochemical” activities) of bacteria in this and subsequent chapters are to familiarize the student to some extent with the great range of chemical changes brought about by these minute organisms, to show their usefulness, even their necessity, and to impress the fact that it is chiefly by a careful study of these “activities” that individual kinds of bacteria are identified. It should always be borne in mind that the bacteria, in bringing about these changes which are so characteristic in many instances, are simply engaged in their own life struggle, in securing the elements which they need for growth, in liberating energy for vital processes, or occasionally in providing conditions which favor their own development and hinder that of their competitors.
By this is meant the changes which different carbohydrates undergo when subjected to bacterial action.11
These changes are marked chiefly by the production of gas or acid. The former is called “gaseous fermentation” the latter “acid fermentation.” The gases commonly produced are carbon dioxide (CO2) hydrogen and marsh gas (CH4). Other gases of the paraffin series may also be formed as ethane (C2H6), acetylene (C2H2), etc. CO2 and H are the ones usually formed from sugars by the few gas-forming bacteria which produce disease, though even here some CH4 is present. The common Bacterium coli forms all three, though the CH4 is in smallest quantity.


In the fermentation of the polysaccharids—starch and especially cellulose and woody material—large amounts of CH4 occur, particularly when the changes are due to anaërobic bacteria. This phenomenon may be readily observed in sluggish streams, ponds and swamps where vegetable matter accumulates on the bottom. The bubbles of gas which arise when the mass is disturbed explode if a lighted match is applied to them.
The author has conducted a number of experiments to demonstrate this action as follows: Material taken from the bottom of a pond in the fall after vegetation had died out was packed into a cylinder five feet long and six inches in diameter, water was added to within about 2 inches of the top. After leaving them open for a few days to permit all the dissolved oxygen to be used up by the aërobes, the cylinders were tightly capped and allowed to stand undisturbed. Pressure gauges reading to 500 lbs. were attached (Fig. 60). At the end of six months the gauge showed a pressure beyond the limits of the readings on it. Most of the gas was collected and measured 146 liters. An analysis of portions collected when about one-half had been allowed to escape showed the following composition, according to Prof. D. J. Demorest of the Department of Metallurgy:
| CO2 | 18.6 per cent. |
| CH4 | 76.1 per cent. |
| H | 1.0 per cent. |
| N | 4.3 per cent. |
In the author’s opinion natural gas and petroleum have been formed in this way12 (Figs. 61 and 62).

One of the very few practical uses of the gaseous fermentation of carbohydrates is in making “salt rising” bread. The “rising” of the material is due not to yeasts but to the formation of gas by certain bacteria which are present on the corn meal or flour used in the process (Fig. 63).

Another is in the formation of the “holes” or “eyes” so characteristic of Swiss and other types of cheese (Fig. 64).

A great many organic acids are formed during the “acid fermentation” of carbohydrates by bacteria. Each kind of bacterium, as a rule, forms several different acids as well as other substances, though usually one is produced in much larger amounts, and the kind of fermentation is named from this acid. One of the commonest of these acids is lactic. The “lactic acid bacteria” form a very large and important group and are indispensable in many commercial processes. In the making of butter the cream is first “ripened,” as is the milk from which many kinds of cheese are made (Fig. 65). The chief feature of this “ripening” is the formation of lactic acid from the milk-sugar by the action of bacteria. A similar change occurs in the popular “Bulgarian fermented milk.” The reaction is usually represented by the equation:
It is not probable that the change occurs quantitatively as indicated, because a number of other substances are also formed. Some of these are acetic and succinic acids and alcohol. Another industrial use of this acid fermentation is in the preparation of “sauer kraut.” These bacteria are chiefly anaërobic and grow best in a relatively high salt concentration. They occur naturally on the cabbage leaves.

In the formation of ensilage (Fig. 66) the lactic acid bacteria play a very important part, as they do also in “sour mash” distilling, and in many kinds of natural “pickling.” In fact, whenever green vegetable material “sours” spontaneously, lactic acid bacteria are always present and account for a large part of the acid. This property of lactic acid formation is also taken advantage of in the preparation of lactic acid on a commercial scale in at least one plant in this country.

Acetic acid is another common product of acid fermentation. However, in vinegar making the acetic acid is not formed directly from the sugar in the fruit juice by bacteria. The sugar is first converted into alcohol by yeasts, then the alcohol is oxidized to acid by the bacteria (Fig. 67). The reaction may be represented as follows:
Butyric acid is generally produced where fermentation of carbohydrates occurs under anaërobic conditions. Some of the “strong” odor of certain kinds of cheese is due to this acid which is formed partly from the milk-sugar remaining in the cheese. Most of it under these conditions comes from the proteins of the cheese and especially from the fat (see page 101).
As has been indicated alcohol is a common accompaniment of most acid fermentations, as are the esters of acids other than the chief product. Bacteria are not used in a commercial way to produce alcohol, however, as the yield is too small. There are some few bacteria in which the amount of alcohol is prominent enough to call the process an “alcoholic fermentation” rather than an acid one. In brewing and distilling industries, yeasts are used to make the alcohol, though molds replace them in some countries (“sake” and “arrak” from rice).

Under ordinary conditions the carbohydrate is never completely fermented, since the accumulation of the product—acid—stops the reaction. If the acid is neutralized by the addition of an alkali—calcium or magnesium carbonate is best—then the sugar may all be split up. Where such fermentation occurs under natural conditions, the products are further split up, partly by molds and partly by acid-destroying bacteria into simpler acids and eventually to carbon dioxide and water, so that the end-products of the complete fermentation of carbohydrate material in nature are carbon dioxide, hydrogen, marsh gas, and water.
In all of these fermentations the bacteria are utilizing the carbon both as building material and for oxidation and the fermentations are incidental to this use. As a rule, the acid-forming bacteria can withstand a higher concentration of acid than the other bacteria that would utilize the same material, and in a short time crowd out their competitors or inhibit their growth, and thus have better conditions for their own existence, though finally their growth is also checked by the acid.
The splitting of fats into glycerin and the particular acid or acids involved may be brought about by bacteria. An illustration is the development of rancidity in butter at times and the “strong” odor of animal fats on long keeping and of many kinds of cheese—“limburger”—in this country. Generally speaking, however, fats are not vigorously attacked, as is illustrated by the difficulties due to accumulation of fats in certain types of sewage-disposal works. The chemical change is represented by the equation:
The word “putrefaction” is now restricted to the action of bacteria on the complex nitrogen-containing substances, proteins, and their immediate derivatives. The process is usually accompanied by the development of foul odors.
Bacteria make use of proteins chiefly as a source of nitrogen, but also as a source of carbon and other elements. Proteins contain nitrogen, carbon, hydrogen, oxygen, sulphur and frequently phosphorus. Some of the metals—potassium, sodium, calcium, magnesium, iron and manganese and the non-metal chlorine—are nearly always associated with them more or less intimately. Since these bodies are the most complex of natural chemical substances it follows that the breaking up of the molecule to secure a part of the nitrogen gives rise to a great variety of products.
There are marked differences among bacteria in their ability to attack this class of compounds. Some can break up the most complex natural proteins such as albumins, globulins, glyco-, chromo-, and nucleoproteins, nucleins and albuminoid derivatives like gelatin. The term saprogenic (σαπρος = rotten) is sometimes applied to bacteria which have this power. These proteins are large-moleculed and not diffusible, so that the first splitting up that they undergo must occur outside the bacterial cell. The products of this first splitting may diffuse into the cell and be utilized there. The bacteria of this class attack not only these proteins in the natural state or in solution, but also in the coagulated state. The coagulum becomes softened and finally changed into a liquid condition. The process when applied to the casein of milk is usually called “digestion,” also when coagulated blood serum is acted on. In the latter case the serum is more commonly said to be “liquefied” as is the case when gelatin is the substance changed. Most of these bacteria have also the property of coagulating or curdling milk in an alkaline medium, and then digesting the curd. A second class of bacteria has no effect on the complex proteins just mentioned but readily attacks the products of their first splitting, i.e., the proteoses, peptones, polypeptids and amino-acids. They are sometimes called saprophilic bacteria.
Other bacteria derive their nitrogen from some of the products of the first two groups, and still further break down the complex protein molecule. Under normal conditions these various kinds of bacteria all occur together and thus mutually assist one another in what is equivalent to a symbiosis or rather a metabiosis, a “successive existence,” one set living on the products of the other. The result is the complete splitting up of the complete protein molecule. A part of the nitrogen is built up into the bodies of the bacteria which are using it as food. A part is finally liberated as free nitrogen or as ammonia after having undergone a series of transformations many of which are still undetermined.
One class of compounds formed received at one time
much attention because they were supposed to be responsible
for a great deal of illness. These are the “ptomaines,”
basic nitrogen compounds of definite composition—amines—some
few of which are poisonous, most of them not. The
basic character of ptomaines may be understood if they be
regarded as made up of one or more molecules of ammonia
in which the hydrogen has been replaced by alkyl or other
radicals. Thus ammonia (NH3) may be represented as
.
The simplest ptomaine is
,
in which one H is replaced by methyl, methylamine, a gaseous ptomaine.
With two hydrogens replaced by methyl,
,
dimethylamine, also a gas at ordinary temperature, is formed.
Trimethylamine,
,
a liquid, results when three hydrogens
are similarly replaced. All three of these occur in herring
brine and are responsible for the characteristic odor
of this material. Putrescin and cadaverin—tetramethylene—diamine,
and pentamethylenediamine respectively—occur
generally in decomposing flesh, hence the names.
They are only slightly poisonous. One of the highly poisonous
ptomaines is neurin C5H13NO or C2H3N(CH3)3OH = trimethyl-vinyl
ammonium hydroxide. This is a stronger
base than ammonia, liberating it from its salts. Numerous
other ptomaines have been isolated and described. These
bodies were considered for a long time to be the cause of
various kinds of “meat poisoning,” “ice cream poisoning,”
“cheese poisoning,” etc. It is true that they may
sometimes cause these conditions, but they are very much
rarer than the laity generally believe. Most of the “meat
poisonings” in America are due, not to ptomaines, but to
infections with certain bacilli of the Bacterium enteritidis
group. Occasionally a case of poisoning by the true toxin
(see Chapter XII) of Clostridium botulinum occurs, and in
recent years has become entirely too common due to insufficient
heating of canned goods. The boiling of such
material will destroy this toxin. The safest rule to follow is
not to eat any canned material that shows any departure from
the normal in flavor, taste or consistency.
As ptomaines result from the putrefaction of proteins, so they are still further decomposed by bacteria and eventually the nitrogen is liberated either as free nitrogen or as ammonia.
Another series of products are the so-called aromatic compounds—phenol (carbolic acid), various cresols, also indol and skatol or methyl indol (these two are largely responsible for the characteristic odor of human feces). All of these nitrogen compounds are attacked by bacteria and the nitrogen is eventually liberated, so far as it is not locked up in the bodies of the bacteria, as free nitrogen or as ammonia.
The carbon which occurs in proteins accompanies the nitrogen in many of the above products, but also appears in nitrogen-free organic acids, aldehydes and alcohols which are all eventually split up, so that the carbon is changed to carbon dioxide or in the absence of oxygen partly to marsh gas.
The intermediate changes which the sulphur in proteins undergoes are not known, but it is liberated as sulphuretted hydrogen (H2S) or as various mercaptans (all foul-smelling), or is partially oxidized to sulphuric acid. Some of the H2S and the sulphur of the mercaptans are oxidized by the sulphur bacteria to free sulphur and finally to sulphuric acid.
Phosphorus is present especially in the nucleoproteins and nucleins. Just what the intermediate stages are, on whether there are any, so far as the phosphorus is concerned, in the splitting up of nucleic acid by bacterial action is not determined. The phosphorus may occur as phosphoric acid in such decompositions, or when the conditions are anaërobic, as phosphine (PH3), which burns spontaneously in the air to phosphorus pentoxide (P2O5), and water.13
The hydrogen in proteins appears in the forms above indicated: H4C, H3N, H3P, H2S, H2O and as free H. The oxygen as CO2 and H2O.
In the breaking down of the complex protein molecule even by a single kind of bacterium there is not a perfect descending scale of complexity as might be supposed from the statement that there result proteoses, peptones, polypeptids, amino-acids. These substances do result, but at the time of their formation simpler ones are formed also, even CO2, NH3 and H2S. It appears that the entire molecule is shattered in such a way that less complex proteins are formed from the major part, while a minor portion breaks up completely to the simplest combinations possible. A more complete knowledge of these decompositions will aid in the further unravelling of the structure of proteins. The presence or absence of free oxygen makes a difference in the end-products, as has been indicated. There are bacteria which oxidize the ammonia to nitric acid and the H2S to sulphuric acid. (See Oxidation, Chapter XI.) Bacteria which directly oxidize phosphorus compounds to phosphoric acid have not been described. It does not seem that such are necessary since this is either split off from nucleic acid or results from the spontaneous oxidation of phosphine when this is formed under anaërobic conditions.
Not only are proteins decomposed as above outlined, but also their waste products, that is, the form in which their nitrogen leaves the animal body. This is largely urea in mammals, with much hippuric acid in herbivorous animals and uric acid in birds and reptiles. These substances yield NH3, CO2 and H2O with a variety of organic acids as intermediate products in some cases. The strong odor of ammonia in stables and about manure piles is the everyday evidence of this decomposition.
Where the putrefaction of proteins occurs in the soil with moderate amounts of moisture and free access of air a large part of the products is retained in the soil. Thus the ammonia and carbon dioxide in the presence of water form ammonium carbonate; the nitric, sulphuric and phosphoric acids unite with some of the metals which are always present to form salts. Some of the gases do escape and most where the oxygen supply is least, since they are not oxidized.
The protein-splitting reactions afford valuable tests in aiding in the recognition of bacteria. In the study of pathogenic bacteria the coagulation and digestion of milk, the digestion or liquefaction of blood serum, the liquefaction of gelatin and the production of indol and H2S are those usually tested for. In dairy bacteriology the coagulation of milk and the digestion of the casein are common phenomena. Most bacteria which liquefy gelatin also digest blood serum and coagulate and digest milk, though there are exceptions. In soil bacteriology the whole range of protein changes is of the greatest importance.




The three physiological activities already discussed explain how bacteria break down the chief complex, energy-rich substances—carbohydrates, fats and proteins which constitute the bulk of the organic material in the bodies of plants and animals, as well as the waste products of the latter—into energy-free compounds like carbon dioxide, water, ammonia, nitric, sulphuric and phosphoric acids—mineralize them, as is frequently said. By so doing the bacteria act as the great scavengers of nature removing the dead animal and vegetable matter of all kinds which but for this action would accumulate to such an extent that all life, both on land and in the water, must cease. It is further to be noted that not only is all this dead organic matter removed; but it is converted into forms which are again available for plant growth. Carbon dioxide forms the source of the carbon in all green plants, hence in all animals; the sulphates and phosphates are likewise taken up by green plants and built up again into protein compounds; the ammonia is not directly available to green plants to any large extent but is converted by the nitrifying bacteria (Chapter XI) into nitrates which is the form in which nitrogen is assimilated by these higher types. Even the free nitrogen of the air is taken up by several kinds of bacteria, the symbiotic “root-tubercle bacteria” of leguminous and other plants, and some free-living forms, and made available. Hence bacteria are indispensable in nature, especially in keeping up the circulation of nitrogen. They are also of great service in the circulation of carbon, sulphur and phosphorus. Though some few kinds cause disease in man and animals, if it were not for the saprophytic bacteria above outlined, there could be no animals and higher plants to acquire these diseases.
The production of organic acids has been sufficiently discussed in preceding chapters. It should be noted that not only these in great variety are produced by bacteria but that under certain conditions mineral acids, such as nitric, sulphuric and phosphoric may be formed (see Oxidation, p. 114). Acid production is of great value in the identification of bacteria in dairy and soil work and in connection with certain types of pathogenic bacteria.
It will be sufficient merely to enumerate collectively the various gases mentioned in preceding paragraphs and to state that those commonly observed in the study of pathogenic bacteria are the first six mentioned. Most of them come in in dairy work either in the study of bacteria causing milk and cheese “failures” or as affecting the flavors of butter or cheese. In the study of soil organisms, any or all of them are liable to be of importance. The gases are: CO2, H, CH4, N, NH3, H2S, gaseous mercaptans, gaseous ptomaines, volatile fatty acids, ethereal salts or esters and others, both of pleasant and of foul odor, but of unknown composition.
The production of esters, as mentioned in Chapters IX and X, of various alcohols and aldehydes are activities which are sometimes of value in the study of bacteria, but need not be further discussed.
These have been mentioned in discussing the putrefaction of proteins, as indol, skatol, phenol and various cresols. Of these only the first is ordinarily tested for in the study of bacteria, though others of the group become of value in certain special cases.

This is a most interesting phenomenon associated with the growth of some bacteria. The “fox fire” frequently seen on decaying wood which is covered with a slimy deposit is most commonly due to bacteria, though also to other fungi. Phosphorescent bacteria are very common in sea water, hence they are frequently found on various sea foods, especially when these are allowed to decompose, such as fish, oysters, clams, etc. The light is due to the conversion of the energy of unknown easily oxidizable compounds directly into visible radiant energy through oxidation without appreciable quantities of heat. The light produced may be sufficient to tell the time on a watch in absolute darkness, and also to photograph the growths with their own light, but only after several hours’ exposure (Fig. 72). None of the phosphorescent bacteria so far discovered produce disease in the higher animals or man.
One of the most striking results of bacterial activity is this phenomenon. The particular color which results may be almost any one throughout the range of the spectrum, though shades of yellow and of red are of more frequent occurrence.
In the red sulphur bacteria the “bacteriopurpurin” which they contain appears to serve as a true respiratory pigment in a manner similar to the chlorophyl in green plants, except that these bacteria oxidize H2S in the light as a source of energy instead of splitting up CO2. The red pigment produced by certain bacteria has been shown to have a capacity for combining with O resembling that of hemoglobin, and some investigators have believed that such bacteria do store O in this way for use when the supply is diminished. With these few exceptions the pigments seem to be merely by-products of cell activity which are colored and have no known function.
The red sulphur bacteria above mentioned and one or two other kinds retain the pigments formed within the cell. Such bacteria are called chromophoric as distinguished from the chromoparic bacteria whose pigment lies outside the cell.
The chemical composition of no bacterial pigment has been determined up to the present. Some are soluble in water, as shown by the discoloration of the substances on which they grow. Others are not soluble in water but are in alcohol, or in some of the fat solvents as ether, chloroform, benzol, etc. These latter are probably closely related to the lipochromes or “fat colors” of higher plants and animals. Attempts have been made to render the production of pigments a still more reliable means of identification of species of bacteria through a careful examination of the spectra of their solutions, but such study has not as yet led to any valuable practical results.
The production of pigment depends on the same general factors which determine the growth of the organism but does not necessarily run parallel with these. It is especially influenced by the oxygen supply (only a very few organisms are known which produce pigment anaërobically—Spirillum rubrum is one); by the presence of certain food substances (starch, as in potato, for many bacteria producing yellow and red colors; certain mineral salts, as phosphates and sulphates, for others); by the temperature (many bacteria cease to produce color at all if grown at body temperature, 37°—Erythrobacillus prodigiosus—or if grown for a longer time at temperatures a few degrees higher).
Reduction of nitrates to nitrites or to ammonia or even to free nitrogen is brought about by a great many different kinds of bacteria. In many instances this phenomenon is due to a lack of free oxygen, which is obtained by the bacteria from these easily reducible salts. In other cases a portion of the nitrogen is removed to be used as food material in the building up of new protein in the bacterial cell. This latter use of the nitrogen of nitrates by bacteria might theoretically result in considerable loss of “available nitrogen” in the soil as has actually been shown in a few experiments. The reduction of nitrates as above mentioned would also diminish this supply, but probably neither of these results has any very great practical effect on soil fertility. The building up of protein from these mineral salts by bacteria in the intestines of herbivorous animals has been suggested by Armsby as a considerable source of nitrogenous food, and this suggestion appears possible.
The liberation of nitrogen from nitrates or nitrites, either as free nitrogen or as ammonia, is spoken of as “dentrification,” though this term was formerly applied to such liberations, from compounds of nitrogen generally even from proteins.
Certain bacteria may also reduce sulphates and other sulphur compounds to H2S, a phenomenon frequently observed in sewage and likewise of importance in the soil. It is possible that phosphates may be similarly reduced.14 Further and more careful study of the reducing actions of bacteria is needed.
As has been stated in discussing the respiration of bacteria (Chapter VIII) most of these organisms gain their energy through the oxidation of carbon in various forms, chiefly organic, so that CO2 is a product of the activity of nearly all bacteria. Some few oxidize CO to CO2, others CH4 and other paraffins to CO2 for this purpose. One class of bacteria even oxidizes H in small amounts for its energy and uses the carbon dioxide of the air or traces of organic carbon in the air as a source of carbon for “building” purposes.
One of the familiar oxidations of organic carbon is that of the acetic acid bacteria in the making of vinegar. These oxidize the alcohol which results from the action of yeast to acetic acid according to the formula CH3CH2OH + O2 = CH3COOH + H2O (see Fig. 67).
Of the various phenomena of oxidation due to bacteria, the formation of nitrites and nitrates has the greatest practical importance, since it is by this means that the ammonia which results from the decomposition of animal and vegetable tissue and waste products is again rendered available to green plants as food in the form of nitrates. Practically all the nitrates found in nature, sometimes in large quantities, are formed in this way. There are two distinct kinds of bacteria involved. One, the nitrous bacteria, oxidizes the ammonia to nitrous acid which forms nitrites with bases, and the other, the nitric bacteria, oxidizes the nitrous to nitric acid, giving nitrates with bases. A striking peculiarity of these two classes of organisms is that they may live entirely on inorganic food materials, are proto-autotrophic, prototrophic for oxygen (aërobic) and autotrophic for the other elements. Their carbon is derived from CO2 or carbonates. The importance of such organisms in keeping up the supply of nitrates in the soil can scarcely be overestimated.

The oxidation of the H2S, which is formed in the putrefaction of proteins, to free S by the sulphur bacteria and the further oxidation of this free S to sulphuric acid, and of the phosphorus, so characteristic of the nucleins, to phosphoric acid have been referred to. These activities of bacteria are of great value in the soil. Doubtless the commercial “phosphate rock” owes its origin to similar bacterial action in ages past.
The oxidation of H2S to free S may be an explanation of the origin of the great deposits of sulphur which are found in Louisiana and along the Gulf coast. These deposits occur in the same general regions as natural gas and oil. The sulphur might have been derived from the same organic material carried down by the Mississippi which yielded the oil and gas.15
A purposeful utilization of the oxidizing power of bacteria is in “contact beds,” “sprinkling filters” and “aërated sludge tanks” in sewage disposal works. In these instances the sewage is thoroughly mixed with air and brought in contact with large amounts of porous material so as to expose an extensive surface for oxidation (Fig. 73).

A direct result of the oxidizing action of bacteria is the production of heat. Under most conditions of bacterial growth this heat is not appreciable. It may become well marked. The “heating” of manure is one of the commonest illustrations. The temperature in such cases may reach 70°. The heating of hay and other green materials is due chiefly to bacterial action. This heating may lead to “spontaneous combustion.” The high temperatures (60° to 70°) favor the growth of thermophil bacteria which cause a still further rise. The heat dries out the material, portions of which are in a state of very fine division due to the disintegrating action of the organisms. The hot, dry, finely divided material oxidizes so rapidly on contact with the air that it ignites.
A practical use of heat production by bacteria is in the making of “hot beds” for forcing vegetables (Fig. 74).

This is likewise one of the most important practical activities of certain types of bacteria present in the soil. The ability of plants of the legume family to enrich the soil has been known and taken advantage of for centuries, but it is only about thirty years since it was demonstrated that this property is due to bacteria. These plants, and several other kinds as well, have on their roots larger or smaller nodules (Fig. 75) spoken of as “root tubercles” which are at certain stages filled with bacteria. When conditions are favorable, these bacteria live in symbiotic relationship with the plant tissues, receiving carbonaceous and other food material from them and in return furnishing nitrogenous compounds to the plant. This nitrogenous material is built up from free nitrogen absorbed from the air by the bacteria. The utilization of this peculiar property through the proper cultivation of clover, alfalfa, soy beans and other legumes is one of the best ways of building up and maintaining soil fertility in so far as the nitrogen is concerned. The technical name of these bacteria is Rhizobium leguminosarum.

There are also types of “free-living,” as distinguished from these symbiotic, bacteria which absorb the free nitrogen of the air and aid materially in keeping up this supply under natural conditions. One of the most important of these types is the aërobic “Azotobacter” (Fig. 76), while another is the anaërobic Clostridium pasteurianum. The nitrogen which is absorbed is built up into the protein material of the cell body and this latter must in all probability be “worked over” by various types of decomposition bacteria and by the nitrous and nitric organisms and be converted into utilizable nitrates just as other protein material is, as has been discussed in Chapter X. At any rate there is as yet no definite knowledge of any other method of transformation. Up to the present no intentional practical utilization of this valuable property of these free-living forms has been made.
Nitrogen Nutrition of Green Plants.—It is the belief of botanists that green plants obtain their nitrogen chiefly in the form of nitrates, though ammonium salts may be utilized to some extent by certain plants at least. Exceptions to this general rule are those plants provided with root tubercles (and the bog plants and others which have mycorrhiza?). These plants obtain their nitrogen in the form of organic compounds made for them by the bacteria growing in the tubercles. That nitrogen circulates throughout the structure of plants in organic combination is certain. There does not appear to be any reason why similar compounds which are soluble and diffusible (amino-acids?) should not be taken up through the roots of plants and utilized as such. It seems to the author that this is very probably the case. Arguments in favor of this view are: (1) The nitrogen nutrition of leguminous and other plants with root nodules. (2) The close symbiosis between “Azotobacter” and similar nitrogen-absorbing bacteria and many species of algæ in sea water at least. (3) The vigorous growth of plants in soils very rich in organic matter, which inhibits the production of nitrates by the nitrous-nitric bacteria when grown in culture, and possibly (?) in the soil, so that nitrates may not account for the vigorous growth. (4) The effect of nitrate fertilizers is to add an amount of nitrogen to the crop much in excess of the amount added as nitrate. (5) The most fertile soils contain the largest numbers of bacteria. The doctrine that nitrates furnish the only nitrogen to plants was established before the activities of bacteria in the soil were suspected, and, so far as the author is aware, has not been supported by experiments under conditions rigidly controlled as to sterility.
It would seem that one of the chief functions of soil bacteria is to prepare soluble organic compounds of nitrogen for the use of green plants and thus to make a “short cut” in the nitrogen cycle (p. 107), as now believed in, direct from the “decomposition bacteria” to green plants.
Experiments have been made by different observers in growing seedling plants of various kinds in water culture with one or in some cases several of the amino-acids as sources of nitrogen. Most of these experiments were disappointing. Plant proteins are not so different from animal proteins, or plant protoplasm (apart from the chlorophyl portions of plants) from animal protoplasm as to lead one to suppose that it could be built up from one or two amino-acids any more than animal protoplasm can. The author is strongly convinced that this subject should be thoroughly investigated. It will require careful experimentation and perhaps rather large funds to provide the amounts of amino-acids that would probably be needed, but might result in a decided change in our ideas of soil fertility, and especially in the use of nitrogen fertilizers.
Most of the physiological activities of bacteria which have been discussed are due to the action of these peculiar substances, so that a knowledge of their properties is essential. This knowledge cannot as yet be exact because no enzyme has, up to the present, been obtained in a “pure state,” though it must be admitted that there are no certain criteria which will enable this “pure state” to be recognized. It was formerly thought that they were protein in nature, but very “pure” and active enzymes have been prepared which did not give the characteristic protein reactions, so this idea must be abandoned. That they are large moleculed colloidal substances closely related to the proteins in many respects must still be maintained. There are certain characteristics which belong to enzymes, though no one of them exclusively. These may be enumerated as follows:
1. Enzymes are dead organic chemical substances.
Dead is used in the sense of non-living, never having lived, not in the sense of “ceased to be alive.”
2. They are always produced by living cells:
Sometimes as active enzymes, sometimes as pro-enzymes or zymogens which are converted into enzymes outside the cell by acids, other inorganic substances or other enzymes.
3. They produce very great chemical changes without themselves being appreciably affected.
Enzymes will not continue to act indefinitely, but are used up in the process (combination with products?). The amount of change is so great in proportion to the amount of enzyme that the above statement is justified in the relative sense. Thus a milk-curdling enzyme has been prepared that would precipitate 100,000,000 times its own weight of caseinogen.
4. Their action is specific in that each enzyme acts on one kind of chemical substance only, and the products are always the same.
The substance may be combined with a variety of other chemical substances so that the action appears to be on several, but in reality it is on a definite group of molecules in each instance. For example, emulsin attacks several different glucosides but always sets free dextrose from them.
5. The action is inhibited and eventually stopped, and in some cases the enzyme is destroyed by an accumulation of the products of the action. If the products are removed, the action will continue, if the enzyme is not destroyed. This effect is explained partly because the enzyme probably combines with some of the products, since it does not act indefinitely, and partly because of the reversibility of the reaction.
6. Like many chemical reactions those of enzymes are reversible, that is, the substance broken up may be reformed by it from the products produced in many instances. Thus:
7. The presence of certain mineral salts seems to be essential for their action. These and other substances which are necessary are sometimes called co-enzymes. A salt of calcium is most favorable for a great many.
8. They may be adsorbed like other colloids by “shaking out” with finely divided suspensions like charcoal or kaolin, or by other colloids like aluminum hydroxide or proteins.
9. When properly introduced into the tissues or blood of an animal, they cause the body cells to form anti-enzymes which will prevent the action of the enzyme (see Chapter XXVII).
10. Though inert, they show many of the characteristics of living organisms, that is
(a) Each enzyme has an optimum, a maximum and a minimum temperature for its action.
All chemical reactions have such temperature limits, the distinction is that for enzymes as for living substance the range is relatively narrow.
(b) High temperatures destroy enzymes. All in water are destroyed by boiling in time and most at temperatures considerably below the boiling-point. When dry, many will withstand a higher degree of heat than 100° before they are destroyed.
(c) Temperatures below the minimum stop their action, though they are not destroyed by cold.
(d) Many poisons and chemical disinfectants (Chapter XIV) which kill living organisms will also stop the action of enzymes, though generally more of the substance is required, so that it is possible to destroy the living cells by such means and yet the action of the enzyme will continue.
(e) Most enzymes have an optimum reaction of medium either acid, alkaline or neutral, depending on the particular enzyme, though some few seem to act equally well within a considerable range on either side of the neutral point.
The final test for an enzyme is the chemical change it brings about in the specific substance acted on.
The most prominent characteristic of enzymes is that they bring about very great chemical changes without themselves being appreciably affected. This property is also shown by many inorganic substances which are spoken of as “catalytic agents” or “catalyzers” so that enzymes are sometimes called “organic catalyzers.” The function of catalytic agents seems to be to hasten the rate of a reaction which would occur spontaneously, though in a great many cases with extreme slowness.
Just how enzymes act is not certain and probably will not be until their composition and constitution are known. Most probably they form a combination with the substance acted on (the substrate) as a result of which there is a rearrangement of the atoms in such a way that new compounds are formed, nearly always at least two, and the enzyme is at the same time set free. It is rather remarkable that chiefly optically active substances are split up by enzymes and where two modifications exist it is usually the dextro-rotatory one which is attacked. No single enzyme attacks both. This probably means that the structure of the enzyme corresponds to that of the substrate, “fits it as a key fits a lock,” as Emil Fischer says.
The production of enzymes is by no means restricted to bacteria since all kinds of living cells that have been investigated have been shown to produce them and presumably all living cells do. Hence the number of different kinds of enzymes and of substances acted upon is practically unlimited. Nevertheless they may be grouped into a comparatively few classes based on the general character of the change brought about by them.
I. Class I is the so-called “splitting” enzymes whose action is for the most part hydrolytic, that is, the substance takes up water and then splits into compounds that were apparently constituents of the original molecule. As examples may be mentioned diastase, the enzyme first discovered, which changes starch into a malt-sugar, hence is more commonly called amylase16 (starch-splitting enzyme); invertase,16 which splits cane-sugar into dextrose and levulose: C12H22O11 + H2O = C6H12O6 + C6H12O6. Lipase16 or a fat-splitting enzyme, which decomposes fat into glycerin and fatty acid:
Proteases, which split up proteins into proteoses and peptones.
Other classes of “splitting enzymes” break up the products of complex protein decomposition, such as proteoses, peptones and amino-acids. A variety of the “splitting enzymes” is the group of
“Coagulases” or coagulating enzymes as the rennet (lab, chymosin) which curdles milk; fibrin ferment (thrombin, thrombase) which causes the coagulation of blood. These apparently act by splitting up a substance in the fluids mentioned, after which splitting one of the new products formed combines with other compounds present (usually a mineral salt, and in the cases mentioned a calcium salt) to form an insoluble compound, the curd or coagulum.
Another variety is the “activating” enzymes or “kinases” such as the enterokinase of the intestine. The action here is a splitting of the zymogen or mother substance or form in which the enzyme is built up by the cell so as to liberate the active enzyme.
Of a character quite distinct, from the splitting enzymes are
II. The zymases. Their action seems to be to cause a “shifting on rearrangement of the carbon atoms” so that new compounds are formed which are not assumed to have been constituents of the original molecule. Most commonly there is a closer combination of the carbon and oxygen atoms, frequently even the formation of CO2 so that considerable energy is thus liberated. Examples are the zymase or alcoholase of yeast which converts sugar into alcohol and carbon dioxide; C6H12O6 = 2C2H6O + 2CO2: also urease, which causes the change of urea into ammonia and carbon dioxide. Another common zymase is the lactacidase in lactic acid fermentation.
III. Oxidizing enzymes also play an important part in many of the activities of higher plants and animals. Among the bacteria this action is illustrated by the formation of nitrites, nitrates and sulphates and the oxidation of alcohol to acetic acid as already described.
IV. Reducing enzymes occur in many of the dentrifying bacteria and in those which liberate H2S from sulphates. A very widely distributed reducing enzyme is “catalase” which decomposes hydrogen peroxide.
As previously stated, most of the physiological activities of bacteria are due to the enzymes that they produce. It is evident that for action to occur on substances which do not diffuse into the bacterial cell—starches, cellulose, complex proteins, gelatin—the enzymes must pass out of the bacterium and consequently may be found in the surrounding medium. Substances like sugars, peptones, alcohol, which are readily diffusible, may be acted on by enzymes retained within the cell body. In the former case the enzymes are spoken of as extra-cellular or “exo-enzymes,” and in the latter as intra-cellular or “endo-enzymes.” The endo-enzymes and doubtless also the exo-enzymes may after the death of the cell digest the contents to a greater or less extent and thus furnish substances that are not otherwise obtainable. This process of “self-digestion” is known technically as “autolysis.”
A distinction was formerly made between “organized” and “unorganized ferments.” The former term was applied to the minute living organisms, bacteria, yeasts, molds, etc., which bring about characteristic fermentative changes, while the latter term was restricted to enzymes as just described. Since investigation has shown that the changes ascribed to the “organized ferments” are really due to their enzymes, and that enzymes are probably formed by all living cells, the distinction is scarcely necessary at present.
The injurious effects of pathogenic bacteria are due in large part to the action of these substances, which in many respects bear a close relationship to enzymes. The chemical composition is unknown since no toxin has been prepared “pure” as yet. It was formerly thought that they were protein in character, but very pure toxins have been prepared which failed to show the characteristic protein reactions. It is well established that they are complex substances, of rather large molecule and are precipitated by many of the reagents which precipitate proteins. Toxins will be further discussed in Chapter XXVII. It will be sufficient at this point to enumerate their chief peculiarities in order to show their marked resemblance to enzymes.
1. Toxins are dead organic chemical substances.
2. They are always produced by living cells.
3. They are active poisons in very small quantities.17
4. Their action is specific in that each toxin acts on a particular kind of cell. The fact that a so-called toxin acts on several different kinds of cells, possibly indicates a mixture of several toxins, or action on the same substance in the cells.
5. Toxins are very sensitive to the action of injurious agencies such as heat, light, etc., and in about the same measure that enzymes are, though as a rule they are somewhat more sensitive or “labile.”
6. Toxins apparently have maxima, optima, and minima of temperature for their action, as shown by the destructive effect of heat and by the fact that a frog injected with tetanus toxin and kept at 20° shows no indication of poison, but if the temperature is raised to 37°, symptoms of poisoning are soon apparent. Cold, however, does not destroy a toxin.
7. When properly introduced into the tissues of animals they cause the body cells to form antitoxins (Chapter XXVII) which are capable of preventing the action of the toxin in question.
8. The determining test for a toxin is its action on a living cell.
It is true that enzymes are toxic, as are also various foreign proteins, when injected into an animal, but in much larger doses than are toxins.
A marked difference between enzymes and toxins is that the former may bring about a very great chemical change and still may be recovered from the mixture of substances acted on and produced, while the toxin seems to be permanently used up in its toxic action and cannot be so recovered. Toxins seem very much like enzymes whose action is restricted to living cells.
Just as enzymes are probably produced by all kinds of cells and not by bacteria alone, so toxins are produced by other organisms. Among toxins which have been carefully studied are ricin, the poison of the castor oil plant (Ricinus communis); abrin of the jequirity bean (Abrus precatorius); robin of the common locust (Robinia pseudacacia); poisons of spiders, scorpions, bees, fish, snakes and salamanders.
It has been stated that some enzymes are thrown out from the cell and others are retained within the cell. The same is true of toxins, hence we speak of exo-toxins or toxins excreted from, and endo-toxins or toxins retained within the cell. Among the pathogenic bacteria there are very few which secrete toxins when growing outside the body. Clostridium tetani or lockjaw bacillus, Corynebacterium diphtheriæ or the diphtheria bacillus, Clostridium botulinum or a bacillus causing a type of food poisoning, Pseudomonas pyocyanea or the blue pus bacillus are the most important. Other pathogenic bacteria do not secrete their toxins under the above conditions, but only give them up when the cell is disintegrated either within or outside the body. For the reason that endotoxins are therefore difficult to obtain, their characteristics have not been much studied. The description of toxins as above given is intended to apply to the exo-toxins of bacteria, sometimes spoken of as true toxins, and to the vegetable toxins (phytotoxins) which resemble them.
The snake venoms and probably most of the animal toxins (zoötoxins) are very different substances. (See Chapter XXIX.)
This subject belongs properly in special pathogenic bacteriology. It will be sufficient to indicate that bacteria may cause disease in one or more of the following ways: (a) blocking circulatory vessels, either blood or lymph, directly or indirectly; (b) destruction of tissue; (c) production of non-specific poisons (ptomaines, bases, nitrites, acids, gases, etc.); (d) production of specific poisons (toxins).
Bacteria cause the formation of specific “antibodies” when properly introduced into animals. This must be considered as a physiological activity since it is by means of substances produced within the bacterial cell that the body cells of animals are stimulated to form antibodies. (See Chapters XXVI–XXIX.)
The reaction of bacteria to various stains is dependent on their physico-chemical structure and hence is a result of physiological processes, but is best discussed separately (Chapter XIX).
The same is true of the appearance and growth on different culture media. (Chapter XX.)
The discussion of the physiology of bacteria in the preceding chapters has shown that a number of environmental factors must be properly correlated in order that a given organism may thrive. Conversely, it can be stated that any one of these environmental factors may be so varied that the organism will be more or less injured, may even be destroyed by such variation. It has been the thorough study of the above-mentioned relationships which has led to practical methods for destroying bacteria, for removing them or preventing their growth when such procedures become necessary.
The process of killing all the living organisms or of removing them completely is spoken of as disinfection or as sterilization, according to circumstances. Thus the latter term is applied largely in the laboratory, while the former more generally in practice outside the laboratory. So also disinfection is most commonly done with chemical agents and sterilization by physical means, though exceptions are numerous. The original idea of disinfection was the destruction of “infective” organisms, that is, organisms producing disease in man or animals. A wider knowledge of bacteriology has led to the application of the term to the destruction of other organisms as well. Thus the cheese-maker “disinfects” his curing rooms to prevent abnormal ripening of cheese, and the dairy-worker “disinfects” his premises to avoid bad flavors, abnormal changes in the butter or milk. Sterilization is more commonly applied to relatively small objects and disinfection to larger ones. Thus in the laboratory, instruments, glassware, apparatus, etc., are “sterilized” while desks, walls and floors are “disinfected.” The surgeon “sterilizes” his instruments, but “disinfects” his operating table and room. The dairy-workers mentioned above sterilize their apparatus, pails, milk bottles, etc. Evidently the object of the two processes is the same, removing or destroying living organisms, the name to be applied is largely a question of usage and circumstances. Any agent which is used to destroy microörganisms is called a “disinfectant.” Material freed from living organisms is “sterile.”
The process of preventing the growth of organisms without reference to whether they are killed or removed is spoken of as “antisepsis,” and the agent as an antiseptic. Hence a mildly applied “disinfectant” becomes an “antiseptic,” though it does not necessarily follow that an “antiseptic” may become a disinfectant when used abundantly. Thus strong sugar solutions prevent the development of many organisms, though they do not necessarily kill them.
Asepsis is a term which is restricted almost entirely to surgical operations and implies the taking of such precautions that foreign organisms are kept out of the field of operation. Such an operation is an aseptic one, or performed aseptically.
A “deodorant or deodorizer” is used to destroy or remove an odor and does not necessarily have either antiseptic or disinfectant properties.
The agents which are used for the above-described processes may be conveniently divided into physical agents and chemical agents.
1. Drying.—This is doubtless the oldest method for preventing the growth of organisms, and the one which is used on the greatest amount of material at the present time. A very large percentage of commercial products is preserved and transported intact because the substances are kept free from moisture. In the laboratory many materials which are used as food for bacteria (see Chapter XVI) “keep” because they are dry. Nevertheless, drying should be considered as an antiseptic rather than as a disinfectant process. While it is true that the complete removal of water would result in the death of all organisms this necessitates a high temperature, in itself destructive, and does not occur in practice. Further, though many pathogenic bacteria are killed by drying, many more, including the spore formers, are not. Hence drying alone is not a practical method of disinfecting.

2. Heat.—The use of heat in some form is one of the very best means for destroying bacteria. It may be made use of by combustion, or burning, as direct exposure to the open flame, as dry heat (hot air), or as moist heat (boiling water or steam). Very frequently in veterinary practice, especially in the country, occasionally under other conditions, the infected material is best burned. This method is thoroughly effective and frequently the cheapest in the end. Wherever there are no valid objections it should be used. Exposure to the open flame is largely a laboratory procedure to sterilize small metallic instruments and even small pieces of glassware. It is an excellent procedure in postmortem examinations to burn off the surface of the body or of an organ when it is desired to obtain bacteria from the interior free from contamination with surface organisms.
Dry Heat.—Dry heat is not nearly so effective as moist heat as a sterilizing agent. The temperature must be higher and continued longer to accomplish the same result. Thus a dry heat of 150° for thirty minutes is no more efficient than steam under pressure at 115° for fifteen minutes. Various forms of hot-air sterilizers are made for laboratory purposes (Fig. 77). On account of the greater length of time required for sterilization their use is more and more restricted to objects which must be used dry, as in blood and serum work, for example. In practice the use of hot air in disinfecting plants is now largely restricted to objects which might be injured by steam, as leather goods, furs, and certain articles of furniture, but even here chemical agents are more frequently used.
Moist Heat.—Moist heat may be applied either by boiling in water or by the use of steam at air pressure, or, for rapid work and on substances that would not be injured, by steam under pressure. Boiling is perhaps the best household method for disinfecting all material which can be so treated. The method is simple, can always be made use of, and is universally understood. It must be remembered that all pathogenic organisms, even their spores, are destroyed by a few minutes’ boiling. The process may be applied to more resistant organisms, such as are met with in canning vegetables, though the boiling must be continued for several hours, or what is better, repeated on several different days. This latter process, known as “discontinuous sterilization,” or “tyndallization,” must also be applied to substances which would be injured or changed in composition by too long-continued heating, such as gelatin, milk, and certain sugars. In the laboratory such materials are boiled or subjected to steaming steam for half an hour on each of three successive days. In canning vegetables the boiling should be from one to two hours each day. The principle involved is that the first boiling destroys the growing cells, but not all spores. Some of the latter germinate by the next day and are then killed by the second boiling and the remainder develop and are killed on the third day. Occasionally a fourth boiling is necessary. It is also true that repeated heating and cooling is more destructive to bacteria than continuous heating for the same length of time, but the development of the spores is the more important factor. Discontinuous heating may also be used at temperatures below the boiling-point for the sterilization of fluids like blood serum which would be coagulated by boiling. In this case the material is heated at 55° to 56° for one hour, but on each of seven to ten successive days. The intermittent heating and cooling is of the same importance as the development of the spores in this case. (Better results are secured with such substances by collecting them aseptically in the first place.)



Steam.—Steam is one of the most commonly employed agents for sterilization and disinfection. It is used either as “streaming steam” at air pressure or confined under pressure so that the temperature is raised. For almost all purposes where boiling is applicable streaming steam may be substituted. It is just as efficient and frequently more easily applied. The principle of the numerous forms of “steam sterilizers” (Fig. 78) is essentially the same. There is a receptacle for a relatively small quantity of water and means for conducting the steam generated by boiling this water to the objects to be treated, which are usually placed immediately above the water. Surgical instruments may be most conveniently sterilized by boiling or by steaming in especially constructed instrument sterilizers. If boiled, the addition of carbonate of soda, about 1 per cent., usually prevents injury.

Steam under pressure affords a much more rapid and certain method of destroying organisms. Fifteen to twenty pounds pressure corresponding to temperatures of 121° to 125° is commonly used. Variations depend on the bulk and nature of the material. Apparatus for this purpose may now be obtained from sizes as small as one or two gallons up to huge structures which will take one or two truckloads of material (Figs. 79–91). The latter type is in common use in canning factories, dairy plants, hospitals, public institutions, municipal and governmental disinfecting stations. Very frequently there is an apparatus attached for producing a vacuum, both to exhaust the air before sterilizing, so that the steam penetrates much more quickly and thoroughly and for removing the vapor after sterilizing, thus hastening the drying out of the material disinfected.

The smaller types of pressure sterilizers are called “autoclaves” and have become indispensable in laboratory work. Fifteen pounds pressure maintained for fifteen minutes is commonly sufficient for a few small objects. For larger masses much longer time is needed. The author found that in an autoclave of the type shown in Fig. 81 it required ten minutes for 500 cc. of water at 15 pounds pressure to reach a temperature of 100°, starting at room temperatures, 20° to 25°. Autoclaves may be used as simple steam sterilizers by leaving the escape valves open so that the steam is not confined, hence they have largely replaced the latter.18



A process closely akin to sterilization by heat is pasteurization. This means the heating of material at a temperature and for a time which will destroy the actively growing bacteria but not the spores. The methods for doing this vary but are essentially two in principle. 1. The material in small quantities in suitable containers (bottles) is placed in the apparatus; the temperature is raised to 60° to 65° and maintained for twenty to thirty minutes and then the whole is cooled (beer, wine, grape juice, bottled milk) (Figs. 92, 93 and 94).








2. Pasteurizing machines are used and the fluid flows through continuously. In one type the temperature is raised to 60° and by “retarders” is kept at this temperature for twenty to thirty minutes (Figs. 95 to 98). In another type the temperature is raised to as high as 85° for a few seconds only, “flash process” (Fig. 99), and then the material is rapidly cooled. It is certain that all pathogenic microörganisms, except the very few spore formers in that stage, are killed by proper pasteurization. The process is largely employed in the fermentation and dairy industries.





3. Cold.—That cold is an excellent antiseptic is illustrated by the general use of refrigerators and “cold storage.” Numerous experiments have shown that although many pathogenic organisms of a given kind are killed by temperatures below freezing, not all of the same kind are, and many kinds are only slightly affected. Hence cold cannot be considered a practical means for disinfection.

4. Light.—It has been stated (p. 75) that light is destructive to bacteria, and the advisability of having well-lighted habitations for men and animals has been mentioned. The practice of “sunning” bedclothing, hangings and other large articles which can scarcely be disinfected in a more convenient way is the usual method of employing this agent. Drying and the action of the oxygen of the air assist the process to some extent. Undoubtedly large numbers of pathogenic organisms are destroyed under natural conditions by the combined effects of drying, direct sunlight and oxidation, but it should not be forgotten that a very slight protection will prevent the action of light (Figs. 100 and 101).

5. Osmotic Pressure.—Increase in the concentration of substances in solution is in practical use as an antiseptic procedure. Various kinds of “sugar preserves,” salt meats and condensed milk are illustrations. It must be remembered that a similar increase in concentration occurs when many substances are dried, and is probably as valuable in the preservative action as the loss of water. That the process cannot be depended on to kill even pathogenic organisms is shown by finding living tubercle bacilli in condensed milk. The placing of bacteria in water or in salt solution in order to have them die and disintegrate (greatly aided by vigorous shaking in a shaking machine) (“autolysis,” p. 126) is a laboratory procedure to obtain cell constituents. It is not a practical method of disinfection, however.

6. Electricity.—Electricity, though not in itself injurious to bacteria, is used as an indirect means for destroying bacteria in a practical way. This is done by electrical production of some substance which is destructive to bacteria as in ozone water purification (Petrograd, Florence, and elsewhere), or the use of ultra-violet rays for the same purpose (Marseilles, Paris) and for treatment of certain disease conditions. Electricity might be used as a source of heat for disinfecting purposes should its cheapness justify it. It has also been used in the preservation of meats to hasten the penetration of the salt and thus reduce the time of pickling. Electrolyzed sea water has been tried as a means of flushing and disinfecting streets, but it is very doubtful if the added expense is justified by any increased benefit. A number of electric devices have been put forth for various sterilizing and disinfecting purposes and doubtless will continue to be, but everyone should be carefully tested before money is invested in it.19




7. Filtration.—Filtration is a process for rendering fluids sterile by passing them through some material which will hold back the bacteria. It is used on a large scale in the purification of water for sanitary or manufacturing reasons (Fig. 103). Air is also rendered “germ free” in some surgical operating rooms, “serum laboratories” and breweries by filtration. In the laboratory it is a very common method of sterilizing liquids which would be injured by any other process. The apparatus consists of a porous cylinder with proper devices for causing the liquid to pass through either by suction (Fig. 104) where the pressure will be only one atmosphere (approximately 15 pounds per square inch), or by the use of compressed air at any desired pressure (Fig. 105). The two main types of porous cylinders (“filter candles,” “bougies”) are the Pasteur-Chamberland (Fig. 106) and the Berkefeld. The former are made of unglazed porcelain of different degrees of fineness, the latter of diatomaceous earth (Fig. 107) The Mandler filter of this same material is now manufactured in the United States and is equal if not superior to the Berkefeld. The designs of complete apparatus are numerous.

8. Burying.—This is a time-honored method of disposing of infected material of all kinds and at first thought might not be considered a means of disinfection. As a matter of fact, under favorable conditions it is an excellent method. The infected material is removed. Pathogenic organisms tend to die out in the soil owing to an unfavorable environment as to temperature and food supply, competition with natural soil organisms for what food there is, and the injurious effects of the products of these organisms. Care must be taken that the burial is done in such a way that the surface soil is not contaminated either directly or by material brought up from below by digging or burrowing animals, insects, worms, or movement of ground water to the surface. Also that the underground water supply which is drawn upon for use by men or animals is not contaminated. Frequently infected material, carcasses of animals, etc., are treated in some way so as to aid the natural process of destruction of the organisms present, especially by the use of certain chemical agents, as quicklime (see p. 158).

A very large number of chemical substances might be used for destroying bacteria or preventing their growth either through direct injurious action or by the effect of concentration. Those which are practically useful are relatively few, though this is one of the commonest methods of disinfecting and the word “disinfectant” is frequently wrongly restricted to chemical agents.
Chemical agents act on bacteria in a variety of ways. Most commonly there is direct union of the chemical with the protoplasm of the cell and consequent injury. Some times the chemical is first precipitated on the surface of the cell without penetrating at once. If removed soon enough, the organism is not destroyed. This is true of bichloride of mercury and formaldehyde. If bacteria treated with these agents in injurious strength be washed with ammonia or ammonium sulphate, even after a time which would otherwise result in their failure to grow, they will develop. Some chemicals change the reaction of the material in a direction unfavorable to growth, and if the change is enough, may even kill the bacteria. Some agents remove a chemical substance necessary to the growth of the organism and hence inhibit it. Such actions are mainly preventive (antiseptic) and become disinfectant only after a long time.
Oxygen.—Oxygen as it occurs in the air is probably not injurious to living bacteria but aids them with the exception of the anaërobes. In the nascent state especially as liberated from ozone (O3) hydrogen peroxide (H2O2) and hypochlorites (Ca(ClO)2) it is strongly bactericidal.
Chlorine.—Chlorine is actively disinfectant and is coming into use for sterilizing water on a large scale in municipal plants (Fig. 108).

Iodine finds extended use in aseptic surgical operations and antiseptic dressings. Bromine, mercury, silver, gold, nickel, zinc and copper are markedly germicidal in the elemental state but are not practical.
Calcium Oxide.—Calcium oxide (CaO), quick lime, is an excellent disinfectant for stables, yards, outhouses, etc., where it is used in the freshly slaked condition as “white wash;” also to disinfect carcasses to be buried. It is very efficient against the typhoid bacillus in water, where it is much used to assist in the softening.
Chloride of Lime.—Chloride of lime, bleaching powder, which consists of calcium hypochlorite, the active agent, and chloride and some unchanged quicklime is one of the most useful disinfectants. It is employed to sterilize water for drinking purposes on a large scale and to disinfect sewage plant effluents. A 5 per cent. solution is the proper strength for ordinary disinfection. Only a supply which is fresh or has been kept in air-tight containers should be used, as it rapidly loses strength on exposure to the air. The active agent is nascent oxygen liberated from the decomposition of the hypochlorite.
Sodium Hypochlorite.—Sodium hypochlorite prepared by the electrolysis of common salt has been used to some extent.
Bichloride of Mercury.—Bichloride of mercury, mercuric chloride, corrosive sublimate (HgCl2), is the strongest of all disinfectants under proper conditions. It is also extremely poisonous to men and animals and great care is necessary in its use. It is precipitated by albuminous substances and attacks metallic objects, hence should not be used in the presence of these classes of substances.
It is used in a strength of one part HgCl2 to 1000 of water for general disinfection. Ammonium chloride or sodium chloride, common salt, in quantities equal to the bichloride, or citric acid in one-half of the amount should be added in making large quantities of solution or for use with albuminous fluids to prevent precipitation of the mercury (Fig. 109).
None of the other metallic salts are of value as practical disinfectants aside from their use in surgical practice. In this latter class come boric acid, silver nitrate, potassium permanganate. The strong mineral acids and alkalies are, of course, destructive to bacteria, but their corrosive effect excludes them from practical use, except that “lye washes” are of value in cleaning floors and rough wood-work, but even here better disinfection can be done more easily and safely.

Carbolic Acid or Phenol.—Carbolic acid or phenol (C6H5 OH) is one of the commonest agents in this class. It is used mostly in 5 per cent. solution as a disinfectant and in 0.5 per cent. solution as an antiseptic. For use in large quantities the crude is much cheaper and, according to some experimenters, even more active than the pure acid, owing to the cresols it contains. The crude acid is commonly mixed with an equal volume of commercial sulphuric acid and the mixture is added to enough water to make a 5 per cent. dilution, which is stronger than either of the ingredients alone in 5 per cent. solution.
Cresols.—The cresols (C6H4CH3OH, ortho, meta and para), coal-tar derivatives, as phenol, are apparently more powerful disinfectants. A great number of preparations containing them have been put on the market. Creolin is one which is very much used in veterinary practice and forms a milky fluid with water, while lysol forms a clear frothy liquid owing to the presence of soap. Both of these appear to be more active than carbolic acid and are less poisonous and more agreeable to use. They are used in 2 to 5 per cent. solution.
Alcohol.—Ordinary (ethyl) alcohol (C2H5OH) is largely used as a preservative, also as a disinfectant for the body surface, hands, and arms. Experiments show that alcohol of 70 per cent. strength is most strongly bactericidal and that absolute alcohol is very slightly so.
Soap.—Experimenters have obtained many conflicting results with soaps when tested on different organisms, as is to be expected from the great variations in this article. Miss Vera McCoy in the author’s laboratory carried out experiments with nine commercial soaps—Ivory, Naphtha, Packer’s Tar, Grandpa’s Tar, Balsam Peru, A. D. S. Carbolic, German Green, Dutch Cleanser, Sapolio—and obtained abundant growth from spores of Bacillus anthracis, from Bacterium coli and from Staphylococcus pyogenes aureus in all cases even when the organisms had been exposed twenty-four hours in 5 per cent. solutions. From these results and from the wide variations reported in the literature it is clear that soap solutions alone cannot be depended on as disinfectants. Medicated soaps do not appear to offer any advantages in this respect. The amount of the disinfectant which goes into solution when the soap is dissolved is too small to have any effect.
Formaldehyde.—Formaldehyde (HCHO) is perhaps the most largely used chemical disinfectant at the present time. The substance is a gas but occurs most commonly in commerce as a watery solution containing approximately 40 per cent. of the gas. This solution is variously known as formalin, formol, and formaldehyde solution. The first two names are patented and the substance under these names usually costs more. It is used in the gaseous form for disinfecting closed spaces of all kinds to the exclusion of most other means today. A great many types of formalin generators have been devised. The gas has little power of penetration and all material to be reached should be exposed as much as possible. The dry gas is almost ineffective, so that the objects must be moistened or vapor generated along with the gas. A common method in use is to avoid expensive generators by pouring the formaldehyde solution on permanganate of potash crystals placed in a vessel removed from inflammable objects on account of the heat developed which occasionally sets the gas on fire. The formalin is used in amounts varying from 20 to 32 ounces to 8½ to 13 ounces of permanganate to each 1000 cubic feet of space. This method is expensive since one pint (16 ounces) of formalin is sufficient for each 1000 cubic feet, and since the permanganate is an added expense. Dr. Dixon, Commissioner of Health of Pennsylvania, recommends the following mixture to replace the permanganate, claiming that it works more rapidly and is less expensive and just as efficient:
Two and three are mixed together and when cool are poured on the bichromate which is placed in an earthenware jar of a volume about ten times the quantity of fluid used. The quantities given are for each 1000 cubic feet of space.
A very simple method is to cause the formalin, diluted about twice with water to furnish moisture enough, to drop by means of a regulated “separator funnel” on a heated iron plate. The dropping should be so regulated that each drop is vaporized as it falls. The plate must have raised edges, pan-shaped, to prevent the drops rolling off when they first strike the plate. Formaldehyde has no corrosive (except on iron) or bleaching action, and is the most nearly ideal closed space disinfectant today. In disinfecting stations it is made use of in closed sterilizers such as were described under steam disinfection particularly in connection with vacuum apparatus. It is also used in solution as a preservative and as a disinfectant. The commonest strength is 2 or 3 per cent. of formalin or 0.8 to 1.2 per cent. of the formaldehyde gas. As an antiseptic it is efficient in dilutions as high as 1 to 2000 of the gas. It is very irritant to mucous membranes of most individuals.
Anilin Dyes.—Some of the anilin dyes show remarkable selective disinfectant and antiseptic action on certain kinds of bacteria with little effect on others. This has been well shown by Churchman in his work on Gentian Violet. This dye inhibits the growth of Gram positive organisms up to a dilution of one part in 300,000 while for Gram negative organisms it is without effect even in saturated solution. This is nicely shown in the accompanying illustration. This inhibiting effect of anilin dyes is taken advantage of in several methods of isolating bacteria (Chapter XVIII).

In addition to the above-discussed disinfectants a large number of substances, particularly organic, are used in medicine, surgery, dentistry, etc., as more or less strong antiseptics, and the list is a constantly lengthening one.
In the laboratory chloroform, H2O2, ether and other volatile or easily decomposable substances have been used to sterilize liquids which could not be treated by heat or by filtration. The agent is removed either by slow evaporation or by exhausting the fluid with an air pump. The method is not very satisfactory, nor is absolute sterilization easily accomplished. It is much better to secure such liquids aseptically where possible.
The choice of the above-described agents depends on the conditions. Evidently a barn is not to be disinfected in the same way that a test-tube in the laboratory is sterilized. Among the factors to be considered in making a choice are the thing to be disinfected or sterilized, its size and nature, that is, whether it will be injured by the process proposed, cost of the agent, especially when a large amount of material is to be treated. Among the conditions which affect the action of all agents the following should be borne in mind particularly when testing the disinfecting power of chemical agents:
1. The kind of bacterium to be destroyed, since some are more readily killed by a given disinfectant than others, even though no spores are present.
2. The age of the culture. Young bacteria less than twenty-four hours old are usually more readily killed than older ones since the cell wall is more delicate and more easily penetrated, though old growths may be weakened by the accumulation of their products and be more easily destroyed.
3. Presence of spores, since they are much more resistant than the growing cells.
4. Whether the organism is a “good” or “bad” growth, i.e., whether it has grown in a favorable environment and hence is vigorous, or under unfavorable conditions and hence is weak.
5. The number of bacteria present, since with chemical agents the action is one of relative masses.
6. Nature of the substance in which the bacteria are. Metallic salts, especially bichloride of mercury, are precipitated by albuminous substances and if employed at all must be used in several times the ordinary strength. Solids require relatively more of a given solution than liquids.
7. State of the disinfectant, whether solid, liquid or gas, and whether it is ionized or not. Solutions penetrate best and are therefore more quickly active and more efficient.
8. The solvent. Water is the best solvent to use. Strong alcohol (90 per cent. +) diminishes the effect of carbolic acid, formaldehyde and bichloride of mercury. Oil has a similar effect. The action is probably to prevent the penetration of the disinfectant.
9. Strength of solution. The stronger the solution, the more rapid and more certain the action, for the same reason as mentioned under 5. In fact, every disinfectant has a strength below the lethal at which it stimulates bacterial growth.
10. Addition of salts. Common salt favors the action of bichloride of mercury and also of carbolic acid. Other salts may hinder by precipitating the disinfectant.
11. Temperature. Chemical disinfectants, as a rule, follow the general law that chemical action increases with the temperature, up to the point where the heat of itself is sufficient to kill.
12. Time of action. It is scarcely necessary to point out that a certain length of time is necessary for any disinfectant to act. One may touch a red hot stove and not be burned. All the above-mentioned conditions are influenced by the time of action.
Many attempts have been made to devise standard methods for testing the relative strengths of disinfectants. The one most widely used in the United States is the so-called “Hygienic Laboratory” method of determining the “phenol coefficient” of the given substance and is a modification of the method originally proposed by Rideal and Walker in England. In this method as proposed by Anderson and McClintic, formerly of the above laboratory, the strengths of the dilution of the disinfectant to be tested which kills a culture of Bacterium typhosum in 2½ minutes is divided by the strength of the dilution of carbolic acid which does the same; and the dilution which kills in 15 minutes is likewise divided by the corresponding dilution of carbolic acid. The two ratios thus obtained are averaged and the result is the “phenol coefficient.” For example
| Phenol | 1:80 | killed in 2½ minutes | ||||
| Disinfectant “A” | 1:375 | killed in 2½ minutes | ||||
| Phenol | 1:110 | killed in 15 minutes | ||||
| Disinfectant “A” | 1:650 | killed in 15 minutes | ||||
| 375 | ÷ | 80 | = | 4.69 | ||
| 650 | ÷ | 110 | = | 5.91 | ||
| 2)10.60 | ||||||
| Average | = | 5.30 | = “phenol coefficient.” | |||
Standard conditions of temperature, age of culture, medium, reaction, etc., and of making the dilutions and transfers are insisted on. Details may be found in the Journal of Infectious Diseases, 1911, 8, p. 1.
This is probably as good a method as any for arriving at the relative strengths of disinfectants and in the hands of any given worker concordant results in comparative tests can usually be attained. Experience has shown that the results obtained by different workers with the same disinfectant may be decidedly at variance. This is to be expected from a knowledge of the factors affecting the action of disinfectants above stated and from the known specific action of certain disinfectants on certain organisms (compare anilin dyes, p. 162).
It seems that the only sure way to test the action of such a substance is to try it out in the way it is to be used. It is scarcely wise to adopt the “phenol coefficient” method as a legal standard method as some states have done.
The methods for sterilizing in the laboratory have been discussed and will be referred to again in the next chapter.
In practical disinfection it is a good plan always to proceed as though spores were present even if the organism is known. Hence use an abundance of the agent and apply it as long as practicable. Also it is best to secure the chemical substances used as such and not depend on patented mixtures purporting to contain them. As a rule the latter are more expensive in proportion to the results secured.
Surgical instruments may be sterilized by boiling in water for fifteen minutes, provided they are clean, as they should be. If dried blood, pus, mucus, etc., are adherent, which should never be the case, they should be boiled one-half hour. The addition of sodium carbonate (0.5 to 1 per cent.) prevents rusting. Surgeons’ sterilizers are to be had at reasonable prices and are very convenient. Whether the instruments are boiled or subjected to streaming steam depends on whether the supporting tray is covered with water or not. The author finds it a good plan to keep the needles of hypodermic syringes in a small wire basket in an oil bath. The oil may be heated to 150° to 200° and the needles sterilized in a very few minutes. The oil also prevents rusting.
Rooms, offices and all spaces which may be readily made practically gas-tight are best disinfected by means of formaldehyde by any of the methods above described (Figs. 111 and 112).
Stables and Barnyards (Mohler): “A preliminary cleaning up of all litter is advisable together with the scraping of the floor, mangers and walls of the stable with hoes and the removal of all dust and filth. All this material should be burned since it probably contains the infective agent. Heat may be applied to the surfaces, including barnyard, by means of a ‘cyclone oil burner.’ When such burning is impracticable, the walls may be disinfected with one of the following:
The same may be applied with brushes or, more rapidly, sprayed on with a pump; the surface soil of the yard and surroundings should be removed to a depth of 5 or 6 inches, placed in a heap and thoroughly mixed with quicklime. The fresh surface of soil thus exposed may be sprinkled with a solution of a chemical disinfectant as above described.


“Portions of walls and ceiling not readily accessible may be disinfected by chlorine gas liberated from chloride of lime by crude carbolic acid. This is accomplished by making a cone of 5 or 6 pounds of chloride of lime in the top of which a deep crater is made for the placement of from 1 to 2 pints of crude carbolic acid. The edge of the crater is thereupon pushed into the fluid, when a lively reaction follows. Owing to the heat generated, it is advisable to place the chloride of lime in an iron crucible (pot), and to have nothing inflammable within a radius of two feet. The number and location of these cones of chloride of lime depend on the size and structure of the building to be disinfected. As a rule it may be stated that chlorine gas liberated from the above sized cone will be sufficient for disinfecting 5200 cubic feet of air space.”
Liquid manure, leachings, etc., where collected are thoroughly disinfected by chloride of lime applied in the proportion of 2 parts to 1000 of fluid.

Vehicles may be thoroughly washed with 2 per cent. formalin solution, or if closed space is available, subjected to formaldehyde gas disinfection, after cushions, hangings, etc., have been removed and washed with the disinfectant.
Harness, brushes, combs should be washed with a solution of formalin, carbolic acid, or creolin as given under these topics.
Washable articles should be boiled, dropped into disinfectant, solutions as soon as soiled, and then boiled or steamed.
Unwashable articles—burn all possible. Use formaldehyde gas method in a closed receptacle (Fig. 113).
Stock cars—the method described for stables is applicable here.
Animals, large and small, may have the coat and surface of the body disinfected by washing with 1 to 1000 bichloride or strong hot soapsuds to which carbolic acid has been added to make a 5 per cent. solution; they should then be given a good warm bath.
Frequently time and money are saved by a combination of steam and formaldehyde disinfection. This is a regular practice in municipal and quarantine disinfection (Fig. 114).

Persons engaged in disinfection work should wear rubber boots, coats and caps which should be washed in a disinfectant solution and the change to ordinary clothing made in a special room so that no infective material will be taken away.
The study of bacteria may be taken up for the disciplinary and pedagogic value of the study of a science; with the idea of extending the limits of knowledge; or for the purpose of learning their beneficial or injurious actions with the object of taking advantage of the former and combating or preventing the latter.
Since bacteria are classed as plants, their successful study implies their cultivation on a suitable soil. A growth of bacteria is called a “culture” and the “soil” or material on which they are grown is called a “culture medium.” In so far as the culture medium is made up in the laboratory it is an “artificial culture medium” as distinguished from a natural medium. A culture consisting of one kind of bacteria only is spoken of as a “pure culture,” and accurate knowledge of bacteria depends on obtaining them in “pure culture.” After getting a “pure culture” the special characteristics of the organism must be ascertained in order to distinguish it from others. The discussion of the morphology of bacteria in Chapters II, III, and IV shows that the morphological structures are too few to separate individual kinds. They serve at best to enable groups of similarly appearing forms to be arranged. Hence any further differentiation must be based on a study of the physiology of the organism as discussed in the chapters on Physiological Activities of Bacteria.
The thorough study of a bacterium involves, therefore:
1. Its isolation in pure culture.
2. Its study with the microscope to determine morphological features and staining reactions.
3. Growth on culture media for determining its physiological activities as well as morphological characteristics of the growths themselves.
4. Animal inoculations in certain instances.
5. Special serum reactions in some cases.
Since isolation in pure culture requires material for growing the organism, the first subject to be considered is culture media.
A culture medium for a given bacterium should show the following essentials:
1. It must contain all the elements necessary for the growth of the organism except those that may be obtained from the surrounding atmosphere.
2. These elements must be in a form available to the organism.
3. The medium must not be too dry, in order to furnish sufficient moisture for growth and to prevent too great a concentration of the different ingredients.
4. The reaction must be adjusted to suit the particular organism dealt with.
5. There must be no injurious substances present in concentration sufficient to inhibit the growth of the organism or to kill it.
Ordinarily, more attention must be paid to the sources of the two elements N and C than to the others, for in general the substances used to furnish these two and the water contain the other elements in sufficient amount. For very exact work on the products of bacteria, synthetic media containing definite amounts of chemicals of known composition have been prepared, but for most of the work with bacteria pathogenic to animals such media are not needed.
Culture media may be either liquid or solid, or for certain purposes may be liquid at higher temperatures and solid at lower, as indicated later. Liquid media are of value for obtaining bacteria for the study of morphology and cell groupings and for ascertaining many of the physiological activities of the organisms. Solid media are useful for studying some few of the physiological activities and especially for determining characteristic appearances of the isolated growths of bacteria. These isolated growths of bacteria on solid media are technically spoken of as “colonies,” whether they are microscopic in size or visible to the unaided eye.
It is clear that the kinds of culture media used for the study of bacteria may be unlimited but the undergraduate student will need to use a relatively small number, which will be discussed in this section.
Meat Broth (Bouillon).20—This itself is used as a medium and as the basis for the preparation of other solid and liquid media.
Finely ground lean beef is selected because it contains the necessary food materials. Fat is not desired since it is a poor food for most bacteria and in the further processes of preparation would be melted and form an undesirable film on the surface of the medium. The meat is placed in a suitable container and mixed with about twice its weight of cold water (not distilled) and allowed to soak overnight or longer. The cold water extracts from the meat water-soluble proteins, blood, carbohydrates in the form of dextrose (occasionally some glycogen), nitrogenous extractives and some of the mineral salts. The fluid is strained or pressed free from the meat. This “meat juice” should now be thoroughly boiled, which results in a coagulation of a large part of the proteins and a precipitation of some of the mineral salts, particularly phosphates of calcium and magnesium, both of which must be filtered off and the water loss restored by adding the proper amount of distilled water. The boiling is done at this point because the medium must later be heated to sterilize it and it is best to get rid of the coagulable proteins at once. The proteins thus thrown out deprive the medium of valuable nitrogenous food material which is replaced by adding about 1 per cent. by weight of commercial peptone. It is usual also (though not always necessary) to add about 0.5 per cent. by weight of common salt which helps to restore the proper concentration of mineral ingredients lost by the boiling. The chlorine is also an essential element. The reaction is now determined and adjusted to the desired end point, “standardized,” as it is called. The medium is again thoroughly boiled and filtered boiling hot. The adjusting of the reaction and the boiling ordinarily cause a precipitate to form which is largely phosphates of the alkaline earths with some protein. The filtered medium is collected in suitable containers, flasks or tubes, which are plugged with well-fitting non-absorbent cotton plugs and sterilized, best in the autoclave for twenty minutes at 15 pounds pressure, or discontinuously in streaming steam at 100°. If careful attention is paid to titration and to sufficient boiling where indicated, the meat broth prepared as above should be clear, only faintly yellowish in color and show no precipitate on cooling.
The conventional method for standardizing an acid medium is as follows: Take 5 cc of the medium, add 45 cc of distilled water and 1 cc of phenolphthalein as indicator. Boil the solution and while still hot run in from a burette N/20 NaOH solution until a faint pink color appears. From the number of cc of N/20 NaOH used to “neutralize” the 5 cc of medium it is calculated how many cc of N/1 NaOH are necessary to give the desired end reaction to the volume of medium which is to be standardized. The resulting reaction is expressed as % acid or alkaline to phenolphthalein. If it is necessary to add to each 100 cc of the medium 1 cc of N/1 NaOH to make it neutral to phenolphthalein, the reaction is called 1% acid: if to each 100 cc of medium there is added 1 cc of N/1 alkali in addition to the quantity necessary to neutralize, the reaction is called 1% alkaline.
In order to obtain a pink color when titrating with this indicator not only must the “free acid” be neutralized by the alkali but also loosely combined acid and any other substances present which will combine with the alkali rather than with the indicator so that in many media more alkali is added than is necessary to neutralize the “free acid,” i.e., the free H ions present.
It is well established that the controlling factor in the growth of bacteria in so far as “reaction” is concerned is not the titratable substances present but only the “free acid,” i.e., the number of free H ions, consequently it is better to determine the concentration of H ions and to standardize to a definite H ion concentration. Phenolphthalein as shown above is not a good indicator for this purpose.
The H ions present can be determined accurately in all cases only by electrolytic methods. The apparatus necessary is usually relatively expensive and scarcely adapted to the use of large classes of students. There are a number of indicators each of which will show color changes within rather narrow ranges of H ion concentration. Standardization by the use of these indicators, the “colorimetric method,” is recommended by the Society of American Bacteriologists and is coming into general use.
The H ion concentration is ordinarily indicated by the conventional symbol PH, e.g., the concentration in pure water which is regarded as neutral is expressed as PH 7; of normal HCl, PH 0; of normal NaOH, PH 14. The figure after PH does not in reality represent the concentration of H ions in the solution. This, like the concentration of acids, is expressed on the basis of normality, i.e., as compared with the concentration of a normal solution (1 g. equivalent) of H ions. Concentration of H ions in pure water is N/10,000,000, i.e., is 1/10,000,000 of the concentration in a normal solution of H ions. Expressed in other words, it is the concentration in a normal solution of H ions diluted ten million times. 10,000,000 = 10 to the 7th power = 107. Hence the figure after the PH indicates the logarithm of the number of times the solution is diluted. Therefore this number increases with the dilution, and the larger the figure after the PH, the less acid the solution is.
Most saprophytic organisms and many parasitic ones grow within a wide range of H ion concentration so that titration with phenolphthalein gives sufficient accuracy for media for such organisms. On the other hand, many organisms grow within a very narrow range of H ion concentration, hence accurate standardization to a definite H ion concentration is necessary. It is also evident that for comparative work, such standardization is essential because this reaction can be reproduced in other media and by other workers.21
Broth may be prepared from Liebig’s or Armour’s meat extract by adding 5 grams of either, 10 grams peptone and 5 grams NaCl to 1000 cc of water, boiling to dissolve, then titrating and filtering as above.
The author after much experience finds meat juice preferable to meat extract for broth and other media for pathogenic bacteria, and has abandoned the use of meat extracts for these organisms.
Glycerin Broth.—Glycerin broth is made by adding 4 to 6 per cent. of glycerin to the broth just previous to the sterilization. The glycerin serves as a source of carbon to certain bacteria which will not grow on the ordinary broth—as Mycobacterium tuberculosis.
Sugar Broths.—Sugar broths are used for determining the action of bacteria on these carbohydrates, since this is a valuable means of differentiating certain forms, especially those from the intestinal tract. Broth free from sugar must first be made. This is done by adding to broth prepared as already described, just previous to final filtering and sterilization, a culture of some sugar-destroying organism (Bacterium coli is ordinarily used), and then allowing the organism to grow in the raw broth at body temperature for twenty-four hours. Any carbohydrate in the broth is destroyed by the Bacterium coli. This mixture is then boiled to kill the Bacterium coli, restandardized and then 1 per cent. by weight of required sugar is added. Dextrose, saccharose and lactose are the most used, though many others are used for special purposes. After the sugar is added the medium must be sterilized by discontinuous heating at 100° for three or four successive days, because long boiling or heating in the autoclave splits up the di- and polysaccharids into simpler sugars and may even convert the simple sugars (dextrose) into acid.
Various other modified broths are frequently used for special purposes but need not be discussed here.
Dunham’s peptone solution, frequently used to determine indol production, is a solution of 1 per cent. of peptone and 0.5 per cent. of salt in tap water. It does not need to be titrated, but should be boiled and filtered into tubes or flasks and sterilized.
Nitrate Broth.—Nitrate broth for determining nitrate reduction is 1 per cent. of peptone, 0.2 per cent. of C. P. potassium nitrate dissolved in distilled water and sterilized.
Milk.—Milk is a natural culture medium much used. It should be fresh and thoroughly skimmed, best by a separator or centrifuge to get rid of the fat. If the milk is not fresh, it should be titrated as for broth and the reaction adjusted. The milk should be sterilized discontinuously to avoid splitting up the lactose as well as action on the casein and calcium phosphate.
Litmus Milk.—Litmus milk is milk as above to which litmus has been added as an acid production indicator. The milk should show blue when the litmus is added or be made to by the addition of normal NaOH solution. It should be sterilized discontinuously. Frequently on heating litmus milk the blue color disappears due to a reduction of the litmus. This blue color will reappear on shaking with air or on standing several days, due to absorption of O and oxidation of the reduced litmus, provided the heating has produced no other change in the milk, as proper heating will not.
Gelatin Culture Medium.—Gelatin to the extent of 10 to 15 per cent. is frequently added to broth and gives a culture medium of many advantages. It is solid at temperatures up to about 25° and fluid above this temperature, a property which is of great advantage in the isolation of bacteria. (See Chapter XVIII.) Further gelatin is liquefied (that is digested, converted into gelatin proteose and gelatin peptone, which are soluble in water and do not gelatinize) by many bacteria and not by others, a valuable diagnostic feature. The gelatin colonies of many bacteria are very characteristic in appearance, as is the growth of many on gelatin in culture tubes.
Gelatin medium may be prepared by adding the proper amount of gelatin (10 to 15 per cent. by weight) broken into small pieces (powdered gelatin in the same proportion may be used) to broth, gently warming until the gelatin is dissolved, standardizing as for broth, filtering and sterilizing. It is usually cleared before filtering by stirring into the gelatin solution, cooled to below 60°, the white of an egg for each 1000 cc., and then thoroughly boiling before filtering. The coagulation of the egg albumen entangles the suspended matter so that the gelatin filters perfectly clear, though with a slight yellowish color. The filtering may be done through filter paper if the gelatin is well boiled and filtered boiling hot, but is more conveniently done through absorbent cotton, wet with boiling water.
Or, the gelatin may be added to meat juice before it is boiled, then this is heated to about body temperature (not too hot, or the proteins will be coagulated too soon) until the gelatin is dissolved. Then the material is standardized and thoroughly boiled and filtered. The proteins of the meat juice coagulate and thus clear the medium without the addition of egg white. Commercial gelatin is markedly acid from the method of manufacture, hence the medium requires careful titration, even when made from a standardized broth.
Gelatin should be sterilized by discontinuous heating at 100° on three successive days, because long boiling or heating above 100° tends to hydrolyze the gelatin into gelatin proteose and peptone and it will not gelatinize on cooling. It may be heated in the autoclave for ten to fifteen minutes at 10 pounds’ pressure and sometimes not be hydrolyzed, but the procedure is uncertain and very resistant spores may not be killed. The medium should be put into the culture tubes in which it is to be used as soon as filtered, and sterilized in these, since, if put into flasks these must be sterilized, and then when transferred to tubes for use, it must be again sterilized unless great care is taken to have the tubes plugged and sterilized first, and in transferring aseptically to these tubes. These repeated heatings are very apt to decompose the gelatin, so it will not “set” on cooling. The prepared and sterilized tubes of gelatin should be kept in an ice-box or cool room, as they will melt in overheated laboratories in summer or winter.
Agar Medium.—Agar agar, usually called agar, is a complex carbohydrate substance of unknown composition obtained from certain seaweeds along the coast of Japan and Southeastern Asia. It occurs in commerce as thin translucent strips or as a powder. It resembles gelatin only in the property its solutions have of gelatinizing when cooled. Gelatin is an albuminoid closely related to the proteins, agar a carbohydrate. Agar is much less soluble in water, 1 or 1.5 per cent. of agar giving a jelly as dense as 10 to 15 per cent. of gelatin. It dissolves only in water heated to near the boiling-point (98° to 99°) and only after much longer heating. This hot solution “jells,” “sets” or gelatinizes at about 38° and remains solid until again heated to near boiling. Hence bacteria may be grown on agar at the body temperature (37°) and above, and the agar will remain solid, while gelatin media are fluid above about 25°. No pathogenic bacteria and none of the saprophytes liable to be met with in the laboratory are able to “liquefy” agar.
An agar medium is conveniently prepared from broth by adding 1 or 1.5 per cent. of the finely divided agar to the broth and boiling until dissolved, standardizing, clearing, filtering, and sterilizing. The agar must be thoroughly boiled, usually for ten to fifteen minutes, and the water loss made up by the addition of distilled water before titration. Agar is practically neutral so that there is little difference between the titration of the dissolved agar and the original broth. The agar solution should be kept hot from the beginning to the end except the cooling down to below 60°, when the egg white for clearing is added. Though filtration through paper is possible as with gelatin, if the agar solution is thoroughly boiled and filtered boiling hot, it is more satisfactory for beginners to use absorbent cotton wet with boiling water and to pour the hot agar through the same filter if not clear the first time. The solidified agar medium is never perfectly clear, but always more or less opalescent. The agar medium may be sterilized in the autoclave for fifteen minutes at 15 pounds pressure as the high temperature does not injure the agar.
Potato Media.—Potatoes furnish a natural culture medium which is very useful for the study of many bacteria. The simplest, and for most purposes the best, way to use potatoes is in culture tubes as “potato tube cultures” (No. 8, Fig. 119). These are prepared as follows: Large tubes are used. Large healthy potatoes are selected. Each end of the potato is sliced off so as to have parallel surfaces. With a cork-borer of a size to fit the tubes used, cylinders about one and one-half inches long are made. Each cylinder is cut diagonally from base to base. This furnishes two pieces each with a circular base and an oval, sloping surface. The pieces are then washed clean and dropped for a minute into boiling water to destroy the oxidizing enzyme on the surface which would otherwise cause a darkening of the potato. (The darkening may also be prevented by keeping the freshly cut potatoes covered with clean water until ready to sterilize.) A bit of cotton one-fourth to one-half inch in depth is put into each of the test-tubes to retain moisture and a piece of potato dropped in, circular base down. The tubes are then plugged with cotton and sterilized in the autoclave at 15 pounds pressure for not less than twenty-five minutes, since potatoes usually harbor very resistant spores, and it is not unusual for a few tubes to spoil even after this thorough heating.
Potatoes are sometimes used in “potato plate cultures.” The term “plate culture” is a relic of the time when flat glass plates were used for this and other “plate cultures.” Now glass dishes of the general form shown in Fig. 115, called “Petri dishes,” or plates are used for practically all plate culture work. For “potato plates” slices from potatoes are cut as large and as thick as the relative sizes of potato and dish permit (Fig. 116). The slices should be thin enough not to touch the lid and thick enough to be firm.


It is a good plan to wrap each dish separately in paper to retain the lid securely, then sterilize as for potato tubes, and leave plates wrapped until wanted.
It sometimes happens that the natural acidity of potatoes is too great for the growth of many organisms. The acidity is sufficiently corrected by soaking the pieces of potato in a 1 per cent. solution of sodium carbonate for an hour before they are put into the tubes or plates.
Glycerinized potato tubes are conveniently prepared by covering the potato in the tube with glycerin broth, sterilizing and pouring off the excess broth immediately after sterilizing, taking care that the tubes do not become contaminated which is not very probable if the work is quickly done while the tubes are still hot.
Blood Serum Media.—Blood serum, usually from the larger, domestic animals on account of convenience in securing it in quantity, is used in the study of the bacteria causing disease in man and animals. Most commonly the serum is collected from the clotted blood after it has well separated (usually about forty-eight hours is required for this). It is then run into tubes which are plugged with cotton and placed in an apparatus for coagulating the serum by heat. A copper water bath with a tightly closed air compartment or the horizontal autoclave (Fig. 81) is sufficient for this purpose, though special forms of apparatus are to be had. It is important that the temperature be raised slowly so that the blood gases escape gradually. Three to five hours or longer should be allowed for the temperature to reach the boiling-point. If the tubes are heated too rapidly, the serum is filled with bubbles and badly torn since the gases are driven off suddenly. Löffler’s serum is made by adding one part of dextrose broth to three parts of serum and then coagulating as above. The solidified serum in either case is best sterilized discontinuously, though with care the autoclave at 15 pounds pressure may be used for a single sterilization. This is very apt to cause a greater darkening of the serum and frequently also a laceration of the solid mass by escaping gases.
Blood serum is also used in the liquid state. For this purpose it is best to collect it aseptically; or it may be sterilized discontinuously at a temperature of 55° or 56° on seven to ten consecutive days. Novy has recently suggested dialyzing the serum to free it from salts and thus prevent its coagulation when heated. Whether the removal of the various “extractives” which diffuse out with the salts deprives the serum of any of its advantageous properties remains to be ascertained.
From the discussion of the physiological activities of bacteria in Chapters IX–XII it is apparent that a very great variety of culture media other than those described is necessary for the study of special types of bacteria, but such media are beyond the scope of the present work.
The ideal culture media are without a doubt the synthetic media, that is media of definite known chemical composition, so that the various changes due to the growth of bacteria can be accurately determined and thus a means of sharply differentiating closely related organisms be secured. Such media have been prepared and every bacteriologist believes strongly in their future usefulness when media of wider application shall have been devised. An example of this type of culture media is Uschinsky’s synthetic medium, of which the following is one of the modifications:
| Distilled-water | 1000 parts |
| Asparagin | 4 parts |
| Ammonium lactate | 6 parts |
| Disodium phosphate | 2 parts |
| Sodium chloride | 5 parts |
A criticism of this medium is that the elements K, Ca, Mg, Fe, Mn, and S which have been shown to be essential are not present if chemically pure salts are used in the preparation.
The way in which culture media shall be used depends on the purpose in view. By far the larger part of bacteriological work is done with cultures in “bacteriological culture tubes.” Various laboratories have their own special types but all are more or less after the “Board of Health” form. They differ from ordinary chemical test-tubes in that they are usually longer, have no “lip” and have much thicker walls to prevent breakage and consequent loss of the culture as well as danger from pathogenic organisms. The author finds two sets of tubes most serviceable for student use—one size 15 cm. long by 19 mm. outside diameter (No. 9, Fig. 119), the other 15 cm. long by 13 mm. (Nos. 1 to 7, Fig. 119). Culture tubes are conveniently used in “wire baskets” circular or square in section and of a size to correspond with the length and number of tubes used. These baskets are light, do not break, and if made of good galvanized wire netting do not readily rust (Figs. 117 and 118).
Liquid media such as broth, milk, litmus milk, indol and nitrate broths are used in the above-mentioned tubes when small quantities only are to be worked with. The tubes are filled approximately one-third full, then plugged with non-absorbent cotton and sterilized. Cotton plugs are used so much in bacteriological work because they permit a free circulation of air and gases and at the same time act as filters to keep out the bacteria of the air.
Sugar broths or other media in which gas may be produced are used in fermentation tubes (Smith tubes) of the type shown in Fig. 120 so that the gas may be collected in the closed arm of the tube, measured (Fig. 121) and tested if desired.



One method of using gelatin and also agar is as “puncture” or “stab” cultures. The tubes (the narrower tubes are to be preferred for most “stab” cultures) are filled one-third full of the medium while it is still fluid, plugged, sterilized and allowed to cool in the vertical position. The medium is then “inoculated” with a straight platinum needle by plunging this into the center of the surface down to the bottom of the tube (Fig. 119, Nos. 4 and 5).

Agar and blood serum are frequently used in the form of “slope” or “slant” cultures. That is, the medium solidifies with the tubes lying on their sides which gives a long, sloping surface on which the bacteria are inoculated (Fig. 119, Nos. 6 and 7).


Potato tubes are likewise used for “slant” or “slope” cultures (Fig. 119, No. 8). Potatoes as “plate cultures” have been referred to. Agar and gelatin are very largely used in the form of “plate cultures” also. For this purpose Petri dishes are first sterilized, then the melted agar or gelatin poured into them and allowed to “set” while the plates are kept horizontal. The melted media may be “inoculated” before they are poured, or a portion of the material to be “plated” may be placed in the dish, then the melted medium poured in and distributed over the dish by tilting in various directions, or the medium after solidifying may be inoculated by “strokes” or “streaks” over its surface, according to the purpose in view in using the plate. The larger sized tubes should be used for making plates in order to have sufficient medium in the plate (No. 9, Fig. 119).
For using large quantities of medium, Florence flasks, Ehrlenmeyer flasks, special toxin flasks (Fig. 122) or various other devices (Vaughan and Novy’s “mass cultures,” Figs. 123 and 124) have been employed.
For growing anaërobic organisms it is evident that some method for removing and excluding the oxygen of the air must be used. A very great variety of appliances have been devised for these purposes. Some are based on the principle of the vacuum, exhausting the air with an air pump; some on replacing the air with a stream of hydrogen; others on absorbing the oxygen by chemical means, as with an alkaline solution of pyrogallic acid, or even by growing a vigorous aërobe in the same culture or in the same container with the anaërobe, the aërobe exhausting the oxygen so that the anaërobe then develops, or finally by excluding the air through the use of deep culture tubes well filled with the medium, or in the closed arm of fermentation tubes. For many purposes a combination of two or more of the above methods gives good results.
In any event the culture medium should have been freshly sterilized just before use, or should be boiled in order to drive out the dissolved oxygen. For most, anaërobes the presence in the medium of about 1 per cent. of a carbohydrate, as dextrose, is advisable.
A description of all the various devices is unnecessary in this work, but the following have answered most of the purposes of general work in the author’s laboratories.


A. “Vignal tubes” of the style shown (Fig. 125) are made from glass tubes of about 6 to 8 mm. outside diameter, sealed at the small end, plugged with cotton above the constriction and sterilized. The medium, agar or gelatin, which has been previously inoculated with the anaërobic culture, is then drawn up into the tube, after breaking off the tip, as far as the constriction. The tube is then sealed in the flame at the small end and also at the constriction. Since it is full of the medium and sealed, access of air is prevented. This forms an excellent means for “isolation” (Chapter XVIII); the tube needs merely to be cut with a file at the point where colonies appear, then these may be readily transferred.

B. “Fermentation tubes” form a simple means for growing liquid cultures of anaërobes, the growth occurring in the closed arm only, while with facultative anaërobes, growth occurs both in the closed arm and in the open bulb. A little “paraffin oil” (a clear, heavy petroleum derivative) may be poured on the fluid in the open bulb as a very efficient seal, though it is not usually necessary.
C. “Deep culture tubes.”—The medium, agar, gelatin or a liquid is poured into tubes until they are approximately one-half full, a little paraffin oil is poured on the surface (not essential always), then the tubes are plugged and sterilized. Inoculation is made to the bottom and anaërobes grow well (Fig. 126).

D. For slope or plate, or any type of surface cultures the Novy jar (Fig. 127) is the most practical device. It is good practice to combine the vacuum method, the hydrogen replacement method and the oxygen absorption method in using these jars. In operation a solution of 20 per cent. NaOH is poured on the bottom of the jar to a depth of 1 or 2 cm., the cultures are placed on glass supports above the alkali and a short wide tube of strong pyrogallol is set in on the bottom in such a way that it may be easily upset and mixed with the alkali when it is desired to do so. The cover is now clamped in position with all joints well vaselined. Then the outlet tube is connected with a suction pump and the air drawn out. Meanwhile the inlet tube has been connected with a hydrogen generator, and after the jar is exhausted hydrogen is allowed to flow in, and this process is repeated until one is satisfied that the air is replaced. The suction exhausts the air from the tubes or plates so that much less time is required to replace the air with hydrogen. Finally the stop-cock is closed, and the pyrogallol solution is gently shaken down and mixed with the alkali so that any remaining oxygen will be absorbed.

It must be remembered that facultative anaërobes as well as anaërobes will grow under any of the above conditions, so that cultures of organisms so obtained must be further tested aërobically in order to determine to which group the organisms belong.
Reference has been made above to the “inoculation” of culture media, which means introducing into the medium used the desired material in the proper way. For small quantities this is most conveniently done with platinum “needles,” that is, pieces of platinum wire inserted into the ends of glass rods. The “straight” needle is a piece of heavy platinum wire of about 0.022 inch in diameter (Fig. 128). It is used most frequently to inoculate all forms of solid media. The platinum loop is of lighter wire, 0.018 inch. The loop in the end is conveniently made by twisting the wire around the lead of an ordinary lead-pencil. The “loop needle” (Fig. 129) is most used in transferring liquid media. On account of the high price of platinum, the author has substituted “nichrome” wire for student use. This is stiffer, not so easily made into loops and breaks out of the rods more easily. The latter defect is remedied to some extent, by imbedding the wire only slightly for about one-fourth of an inch on the side of the end portion of the rod. The low cost, less than one-twentieth of platinum, justifies its use.


Sterile graduated pipettes varying in capacity from 1 cc graduated in hundredths, upward, permit the transfer of definite amounts of liquids. Large quantities are conveniently transferred by means of Pasteur flasks (Fig. 130). The details of inoculation are best derived from laboratory practice.
As has been stated, the thorough study of a bacterium depends on first getting it in pure culture. In the early days of bacteriology supposedly pure cultures were obtained by (1) dilution in liquid media. A series of tubes or flasks containing sterile liquid media was prepared. Number one was inoculated with the material to be examined and thoroughly mixed. A small portion of the mixture was transferred to number two, and mixed; from this to number three, and so on until a sufficient number were inoculated, the last three or four in the series receiving the same amounts of a very high dilution of the original material. If one or two of these latter showed a growth and the others not, it was assumed that the dilution had been carried so far that only a single organism was transferred and therefore the culture obtained was “pure.” The method in this crude form is too uncertain to be of value today and recourse is had to more exact means. The procedure most widely used is that of (2) “plating out” by means of gelatin or agar plates. The material to be plated out is diluted by transferring to three or more tubes of melted gelatin or agar as in the first method and then all the tubes are poured into Petri dishes and grown under suitable conditions. By proper mixing in the tubes the bacteria are well scattered through the medium which holds the individual organisms separate when it solidifies. On some of the plates a sufficient dilution will be reached so that the colonies developing from the bacteria will be so few that they are separate and pure cultures may be obtained by inoculating from one of these a tube of the appropriate medium (Figs. 131 to 134). The chief uncertainty with this method is that occasionally two kinds of bacteria stick together so closely that even the separate colonies contain both organisms. This is not common, however. The plate colonies frequently develop from groups of bacteria which were not separated, but as these are of the same kind the culture is essentially pure.


Another method which is frequently applicable with material from human or animal sources is to (3) rub the material over the surface of a slope tube or of medium solidified in a Petri dish with a sterile heavy platinum needle, glass rod, or cotton swab. If the bacteria are not too numerous, pure cultures may frequently be obtained. A modification of this method is to make a series of (4) parallel streaks on a slope tube or plate of medium with a needle inserted but once into the material to be plated. On the first streak most of the bacteria are rubbed off and a continuous growth results, but usually on the last of a series only isolated colonies appear, which are presumably pure. The ideal method for securing pure cultures is to be absolutely certain that the culture starts from a single organism. This may be accomplished by means of the (5) apparatus and pipettes devised by Professor Barber of the University of Kansas (Figs. 135 and 136). With this instrument a single organism is picked out under the microscope and isolated in a drop of culture medium and observed until it is seen to divide, thus proving its viability. Transfers are then made to the proper media. The method requires much practice to develop the necessary skill in the making of pipettes, determining the proper condition of the large cover-glasses used over the isolating box, and in manipulation, but the results fully compensate.


Professor W. A. Starin of the author’s department, a former student of Professor Barber, has done some excellent work with this apparatus.


A number of procedures may be used to greatly facilitate the above methods of isolation by taking advantage of the different physiological properties of different organisms in a mixture such as ability to form spores, different resistance to antiseptics, special food requirements, and pathogenic properties. (a) If material contains resistant spores, it may be heated to temperatures high enough to kill all of the organisms except the spores (80° for half an hour, for example) and then plated out. Or (b) an antiseptic which restrains the growth of some organisms and not others may be placed in the culture media (carbolic acid, various anilin dyes, (p. 162), excess acid, or alkali, ox bile, etc.), when the more resistant organisms grow on the final plates, the others not. (c) Special food substances (various carbohydrates) from which the organism desired forms special products (acids, aldehydes) that may be shown on the plates by various indicators, is one of the commonest means. Or media in which certain organisms thrive and others not, so that the former soon “crowd out” the latter (unsterilized milk for lactic acid bacteria, inorganic media in soil bacteriology) may be used. A combination of the general methods (b) and (c) is much used in the separation of the organisms of the “intestinal group” in human practice. (d) The inoculation of a susceptible animal with a mixture suspected to contain a given pathogenic bacterium frequently results in the development of the latter in pure culture in the body of an animal, from which it may be readily recovered. In all of the above methods (except Barber’s) the first “pure culture” obtained should be “purified” by replating in a series of dilution plates to make sure that it is pure.
When an organism has been obtained in pure culture by any of the methods described in the preceding chapter the next step is the study of its morphology as discussed in Chapters II–IV. This involves the use of the microscope, and since bacteria are so small, objectives of higher power than the student has presumably used will be needed. Doubtless only the two-thirds inch or 16 mm. and the one-sixth inch or 4 mm. objectives are all that have been used in previous microscopic work, while for examining bacteria a one-twelfth inch or 2 mm. is necessary. It will have been observed that the higher the power of the objective the smaller is the front lens or object glass and consequently the less is the amount of light which enters. With the use of the one-twelfth inch or 2 mm. objective it is necessary to employ two devices for increasing the amount of light entering it, with which the student is probably not familiar. One of these is to place a drop of cedar oil between the front lens and the object and to immerse the lens in this oil—hence the term “oil-immersion objective;” the other is the substage or Abbé condenser. The latter is a system of lenses placed below the stage and so constructed as to bring parallel rays of light—daylight—from an area much larger than the face of the front lens of the objective to a focus on the object to be examined, thus adding very greatly to the amount of light entering the objective. Since the condenser brings parallel rays to a focus on the object, the flat-mirror is always used with the condenser when working with daylight. With artificial light close to the microscope, the concave mirror may be used to make the divergent rays more nearly parallel and thus give better illumination.
The function of immersion oil is to prevent the dispersion of considerable light that would otherwise occur owing to refraction as the light passes up through the slide and into the air. The accompanying diagram will help to make this clearer (Fig. 137). A ray of light (A B) coming through the slide will be refracted in the direction B C if the medium has a lower refractive index than the slide, as air has, and hence will not enter the objective O. If, however, there is interposed between the objective and the slide a medium which has the same refractive index as the slide, as immersion oil has, then the ray will continue in the same direction (B D) at the point B and hence enter the objective. Evidently the immersion oil causes much more light to enter the front lens and makes the field brighter and at the same time prevents considerable refraction and dispersion of light from the object seen and hence this appears more distinct and sharply defined. The Abbé condenser and the oil-immersion objective are practically always used in the microscopic study of bacteria (Fig. 138).

It is sometimes necessary to examine living bacteria and for this purpose the device known as the “hanging drop slide” is used (Fig. 139). The slide has a slight concave depression ground in the middle of one face. A ring of vaseline is placed around this depression with the loop needle. On a clean cover-glass, large enough to fit over the ring of vaseline, several drops of a broth culture, or of material from a solid culture suspended in broth or physiological normal salt solution are placed. The slide is inverted on the cover-glass in such a way that the ring of vaseline seals the latter to the slide. When the whole preparation is quickly turned cover side up, the drops are seen “hanging” to the under side of the cover over the depression in the slide. In examining such a preparation with the microscope great care is necessary in order to focus on the bacteria, without breaking the cover. To see the organisms distinctly the lower iris diaphragm of the condenser must be nearly closed, so that the light coming through consists mainly of parallel vertical rays, otherwise the transparent bacteria themselves refract and diffract the light and appear blurred and indistinct. By studying living bacteria with this device it can be determined whether they are motile or not. The motility should not be confounded with the familiar “Brownian movement” of all minute insoluble inert particles which non-motile living bacteria and also dead bacteria show. The hanging drop slide is of value in the measurement of bacteria, since this is properly done on the living organism. Measurement is done with a calibrated ocular micrometer as in other kinds of measurement with the microscope with which the student is presumably familiar. The direct effect of various agents on living bacteria as light, electricity, heat, etc., in the study of “tropisms” and “taxes” has been investigated on various modifications of the above-described hanging drop slide.
Cell forms and cell groupings may be studied in the same way but these features are best determined on stained preparations in many instances.
“Dark field” illumination and the ultramicroscope are of great value in the study of living bacteria and other minute objects, but apparatus of this type would scarcely be used by the student in an introductory course, so that they will not be discussed in the present volume.
The main use of the microscope in bacteriology is in the study of stained preparations of the organisms. Staining makes bacteria opaque and hence more easily seen than the transparent unstained forms. Some methods of staining also show morphological structures which are either imperfectly recognized in the unstained cell, spores, or are not visible at all—capsules, metachromatic granules, flagella. Finally certain bacteria are colored by special methods of staining which do not affect others, so that under proper conditions these bacteria may be recognized by staining methods alone—tubercle bacilli in the organs of animals.
The phenomena of staining are essentially chemical, though sometimes the chemical union is a very weak one, even resembling an absorption of the dye rather than true chemical union—most watery stains. In other cases the chemical compounds formed are decidedly stable and are not decomposed even by strong mineral acids—staining of tubercle bacilli and other “acid-fast” organisms. In still other cases the principal action is a precipitation on the surface of the object stained—methods for staining flagella.
In many methods of staining in addition to the dyes used other substances are added to the solution which assist in fixing the dye in or on the organism stained. Such substances are called mordants. The principal mordants used are alkalies, anilin, carbolic acid, iodine, metallic salts, tannic acid.
While it is true that some bacteria may be stained by that standard histological nuclear dye, hematoxylin, it is of little value for this purpose. Practically all bacteriological stains are solutions of the anilin dyes. These dyes, as is well known, are of nearly every conceivable color and shade but relatively very few are used in bacteriological work. The beginning student will rarely use solutions of other than the three dyes fuchsin (red), methylene blue and gentian violet for staining bacteria, with occasionally Bismarck brown, or eosin, or safranin as tissue contrast stains.
The bacteriological dyes are kept “in stock” as saturated solutions in 95 per cent. alcohol which are never used as stains, but merely for convenience in making the various staining solutions.
The approximate percentages of the three common dyes in such solutions are indicated in the following table adapted from Woods Chemical and Microscopical Diagnosis, Third Edition, 1917, Appendix:
| Fuchsin | 3.0% |
| Gentian Violet | 4.8% |
| Methylene Blue | 2.0% |
The stains made from these dyes which are in most common use are the following:
| Saturated alcoholic solution of gentian violet | 1 part |
| Distilled water | 20 parts |
| Mix well and filter. | |
| Saturated alcoholic solution of gentian violet | 1 part |
| Anilin water (see below) | 10 parts |
| Mix well and filter. | |
| Saturated alcoholic solution of fuchsin | 1 part |
| Anilin water (see below) | 10 parts |
| Mix and filter. | |
These stains rarely keep longer than ten days in the laboratory (unless kept in the ice-box) and must be made fresh on the first sign of a deposit on the glass of the container.
Anilin Water.—Anilin water is made by putting 3 or 4 cc of anilin “oil” in a 120 cc. flask, adding 100 cc of distilled water, shaking vigorously for a minute or so and filtering through a wet filter, in other words, a saturated solution of anilin in water.
| Saturated alcoholic solution of methylene blue | 3 parts |
| Aqueous solution of NaOH (or KOH), 1 to 10,000 | 10 parts |
| Mix and filter. | |
| Saturated alcoholic solution of fuchsin | 1 part |
| 5 per cent. aqueous solution of carbolic acid | 10 parts |
| Mix and filter. | |
| Dry methylene blue | 4 parts |
| Concentrated H2SO4 | 25 parts |
| Distilled water | 75 parts |
| Dissolve the dry dye in the acid and add the solution to the distilled water and filter. | |

Staining solutions are conveniently kept in square dropping bottles inserted in a block as shown in Fig. 140. This form of holder necessitates the use of one hand only in securing the stain and dropping it on the preparation.
The actual staining of bacteriological preparations can be learned only by repeated laboratory practice, yet the following methods have given such uniform results in class work that it is felt they are not out of place in a text-book.
Preparation of the “Film.”—The author learned to stain bacteria, on the “cover-glass” but does not recall having used this method in fifteen years and does not teach it to his students. All staining is done on the slide. To prepare a film from a solid culture medium the procedure is as follows:
First, be sure the slide is clean and free from grease. This is accomplished most readily by scouring a few minutes with finely ground pumice stone and a little water, then washing and drying with a grease-free cloth, handkerchief, or piece of cheese-cloth. With the “loop” needle place in the middle of the slide a small loop of water. This is best done by filling the loop by dipping in water, then tapping it gently so that all that remains is the water that just fills the loop level full, and this amount is placed on the slide by touching the flat side of the loop to the glass. Then the straight needle is sterilized, dipped into the culture and just touched once into the small drop of water on the slide. The remainder of the culture on the straight needle is then burned off and the needle is used to spread the drop of water containing the bacteria into a thin even film, which will result, provided the slide is free from grease. This is dried and then “fixed” by passing three times through the Bunsen flame at intervals of about one second, passing through slowly for thick slides and a little more rapidly for thin ones. If the culture is in a liquid medium, the use of the loop of water is unnecessary; a loop of the fluid from the surface, middle or bottom as the culture indicates is spread out to a thin film, dried and fixed.
After the film is fixed the stain desired is dropped on, allowed to act for the proper time, which will depend on the stain and the preparation, washed in water, dried thoroughly and examined with the oil-immersion lens, without a cover. If it is desired to preserve the preparation it may then be mounted in balsam. This is not necessary, as they keep just as well, provided the immersion oil is removed. To do this, fold a piece of filter paper so that at least three thicknesses result. Lay this on the slide and press firmly several times, when the surplus oil will be taken up by the paper. Slides not mounted in balsam are more apt to become dusty than those that are. This is the only disadvantage.
Gram’s Method of Staining.—It has been ascertained that some bacteria contain a substance, possibly a protein, which forms a compound with gentian violet and iodine, which compound is insoluble in alcohol, and other bacteria do not contain this substance. Consequently when bacteria are stained by Gram’s method (given below), those that contain this chemical remain colored, while if it is not present the dye is washed out by the alcohol and the bacteria are colorless and may be stained by a contrast stain. The bacteria which stain by this method are said to “take Gram’s” or to be “Gram-positive,” while those that decolorize are called “Gram-negative.” The method is:
Gram’s solution is:
| I | 1 part |
| KI | 2 parts |
| H2O | 300 parts |
This method is excellent for differentiating Gram-positive and Gram-negative organisms on the same slide. First stain by this method and after washing with alcohol stain with a counter-stain, carbol-fuchsin diluted ten to fifteen times with water is excellent. The Gram-positive bacteria are violet and the Gram-negative are red.
It is also of great value in staining Gram-positive bacteria in tissues, but the sections should be stained about five minutes in the anilin gentian violet and be left about two minutes in the Gram’s solution. Sections are to be counter-stained in Bismarck brown, dilute eosin or safranin solutions and cleared in oil of bergamot, lavender or origanum and not in clove oil or carbol-xylol, as these latter dissolve out the dye from the bacteria.
Staining of Spores in the Rod.—Prepare the films as usual. Cover with carbol-fuchsin, using plenty of stain so that it will not dry on the slide; heat until vapor arises, not to boiling; cool until the stain becomes cloudy and heat again until the stain clears, and repeat once more; wash in tap water and then wash in 1 per cent. H2SO4 three times, dropping on plenty of acid, tilting and running this over the slide three times and then pour off and use fresh acid and repeat this once. Wash thoroughly in distilled water, then stain with Löffler’s blue one to three minutes. Wash, dry and examine. The spores should be bright red in a blue rod.
This method will give good results if care is taken to secure cultures of the right age. If the culture is too old the spores will all be free outside the rods, while if too young they will decolorize with the acid. For Bacillus subtilis and Bacillus anthracis, cultures on agar slants forty-eight hours in the 37° incubator are just right. For the spores of Clostridium tetani, the culture should be three days old, but may be as old as a week.
Staining of “Acid-fast” Bacilli.—Mycobacterium tuberculosis, Mycobacterium of Johne’s disease, “grass” and “butter bacilli,” Mycobacterium lepræ, Mycobacterium smegmatis.
The sulphuric acid in Gabbet’s blue removes the carbol-fuchsin from everything except the “acid-fast” bacteria, which remain red, and the blue stains the decolorized bacteria and nuclei of any tissue cells present.
The results are the same as with Gabbet’s method.
Staining of Capsules.—Räbiger’s Method.—Films of the organism to show capsules should be freshly prepared, dried but not fixed. Material is usually obtained from milk or blood. A drop of the fluid is placed on the middle of a slide about one-fourth of the distance from one end. The narrow edge of another clean slide is placed in this drop and then drawn lengthwise across the slide with firm pressure. This gives a thin layer which is necessary if good results are to be expected. The preparation is covered with a freshly prepared saturated solution of gentian violet in formalin and this allowed to stain for 30 seconds. Then wash lightly, dry and examine. The organisms appear deeply violet and much larger than with ordinary stains and capsules are well stained and show well.
Welch’s Method.—Prepare films as in the above method. Cover with glacial acetic acid for 10 to 20 seconds. Wash off the acid with carbol-fuchsin. Wash the stain off with physiological normal salt solution (0.85 per cent.) until all surplus stain is removed. Dry and examine. Capsules and bacteria are red.
Staining of Flagella.—The rendering of flagella visible is considered one of the most difficult processes in staining. Experience of a number of years during which whole classes numbering from one hundred to three hundred students accomplish this result shows that it is no more difficult than many other staining processes. The essentials are: (1) clean slides, (2) young cultures on agar slopes, (3) freshly prepared mordant and stain which are kept free from precipitate, (4) gentle heating. The author’s students are furnished only stock materials and make their own cultures, mordants and stains.
The slides are cleaned with pumice in the usual way. An agar slope culture of the organism to be stained from six to twenty-four hours old is selected. A bit of the culture is removed and placed in a watch-glass of water. The bacteria are allowed to diffuse of themselves without stirring. After several minutes a loop of this water is removed and three streaks are made across the slide, one in the middle and one on each side of this about one-quarter of an inch from it. This gives well scattered bacteria in one of the three streaks at least and very little other material on the slide to cause precipitates. The slide is carefully dried and fixed and then covered with an abundance of the mordant by filtering through a small filter onto the slide so that the mordant shows transparent on the slide. The preparation is then gently warmed and cooled three times, adding mordant if necessary. Do not heat to steaming. After mordanting for about five minutes the excess is washed off under the tap. It is a good plan to hold the slide level and allow the water to run into the center of the mordant and flow it off. Inclining the slide is apt to cause the film on the surface of the mordant to settle down on the slide and spoil the preparation. After the mordant is washed off and all traces of it removed with a clean cloth if necessary the stain is applied and gently heated and cooled the same way for from three to five minutes. The preparation is then washed, dried and examined.
The mordant used is a modification of Löffler’s which is somewhat simpler in preparation since the stock solution of FeCl3 is more permanent than FeSO4 solution.
Mordant sufficient for one student:
| 5 per cent. solution of FeCl3 | 20.0 cc |
| 25 per cent. solution of tannic acid | 20.0 cc |
| Anilin fuchsin | 4.0 cc |
| Normal NaOH | 1.5 cc |
The solution of FeCl3 is made up in the cold and must be perfectly clear. The tannic acid solution must be thoroughly boiled and filtered until clear. The iron and the acid are carefully mixed, boiled and filtered clear. The anilin fuchsin must be added slowly with constant stirring and the mixture boiled and filtered. The NaOH is added in the same way and this mixture boiled and filtered. The final mordant should not leave a film on a clean slide when poured on and allowed to run off. Unless the mordant is in this condition and perfectly clear, it should not be used, but a new one must be made up. Time and care in the preparation of the mordant are essential.
The stain to follow this mordant is anilin fuchsin.
Staining of Metachromatic Granules.—Neisser’s Method. Prepare the film in the usual way. Stain with Neisser’s stain a few seconds only. Wash and stain with Bismarck brown a few seconds only.
| Sat. alcoholic solution of methylene blue | 1.0 part |
| Glacial acetic acid | 2.5 parts |
| Distilled water | 50.0 parts |
| Bismarck brown (dry dye) | 2 parts |
| Distilled Water | 1000 parts |
By the use of the hanging drop slide and the methods of staining just described all the various morphological features of the bacterial cell may be ascertained.
It is necessary when cell groupings as characteristic of definite modes of division are to be determined to make slides from a liquid culture, as broth. Place a drop of the material, preferably from the bottom of the tube in most instances, from the top in case a pellicle or scum is formed on the surface, on the slide and allow this to dry without spreading it out, fix, wash gently with water, then stain lightly with Löffler’s blue. Such slides also show characteristic cell forms as well. Slides should be made from solid media to show variations in form and size and involution forms. These latter are especially apt to occur on potato media.
Of the environmental conditions influencing the growth of bacteria the following are the chief ones ordinarily determined:
A. Temperature.—The optimum temperature for growth is usually about the temperature of the natural environment and ordinarily one determines merely whether the organism grows at body temperature (37°) and at room temperature (20°) or not. For exact work the maximum, minimum and optimum temperature must be ascertained by growing in “incubators” with varying temperatures.
A bacteriological incubator is an apparatus for growing bacteria at a constant temperature. This may be any temperature within the limits for bacterial growth. If temperatures above that of an ordinary room are desired, some source of artificial heat is needed. Electricity, gas or oil may be used. A necessary adjunct is some device for maintaining the temperature constant, a “thermoregulator” or “thermostat.” For lower temperatures a cooling arrangement must be installed. For the great part of bacteriological work only two temperatures are used, 20° so-called “room temperature” (this applies to European “rooms” not to American) and 37° or body temperature. Incubators for 37° of almost any size and style desired may be secured from supply houses and need not be further described. Figs. 141 and 142 illustrate some of the types.
For use with large classes “incubator rooms” are to be preferred. The author has one such room for 37° work with 200 compartments for student use which did not cost over $60 to install.


The styles of incubators for lower temperatures, 20° and below, are not so numerous nor so satisfactory. The author has constructed a device which answers every purpose for a small class. The diagram, Fig. 143, explains it.

The thermal death-point is determined by exposing the organisms in thin tubes of broth at varying temperatures for ten-minute periods and then plating out to determine growth. The effect of heat may also be determined by exposing at a given temperature, e.g., 60°, for varying lengths of time and plating out.
B. Oxygen relations—whether the organism is aërobic, anaërobic, or facultative is determined by inoculation in gelatin or agar puncture or stab cultures and noting whether the most abundant growth is at the top, the bottom or all along the line of inoculation.
C. Reaction of the medium—acid, alkaline or neutral as influencing the rate and amount of growth.
D. The kind of medium on which the organism grows best.
E. The effect of injurious chemicals, as various disinfectants, on the growth.
F. Osmotic pressure conditions, though modifying decidedly the growth of bacteria, are not usually studied as aids in their recognition, nor are the effects of various forms of energy, such as light, electricity, x-rays, etc.
Among the “Physiological Activities” discussed in Chapters IX–XII those which, in addition to the staining reactions described, are of most use in the identification of non-pathogenic bacteria are the first ten listed below. For pathogenic bacteria the entire thirteen are needed.
1. Liquefaction of gelatin.
2. Digestion of blood serum.
3. Coagulation and digestion of milk.
4. Acid or gaseous fermentation in milk, or both.
5. Acid or gaseous fermentation of various carbohydrates in carbohydrate broth, or both.
6. Production of indol in “indol solution.”
7. Production of pigments on various media.
8. Reduction of nitrates to nitrites, ammonia, or free nitrogen.
9. Production of enzymes as illustrated in the above activities.
10. Appearance of growth on different culture media.
11. Production of free toxins as determined by injection of animals with broth cultures filtered free from bacteria.
12. Causation of disease as ascertained by the injection of animals with the bacteria themselves, and recovery of the organism from the animals.
13. Formation of specific antibodies as determined by the proper injection of animals with the organism or its products and the subsequent testing of the blood serum of the inoculated animals.
For special kinds of bacteria other activities must be determined (oxidation, nitrate and nitrite formation, action of sulphur and iron bacteria, etc.).
The first nine activities are determined by inoculating the different culture media already described and observing the phenomena indicated, making chemical tests where necessary.
In addition to those changes that are associated with the manifestation of different physiological activities, many bacteria, show characteristic appearances on the various culture media which are of value in their identification.
Too much stress should not be laid on these appearances alone, however, since slight variations, particularly in solid media due especially to the age of the medium, may change decidedly the appearance of a colony. This is true of variations in the amount of moisture on agar plates. Colonies which are ordinarily round and regular may assume very diverse shapes, if there chance to be an excess of moisture on the surface.
Also in slope and puncture cultures on the various solid media much variation results from the amount of material on the inoculation needle and just how the puncture is made, or the needle drawn over the slope. These variations are largely prevented by the use of standard media and by inoculating by standard methods. The Laboratory Committee of the American Public Health Association has proposed standard methods for all culture media and tests and for methods of inoculation, and these have been generally adopted in this country for comparative work.
Likewise the Society of American Bacteriologists has at different times (1904, 1914, 1917) adopted “descriptive charts” for detailing all the characteristics of a given organism. A committee is at present working on a revision of the 1917 chart to be presented at the 1920 meeting. One of the earlier charts which includes a glossary of descriptive terms is inserted in this chapter.
Among the cultural appearances the following are of most importance:




In broth cultures the presence or absence of growth on the surface and the amount of the same. Whether the broth is rendered cloudy or remains clear, and whether there is a deposit at the bottom or not (Fig. 144). An abundant surface growth with little or nothing below indicates a strict aërobe, while a growth or deposit at bottom and a clear or nearly clear medium above, an anaërobe. These appearances are for the first few days only of growth. If the broth is disturbed, or after the culture stands for several days many surface growths tend to sink to the bottom. So an actively motile organism causes in general a cloudiness, especially if the organism is a facultative anaërobe, which tends to clear up by precipitation after several days when the organisms lose their motility. Non-motile facultative anaërobes usually cloud the broth also, but settle out more rapidly than the motile ones.
In gelatin and agar punctures the oxygen relationship is shown by surface growth for aërobes, growth near the bottom of the puncture for anaërobes, and a fairly uniform growth all along the line of inoculation for facultative anaërobes. In the case of these last organisms, a preference for more or less oxygen is indicated by the approach to the aërobic or anaërobic type of growth.




Along the line of puncture the commonest types are filiform (Fig. 145), which indicates a uniform growth; beaded (Fig. 146), or small separate colonies; villous (Fig. 147), delicate lateral outgrowths which do not branch; arborescent, tree-like growths branching laterally from the line. In agar these branchings are usually short and stubby, or technically, papillate.



Further, in the gelatin puncture the liquefaction which occurs is frequently characteristic. It may be crateriform (Fig. 148), a shallow saucer at the surface; or funnel-shaped (Fig. 149); or it may be of uniform width all along the puncture, i.e., saccate (Fig. 150); or it may be stratiform, (Fig. 151), i.e., the liquefaction extends to the sides of the tube and proceeds uniformly downward.




On agar, potato and blood serum slope tubes the amount of growth, its form and elevation, the character of the surface, and the consistency should be carefully noted, and in some few cases the character of the edge. Figures 152 to 158 show some of the commoner types.

On agar and gelatin plates made so that the colonies are well isolated, the form of the latter, the rate of their growth, the character of the edge and of the surface, the elevation and the internal structure as determined by a low-power lens are often of almost diagnostic value. Also in the case of the gelatin plates, the character of the liquefaction is important. Figs. 159 to 167 show some of the commoner characteristics to be noted.




Colonies of mold frequently appear on plates. These are readily differentiated from bacterial colonies after a little experience. With the naked eye usually the fine radiations of the edge of the colony are apparent. The surface appears duller and by reflected light more or less “fuzzy.” With the low-power objective the relatively large, branching threads of the mold (mycelia) show distinctly. Also the large fruiting bodies (sporangia) are easily distinguished. Figs. 168 to 171 illustrate a common black mold (Rhizopus nigricans).
Animal inoculation has been referred to (1) as a method of assisting in the preparation of pure cultures of pathogenic organisms; (2) as a means of testing the poisonous properties of substances produced in bacterial cultures; (3) in order to test the ability of an organism to cause a disease; (4) for the production of various antibodies; it may be added (5) that some bacteria produce in the smaller experimental animals lesions which do not occur in animals naturally infected, but which nevertheless are characteristic for the given organism. The best illustration is the testicular reaction of young male guinea-pigs to intraperitoneal injections of glanders bacilli. Experimental animals are also inoculated (6) to test the potency of various bacterial and other biological products, as toxins, antitoxins, etc.
Guinea-pigs are the most widely used experimental animals because they are easily kept and are susceptible to so many diseases on artificial inoculation. Rabbits are used very largely also, as are white mice. For special purposes white rats, pigeons, goats and swine are necessary. For commercial products horses (antitoxins) and cattle (smallpox vaccine) are employed. In the study of many human diseases the higher monkeys and even the anthropoid apes are necessary, since none of the lower animals are susceptible.
The commonest method of animal inoculation is undoubtedly the subcutaneous. This is accomplished most readily with the hypodermic needle. The skin at the point selected (usually in guinea-pigs the lateral posterior half of the abdominal surface, in mice the back near the root of the tail) is pinched up to avoid entering the muscles and the needle quickly inserted. Clipping the hairs and washing with an antiseptic solution should precede the inoculation as routine practice. Frequently a small “skin pocket” is all that is needed. The hair is clipped off, the skin pinched up with small forceps and a slight snip with sharp scissors is made. The material may be inserted into this pocket with a heavy platinum needle. Cutaneous inoculation is made by shaving the skin and rubbing the material onto the shaved surface or scratching with a scalpel or special scarifier, but without drawing blood, and then rubbing in the material to be inoculated.
Intravenous injections are made with larger animals. In rabbits the posterior external auricular is a convenient vein. In larger animals the external jugular is used.
Intraperitoneal, -thoracic, -cardiac, -ocular, -muscular injections, and injections into the parenchyma of internal organs are accomplished with the hypodermic needle. In the case of the first two, injury to contained organs should be carefully avoided. Intracardiac injection, or aspiration of the heart to secure blood, requires considerable practice to be successful without causing the death of the animal at once through internal hemorrhage. In subdural injections into the cranial cavity it is necessary to trephine the skull first, while such injections into the spinal canal may be accomplished between the vertebra with needles longer and stronger than the usual hypodermic needle. Occasionally animals are caused to inhale the organisms, or are fed cultures mixed with the feed.
If the site of the lesion is readily accessible from the exterior, material from the living animal should be collected with sterile instruments and kept in sterile utensils until the necessary tests can be made. Testing should be done on material as soon after collection as possible, in all cases, to avoid the effects of “decomposition” bacteria.
If the blood is to be investigated it may be aspirated from a peripheral vein with a sterile hypodermic syringe of appropriate size or allowed to flow through a sterile canula into sterile receptacles. The site of the puncture should be shaved and disinfected before the instrument is introduced.
Discharges of whatever kind should likewise be collected in sterile receptacles and examined as soon as may be.
If internal organs are to be examined it is best to kill a moribund animal than to wait for death, since after death, and in severe infections even sometimes before, the tissues are rapidly invaded by saprophytic bacteria from the alimentary and respiratory tracts which complicate greatly the isolation of the specific organism. Hence the search for specific bacteria in carcasses or organs several hours after death is frequently negative. Animal inoculation with such material is very often followed by sepsis or septicemia in a few hours, so that the specific organism has no opportunity to manifest itself.
In securing material for cultures from internal organs it is a good plan to burn the surface of the organ with a gas or alcohol flame, or to sear it with a hot instrument to kill surface organisms, then make the incision or puncture through the burned area and secure material from the interior of the organ. Such punctures made with a stiff platinum needle frequently give pure cultures of the organism sought. Slides may be made from such material and culture media inoculated at once.
Since a bacteriological diagnosis depends most commonly on growing the organisms, it is evident that material sent for examination must never be treated with an antiseptic or preservative. If decomposition is to be feared the only safe procedure is to pack the material in ice and forward in this way.
Tuberculous material from the parenchyma of internal organs may be forwarded in a preservative (not formalin, since this makes it very difficult to stain the bacteria) as in this special case a very positive diagnosis may be made by staining alone. Even here it is better to pack in ice in order that the diagnosis by staining may be confirmed by inoculating the living organisms into guinea-pigs.
In the case of material from a rabid animal and many protozoal diseases the rule against preservatives is not absolute, since staining is a reliable diagnostic means. Even in these cases it is often desirable to inoculate animals, hence, as before stated, it is best to make it a uniform practice to pack material for examination in ice and use no preservatives.
Pathogenic Bacteriology treats of the unicellular microörganisms which are responsible for disease conditions, i.e., pathological changes in other organisms. Hence not only are bacteria considered, but also other low vegetable forms, as yeasts and molds, likewise protozoa in so far as they may be pathogenic. For this reason the term pathogenic “Microbiology” has been introduced to include all these organisms. It is largely for the reason that the methods devised for the study of bacteria have been applied to the investigation of other microörganisms that the term “bacteriology” was extended to cover the entire field. The general discussion in this chapter is intended to include, therefore, microörganisms of whatever kind pathogenic to animals.
The term pathogenic as applied to an organism must be understood in a purely relative sense, since there is no single organism that can cause disease in all of a certain class, but each is limited to a more or less narrow range. Some form of tuberculosis attacks nearly all vertebrates, but no other classes of animals and no plants. Lockjaw or tetanus attacks most mammals, but not any other vertebrates naturally. Typhoid fever affects human beings; hog cholera, swine, etc. This point is more fully discussed in Chapter XXIII but can not be too greatly insisted upon.
“The greatest enemy to mankind is man.”
Exceptions to this statement do occur and are important and must be considered in efforts to protect completely human beings from disease (tuberculosis from cattle, glanders from horses, poisoning from spoiled canned goods, anthrax from hair, hides, wool, of animals dead of the disease), but the most common human diseases are derived from other human beings directly or indirectly.
Diseases which are due to unicellular pathogenic microörganisms are called infectious diseases, while if such diseases are transmitted under natural conditions from organism to organism they are spoken of as contagious diseases. Most infectious diseases are contagious but not all. Tetanus is a good illustration of a non-contagious infectious disease. There are very few such diseases.
When a unicellular microörganism gains entrance into the body and brings about any pathological changes there, the result is an infection. Undoubtedly many pathogenic organisms get into the body but never manifest their presence by causing disease conditions, hence do not cause an infection. It is the pathological conditions which result that constitute the infection, and not the mere invasion.
The time that elapses between the entrance of the organism and the appearance of symptoms is called the period of incubation and varies greatly in different diseases.
The term infestation is used to denote pathological conditions due to multicellular parasites. Thus an animal is infested (not infected) with tapeworms, roundworms, lice, mites, etc. Many of these conditions, probably all, are contagious, i.e., transmissable naturally from animal to animal. The word contagious has been used in a variety of ways to mean communicated by direct contact, communicated by a living something (contagium) that might be carried to a distance and finally communicable in any manner, transmissable. The agency of transmission may be very roundabout—as through a special tick in Texas fever, a mosquito in malaria, etc.,—or by direct personal contact, as generally in venereal diseases. After all, though exactness is necessary, it is better to learn all possible about the means of transmission of diseases, than quibble as to the terms to be used.
An infectious disease may be acute or chronic. An acute infection is one which runs for a relatively short time and is “self-limited,” so-called, i.e., the organisms cease to manifest their presence after a time. In some acute infections the time is very short—German measles usually runs five or six days. Typhoid fever may continue eight to ten weeks, sometimes longer, yet it is an acute infectious disease. It is not so much the time as the fact of self-limitation that characterizes acute infections.
In chronic infections there is little or no evidence of limitation of the progress of the disease which may continue for years. Tuberculosis is usually chronic. Leprosy in man is practically always so. Glanders in horses is most commonly chronic; in mules and in man it is more apt to be acute.
Many infections begin acutely and later change to the chronic type. Syphilis in man is a good illustration.
The differences between acute and chronic infections are partly due to the nature of the organism, partly to the number of organisms introduced and the point of their introduction and partly to the resistance of the animal infected.
An infectious disease is said to be specific when one kind of organism is responsible for its manifestations—as diphtheria due to the Corynebacterium diphtheriæ, lockjaw due to Clostridium tetani, Texas fever due to the Piroplasma bigeminum, etc. It is non-specific when it may be due to a variety of organisms, as enteritis (generally), bronchopneumonia, wound infections.
Henle, as early as 1840, stated certain principles that must be established before a given organism can be accepted as the cause of a specific disease. These were afterward restated by Koch, and have come to be known as “Koch’s postulates.” They may be stated as follows:
1. The given organism must be found in all cases of the disease in question.
2. No other organism must be found in all cases.
3. The organism must, when obtained in pure culture, reproduce the disease in susceptible animals.
4. It must be recovered from such animals in pure culture and this culture likewise reproduce the disease.
These postulates have not been fully met with reference to any disease, but the principles embodied have been applied as far as possible in all those infections which we recognize as specific, and whose causative agent is accepted. In many diseases recognized as infectious and contagious no organism has been found which is regarded as the specific cause. In some of these the organism appears to be too small to be seen with the highest powers of the microscope, hence they are called “ultramicroscopic” organisms. Because these agents pass through the finest bacterial filters, they are also frequently called “filterable.” The term “virus” or “filterable virus” is likewise applied to these “ultramicroscopic” and “filterable” agents.
The term primary infection is sometimes applied to the first manifestation of a disease, either specific or non-specific, while secondary refers to later developments. For example, a secondary general infection may follow a primary wound infection, or primary lung tuberculosis be followed by secondary generalized tuberculosis, or primary typhoid fever by a secondary typhoid pneumonia. The terms primary and secondary are also used where the body is invaded by one kind of an organism and later on by another kind; thus a primary measles may be followed by secondary infection of the middle ear, or a primary influenza may be followed by a secondary pneumonia, or a primary scarlet fever by a secondary nephritis (inflammation of the kidney). Where several organisms seem to be associated simultaneously in causing the condition then the term mixed infection is used—in severe diphtheria, streptococci are commonly associated with the Corynebacterium diphtheriæ. In many cases of hog-cholera, mixed infections in the lungs and in the intestines are common. Wound infections are usually mixed. Auto-infection refers to those conditions in which an organism commonly present in or on the body in a latent or harmless condition gives rise to an infectious process. If the Bacterium coli normal to the intestine escapes into the peritoneal cavity, or passes into the bladder, a severe peritonitis or cystitis, respectively, is apt to result. “Boils” and “pimples” are frequently autoinfections. Such infections are also spoken of as endogenous to distinguish them from those due to the entrance of organisms from without—exogenous infections. Relapses are usually instances of autoinfection.
Those types of secondary infection where the infecting agent is transferred from one disease focus to another or several other points and sets up the infection there are sometimes called metastases. Such are the transfer of tubercle bacilli from lung to intestine, spleen, etc., the formation of abscesses in internal organs following a primary surface abscess, the appearance of glanders nodules throughout various organs following pulmonary glanders, etc.
The characteristic of a pathogenic microörganism which indicates its ability to cause disease is called its virulence. If slightly virulent, the effect is slight; if highly virulent, the effect is severe, and may be fatal.
On the other hand, the characteristic of the host which indicates its capacity for infection is called susceptibility. If slightly susceptible, infection is slight, if highly susceptible, the infection is severe.
Evidently the degree of infection is dependent in large measure on the relation between the virulence of the invading organism and the susceptibility of the host. High virulence and great susceptibility mean a severe infection; low virulence and little susceptibility a slight infection; while high virulence and little susceptibility or low virulence and great susceptibility might mean a moderate infection varying in either direction. Other factors influencing the degree of infection are the number of organisms introduced, the point where they are introduced and various conditions. These will be discussed in another connection (Chapter XXV).
The study of pathogenic bacteriology includes the thorough study of the individual organisms according to the methods already given (Chapters XVIII–XXI) as an aid to diagnosis and subsequent treatment, bacteriological or other, in a given disease. Of far greater importance than the treatment, which in most infectious diseases is not specific, is the prevention and ultimate eradication of all infectious diseases. To accomplish these objects involves further a study of the conditions under which pathogenic organisms exist outside the body, the paths of entrance into and elimination from the body and those agencies within the body itself which make it less susceptible to infection or overcome the infective agent after its introduction. That condition of the body itself which prevents any manifestation of a virulent pathogenic organism after it has been once introduced is spoken of as immunity in the modern sense. Immunity is thus the opposite of susceptibility and may exist in varying degrees.
That scientists are and have been for some years in possession of sufficient knowledge to permit of the prevention and eradication of most, if not all, of our infectious diseases can scarcely be questioned. The practical application of this knowledge presents many difficulties, the chief of which is the absence of a public sufficiently enlightened to permit the expenditure of the necessary funds. Time and educative effort alone can surmount this difficulty. It will probably be years yet, but it will certainly be accomplished.
Pathogenic bacteria may exist outside the body of the host under a variety of conditions as follows:
(a) The bacilli of tetanus, malignant edema and the organisms of “gas gangrene” are widely distributed. There is no evidence that their entrance into the body is at all necessary for the continuation of their life processes, or that one case of either of these diseases ever has any connection with any other case; they are true saprophytes. Manifestly it would be futile to attempt to prevent or eradicate such diseases by attacking the organism in its natural habitat. Clostridium botulinum, which causes a type of food poisoning in man, does not even multiply in the body, but the disease symptoms are due to a soluble toxin which is produced during its growth outside the body.
(b) Organisms like the bacterium of anthrax and the bacillus of black-leg from their local occurrence seem to be distributed from animals infected, though capable of a saprophytic existence outside the body for years. These can no more be attacked during their saprophytic existence than those just mentioned. Doubtless in warm seasons of the year and in the tropics other organisms pathogenic to animals may live and multiply in water or in damp soil where conditions are favorable, just as the cholera organism in India, and occasionally the typhoid bacillus in temperate climates do.
(c) Most pathogenic organisms, however, when they are thrown off from the bodies of animals, remain quiescent, do not multiply, in fact always tend to die out from lack of all that is implied in a “favorable environment,” food, moisture, temperature, light, etc. Disinfection is sometimes effective in this class of diseases in preventing new cases.
(a) The most common infectious diseases of animals are transmitted more or less directly from other animals of the same species. Human beings get nearly all their diseases from other human beings who are sick; horses, from other horses; cattle, from other cattle; swine, from swine, etc. Occasionally transmission from one species to another occurs. Tuberculosis of swine most frequently results from feeding them milk of tuberculous cattle or from their eating the droppings of such cattle. Human beings occasionally contract anthrax from wool, hair and hides of animals dead of the disease or from postmortems on such animals; glanders from horses; tuberculosis (in children) from tuberculous milk; bubonic plague from rats; rabies practically always from the bites of dogs and other rabid animals, etc. The mode of limiting this class of diseases is evidently to isolate the sick, disinfect their discharges and their immediate surroundings, sterilize such products as must be handled or used, kill lower animals that are dangerous, and disinfect, bury properly, or destroy their carcasses.
Classes of the sick that are especially dangerous for the spread of disease are the mild cases and the undetected cases. These individuals do not come under observation and hence not under control.
(b) This class of carriers offers a difficult problem in the prevention of infectious diseases since they may continue to give off the organisms indefinitely and thus infect others. Typhoid carriers have been known to do so for fifty-five years. Cholera, diphtheria, meningitis and other carriers are well known in human practice. Carriers among animals have not been so frequently demonstrated, but there is every reason for thinking that hog-cholera, distemper, roup, influenza and other carriers are common. Carriers furnish the explanation for many of the so-called “spontaneous” outbreaks of disease among men and animals.
It is the general rule that those who are sick cease to carry the organisms on recovery and it is the occasional ones who do not that are the exceptions. In those diseases in which the organism is known it can be determined by examination of the patient or his discharges how long he continues to give off the causative agent. In those in which the cause is unknown (in human beings, the commonest and most easily transmitted diseases, scarlet fever, measles, German measles, mumps, chicken-pox, small-pox, influenza), no such check is possible. It is not known how long such individuals remain carriers. Hence isolation and quarantine of such convalescents is based partly on experience and partly on theory. It is highly probable that in the diseases just mentioned transmission occurs in the early stages only, except in small-pox and chicken-pox where the organism seems to be in the pustules and transmission by means of material from these is possible, though only by direct contact with it.
The fact that such individuals are known to have had the disease is a guide for control. The methods to be used are essentially the same as for the sick, (a), though obviously such human carriers are much more difficult to deal with since they are well.
(c) Another class of carriers is those who have never had the disease. Such individuals are common and are very dangerous sources of infection. Many of them have associated with the sick or with convalescents and these should always be suspected of harboring the organisms. Their control differs in no way from that of class (b). Unfortunately a history of such association is too often not available. Modern transportation and modern social habits are largely responsible for the nearly universal distribution of this type of carrier. Their detection is probably the largest single problem in the prevention of infectious diseases. A partial solution would be universal bacteriological examination. In our present stage of progress this is impossible and would not detect carriers of diseases of unknown cause.
The various classes of carriers just discussed are in a large part responsible for the continued presence of the commoner diseases throughout the country. The difficulties in control have been mentioned. A complete solution of the problem is not yet obtained. The army experience of the past few years in the control of infectious diseases shows what may be done.
There is another class of carriers which might be called the “universal carrier,” i.e., there are certain organisms which seem to be constantly or almost constantly present in or on the human body. These are micrococci, streptococci and pneumococci, all Gram positive organisms. They are ordinarily harmless parasites, but on occasion may give rise to serious, even fatal, infection. Infected wounds, pimples, boils, “common colds,” most “sore throats,” bronchitis, pneumonia are pathological conditions that come in this class. Such infections are usually autogenous. There is a constant interchange of these organisms among individuals closely associated, so that all of a group usually harbor the same type though no one individual can be called the carrier. Whenever, for any reason, the resistance of an individual (see Chaps. XXV et seq.) is lowered either locally or generally some of these organisms are liable to gain a foothold and cause infection. It sometimes happens that a strain of dangerous organisms may be developed in an individual in this way which is passed around to others with its virulence increased and thus cause an epidemic. Or, since all of the group are living under the same conditions the resistance of all or many of them may be lowered from the same general cause and an epidemic result from the organism common to all (pneumonia after measles, scarlet fever and influenza in camps). Protection of the individual is chiefly a personal question, i.e., by keeping up the “normal healthy tone” in all possible ways: The use of protective vaccines (Chap. XXX) appears to be advisable in such instances (colds, pneumonia after measles and influenza, inflammation of throat and middle ear following scarlet fever and measles). Results obtained in this country during the recent influenza epidemic have been conflicting but on the whole appear to show that preventive vaccination against pneumonia liable to follow should be practiced.
It would seem that among groups of individuals where infection may be expected the proper procedure would be to prepare autogenous vaccines (Chapter XXX) from members of the group and vaccinate all with the object of protecting them.
(d) In this class come the “accidental carriers” like flies, fleas, lice, bed-bugs, ticks, and other biting and blood-sucking insects, vultures, buzzards, foxes, rats, and carrion-eating animals generally; pet animals in the household, etc. Here the animals are not susceptible to the given disease but become contaminated with the organisms and then through defilement of the food or drink or contact with individuals or with utensils pass the organisms on to the susceptible. Some biting and blood-sucking insects transmit the organisms through biting infected and non-infected animals successively. The spirilloses and trypanosomiases seem to be transmitted in this way, though there is evidence accumulating which may place these diseases in the next class. Anthrax is considered in some instances to be transmitted by flies and by vultures in the southern United States. Transmission of typhoid, dysentery, cholera and other diseases by flies is well established in man. Why not hog-cholera from farm to farm by flies, English sparrows, pigeons feeding, or by turkey buzzards? Though this would not be easy to prove, it seems reasonable.
Preventing contact of such animals with the discharges or with the carcasses of those dead of the disease, destruction of insect carriers, screening and prevention of fly breeding are obvious protective measures.
(e) In this class come certain diseases for which particular insects are necessary for the parasite in question, so that certain stages in its life history may be passed therein. The surest means for eradicating such diseases is the destruction of the insects concerned. Up to the present no bacterial disease is known in which this condition exists, unless Rocky Mountain spotted fever and typhus fever shall prove to be due to bacteria. Such diseases are all due to protozoa. Among them are Texas fever, due to Piroplasma bigeminum in this country which has been eradicated in entire districts by destruction of the cattle tick (Margaropus annulatus).
Piroplasmoses in South Africa among cattle and horses, and in other countries are transmitted in similar ways. Probably many of the diseases due to spirochetes and trypanosomes are likewise transmitted by necessary insect intermediaries. In human medicine the eradication of yellow fever from Panama and Cuba is due to successful warfare against, a certain mosquito (Stegomyia). So the freeing of large areas in different parts of the world from malaria follows the destruction of the mosquitoes. The prevention of typhus fever and of trench fever by “delousing” methods is familiar from recent army experience though for typhus this method has been practiced in Russia for more than ten years to the author’s personal knowledge. The campaign against disease in animals and man from insect sources must be considered as still in its infancy. The full utilization of tropical lands depends largely on the solution of this problem.
A. The Skin.—If the skin is healthy there is no opportunity for bacteria to penetrate it. It is protected not only by the stratified epithelium, but also in various animals, by coats of hair, wool, feathers, etc. The secretion pressure of the healthy sweat and oil glands acts as an effective bar even to motile bacteria. Nevertheless a very slight injury only is sufficient to give normal surface parasites and other pathogenics, accidentally or purposely brought in contact with it, an opportunity for more rapid growth and even entrance for general infection. Certain diseases due to higher fungi are characteristically “skin diseases” and rarely become general—various forms of favus, trichophyton infections, etc. A few disease organisms, tetanus, malignant edema, usually get in through the skin; others, black-leg, anthrax, quite commonly; and those diseases transmitted by biting and blood-sucking insects, piroplasmoses, trypanosomiases, spirilloses, scarcely in any other way. Defective secretion in the skin glands from other causes, may permit lodgment and growth of bacteria in them or in the hair follicles. “Pimples” and boils in man and local abscesses occasionally in animals are illustrations. Sharp-edged and freely bleeding wounds are less liable to be infected than contusions, ragged wounds, burns, etc. The flowing blood washes out the wound and the clotting seals it, while there is less material to be repaired by the leukocytes and they are free to care for invading organisms (phagocytosis). Pathogenic organisms, especially pus cocci, frequently gain lodgment in the milk glands and cause local (mastitis) or general infection.
B. Mucosæ directly continuous with the skin and lined with stratified epithelium are commonly well protected thereby and by the secretions.
(a) The external auditory meatus is rarely the seat even of local infection. The tympanic cavity is normally sterile, though it may become infected by extension through the Eustachian tube from the pharynx (otitis media).
(b) The conjunctiva is frequently the seat of localized, very rarely the point of entrance for a generalized infection, except after severe injury. Those diseases whose path of entrance is generally assumed to be the respiratory tract (see “Lungs” below) might also be admitted through the eye. Material containing such organisms might get on the conjunctiva and be washed down through the lachrymal canal into the nose. Experiment has shown that bacteria may pass in this way in a few minutes. In case masks are worn to avoid infection from patients suffering with these diseases, the eyes should therefore be protected as well as the nose and mouth.
(c) The nasal cavity on account of its anatomical structure retains pathogenic organisms which give rise to local infections more frequently than other mucosæ of its character. These may extend from here to middle ear, neighboring sinuses, or along the lymph spaces of the olfactory nerve into the cranial cavity (meningitis). Acute coryza (“colds” in man) is characteristic. Glanders, occasionally, is primary in the nose, as is probably roup in chickens, leprosy in man. The meningococcus and the virus of poliomyelitis pass from the nose into the cranial cavity without local lesions in the former.
(d) The mouth cavity is ordinarily protected by its epithelium and secretions, though the injured mucosa is a common source of actinomycosis infection, as well as thrush. In foot-and-mouth disease no visible lesions seem necessary to permit the localization of the unknown infective agent.
(e) The tonsils afford a ready point of entrance for ever-present micrococci and streptococci whenever occasion offers (follicular tonsillitis, “quinsy”), and articular rheumatism is not an uncommon sequel. The diphtheria bacillus characteristically seeks these structures for its development. Tubercle and anthrax organisms occasionally enter here.
(f) The pharynx is the seat of localized infection as in micrococcal, streptococcal and diphtherial “sore throat” in human beings, but both it and the esophagus are rarely infected in animals except as the result of injury.
(g) The external genitalia are the usual points of entrance for the venereal organisms in man (gonococcus, Treponema pallidum, and Ducrey’s bacillus). The bacillus of contagious abortion and probably the trypanosome of dourine are commonly introduced through these channels in animals.
C. Lungs.—The varied types of pneumonia due to many different organisms (tubercle, glanders, influenza, plague bacilli, pneumococcus, streptococcus, micrococcus and many others) show how frequently these organs are the seat of a localized infection, which may or may not be general. Whether the lungs are the actual point of entrance in these cases is a question which is much discussed at the present time, particularly with reference to tuberculosis. The mucous secretion of the respiratory tract tends to catch incoming bacteria and other small particles and the ciliary movement along bronchial tubes and trachea tends to carry such material out. “Foreign body pneumonia” shows clinically, and many observers have shown experimentally that microörganisms may reach the alveoli even though the exchange of air between them and the bronchioles and larger bronchi takes place ordinarily only by diffusion. The presence of carbon particles in the walls of the alveoli in older animals and human beings and in those that breathe dusty air for long periods indicates strongly, though it does not prove absolutely, that these came in with inspired air. On the other hand, experiment has shown that tubercle bacilli introduced into the intestine may appear in the lungs and cause disease there and not in the intestine. It is probably safe to assume that in those diseases which are transmitted most readily through close association though not necessarily actual contact, the commonest path is through the respiratory tract, which may or may not show lesions (smallpox, scarlet fever, measles, chicken-pox, whooping-cough, pneumonic plague in man, lobar and bronchopneumonias and influenza in man and animals, some cases of glanders and tuberculosis). On the other hand, the fact that the Bacterium typhosum and Bacterium coli may cause pneumonia when they evidently have reached the lung from the intestinal tract, and the experimental evidence of lung tuberculosis above mentioned show that this route cannot be excluded in inflammations of the lung.
D. Alimentary Tract.—The alimentary tract affords the ordinary path of entrance for the causal microbes of many of the diseases of animals and man, since they are carried into the body most commonly and most abundantly in the food and drink.
(a) The stomach is rarely the seat of local infection, even in ruminants, except as the result of trauma. The character of the epithelium in the rumen, reticulum and omasum in ruminants, the hydrochloric acid in the abomasum and in the stomachs of animals generally are usually sufficient protection. Occasionally anthrax “pustules” develop in the gastric mucosa. (The author saw nine such pustules in a case of anthrax in a man.)
(b) The intestines are frequently the seat of localized infections, as various “choleras” and “dysenteries” in men and many animals, anthrax, tuberculosis, Johne’s disease. Here doubtless enter the organisms causing “hemorrhagic septicemias” in many classes of animals, and numerous others. These various organisms must have passed through the stomach and the question at once arises, why did the HCl not destroy them? It must be remembered that the acid is present only during stomach digestion, and that liquids taken on an “empty stomach” pass through rapidly and any organisms present are not subjected to the action of the acid. Also spores generally resist the acid. Other organisms may pass through the stomach within masses of undigested food. The fact that digestion is going on in the stomach of ruminants practically all the time may explain the relative freedom of adult animals of this class from “choleras” and “dysenteries.”
In the preceding chapters statements have been made that “bacteria enter” at various places or they “pass through” different mucous membranes, skin, etc. Strictly speaking such statements are incorrect—bacteria do not “enter” or “pass through” of themselves. It is true that some of the intestinal organisms are motile, but most of the bacteria which are pathogenic are non-motile. Even the motile ones can not make their way against fluids secreted or excreted on free surfaces. Bacteria cannot pass by diffusion through membranes since they are finite particles and not in solution.
In the case of penetrating wounds bacteria may be carried mechanically into the tissues, but this is exceptional in most infections. Also after gaining lodgment they may gradually grow through by destroying tissue as they grow, but this is a minor factor. Evidently, there must be some mechanism by which they are carried through. The known mechanisms for this in the body are ameboid cells, especially the phagocytes. It is most probable that these are the chief agents in getting bacteria into the tissues through various free surfaces. The phagocytes engulf bacteria, carry them into the tissues and either destroy them, are destroyed by them, or may disgorge or excrete them free in the tissues or in the blood.
Dissemination of organisms within the tissues occurs either through the lymph channels or the bloodvessels or both. If through the lymph vessels only it is usually much more restricted in extent, or much more slowly disseminated, while blood dissemination is characterized by the number of organs involved simultaneously.
I. Directly from the point, of injury. This is true in infected wounds open to the surface, skin glanders (farcy), black-leg, surface anthrax, exanthemata in man and animals (scarlet fever (?), measles (?), smallpox; hog erysipelas, foot-and-mouth disease): also in case of disease of mucous membranes continuous with the skin—from nasal discharges (glanders), saliva (foot-and-mouth disease), material coughed or sneezed out (tuberculosis, influenza, pneumonias), urethral and vaginal discharges (gonorrhea and syphilis in man, contagious abortion and dourine in animals), intestinal discharges (typhoid fever, “choleras,” “dysenteries,” anthrax, tuberculosis, Johne’s disease). Material from nose, mouth and lungs may be swallowed and the organisms passed out through the intestines.
II. Indirectly through the secretions and the excretions where the internal organs are involved. The saliva of rabid animals contains the ultramicroscopic virus of rabies (the sympathetic ganglia within the salivary glands, and pancreas also, are affected in this disease as well as the cells of the central nervous system). The gall-bladder in man is known to harbor colon and typhoid bacilli, as that of hog-cholera hogs does the virus of this disease. It may harbor analogous organisms in other animals, though such knowledge is scanty. The kidneys have been shown experimentally to excrete certain organisms introduced into the circulation within a few minutes (micrococci, colon and typhoid bacilli, anthrax). Typhoid bacilli occur in the urine of typhoid-fever patients in about 25 per cent. of all cases and the urine of hogs with hog cholera is highly virulent. Most observers are of the opinion, however, that under natural conditions the kidneys do not excrete bacteria unless they themselves are infected.
The milk both of tuberculous cattle and tuberculous women has been shown to contain tubercle bacilli even when the mammary glands are not involved. Doubtless such bacteria are carried through the walls of the secreting tubules or of the smaller ducts by phagocytes and are then set free in the milk.
It is readily apparent that certain disease organisms tend to locate themselves in definite regions and the question arises, Is this due to any specific relationship between organism and tissue or not? Diphtheria in man usually attacks the tonsils first, gonorrhea and syphilis the external genitals, tuberculosis the lung, “choleras” the small intestine, “dysenteries” the large intestine, influenza the lungs. In these cases the explanation is probably that the points attacked are the places where the organism is most commonly carried, with no specific relationship, since all of these organisms (Asiatic cholera excepted) also produce lesions in other parts of the body when they reach them. On the other hand, the virus of hydrophobia attacks nerve cells, leprosy frequently singles out nerves, glanders bacilli introduced into the abdominal cavity of a young male guinea-pig cause an inflammation of the testicle, malarial parasites and piroplasms attack the red blood corpuscles, etc. In fact, most pathogenic protozoa are specific in their localization either in certain tissue cells or in the blood or lymph. In these cases there is apparently a real chemical relationship, as there is also between the toxins of bacteria and certain tissue cells (tetanus toxin and nerve cells). Whether “chemotherapy” will ever profit from a knowledge of such chemical relationships remains to be developed. It appears that a search for these specific chemical substances with the object of combining poisons with them so that the organisms might in this way be destroyed, would be a profitable line of research.
Immunity, as has already been stated, implies such a condition of the body that pathogenic organisms after they have been introduced are incapable of manifesting themselves, and are unable to cause disease. The word has come to have a more specific meaning than resistance in many instances, in other cases the terms are used synonymously. It is the opposite of susceptibility. The term must be understood always in a relative sense, since no animal is immune to all pathogenic organisms, and conceivably not entirely so to anyone, because there is no question that a sufficient number of bacteria of any kind might be injected into the circulation to kill an animal, even though it did it purely mechanically.
Immunity may be considered with reference to a single individual or to entire divisions of the organic world, with all grades between. Thus plants are immune to the diseases affecting animals; invertebrates to vertebrate diseases; cold-blooded animals to those of warm blood; man is immune to most of the diseases affecting other mammals; the rat to anthrax, which affects other rodents and most mammals; the well-known race of Algerian sheep is likewise immune to anthrax while other sheep are susceptible; the negro appears more resistant to yellow fever than the white; some few individuals in a herd of hogs always escape an epizoötic of hog cholera, etc.
Immunity within a given species is modified by a number of factors—age, state of nutrition, extremes of heat or cold, fatigue, excesses of any kind, in fact, anything which tends to lower the “normal healthy tone” of an animal also tends to lower its resistance. Children appear more susceptible to scarlet fever, measles, whooping-cough, etc., than adults; young cattle more frequently have black-leg than older ones (these apparently greater susceptibilities may be due in part to the fact that most of the older individuals have had the diseases when young and are immune for this reason). Animals weakened by hunger or thirst succumb to infection more readily. Frogs and chickens are immune to tetanus, but if the former be put in water and warmed up to and kept, at about 37°, and the latter be chilled for several hours in ice-water, then each may be infected. Pneumonia frequently follows exposure to cold. The immune rat may be given anthrax if first he is made to run in a “squirrel cage” until exhausted. Alcoholics are far less resistant to infection than temperate individuals. “Worry,” mental anguish, tend to predispose to infection.
The following outlines summarize the different, classifications of immunity so far as mammals are concerned for the purposes of discussion.
Immunity present in an animal and not due to human interference is to be regarded as natural immunity, while if brought about by man’s effort it is considered artificial. Those cases of natural immunity mentioned above which are common to divisions, classes, orders, families, species or races of organisms and to those few individuals where no special cause is discoverable, must be regarded as instances of true inheritance through the germ cell as other characteristics are. All other kinds of immunity are acquired. Occasionally young are born with every evidence that they have had a disease in utero and are thereafter as immune as though the attack had occurred after birth (“small-pox babies,” “hog-cholera pigs”). Experiment has shown that immune substances may pass from the blood of the mother to the fetus in utero and the young be immune for a time after birth (tetanus). This is of no practical value as yet. It is a familiar fact that with most infectious diseases recovery from one attack confers a more or less lasting immunity, though there are marked exceptions.
Active Immunity.—By active immunity is meant that which is due to the actual introduction of the organism, or in some cases of its products. The term active is used because the body cells of the animal immunized perform the real work of bringing about the immunity as will be discussed later. In passive immunity the blood serum of an actively immunized animal is introduced into a second animal, which thereupon becomes immune, though its cells are not concerned in the process. The animal is passive, just as a test-tube, in which a reaction takes place, plays no other part than that of a passive container for the reagents.
In active immunity the organism may be introduced in what is to be considered a natural manner, as when an animal becomes infected, has a disease, without human interference. Or the organism may be purposely introduced to bring about the immunity. For certain purposes the introduction of the products of the organism (toxins) is used to bring about active immunity (preparation of diphtheria and tetanus antitoxin from the horse). The method of producing active immunity by the artificial introduction of the organism is called vaccination, and a vaccine must therefore contain the organism. Vaccines for bacterial diseases are frequently called bacterins. The use of the blood serum of an immunized animal to confer passive immunity on a second animal is properly called serum therapy, and the serum so used is spoken of as an antiserum, though the latter word is also used to denote any serum containing any kind of an antibody (Chapters XXVII–XXXI). In a few instances both the organism and an antiserum are used to cause both active and passive immunity (serum-simultaneous method in immunizing against hog cholera).
In producing active immunity the organism may be introduced (a) alive and virulent, but in very small doses, or in combination with an immune serum, as just mentioned for hog cholera. The introduction of the live virulent organism alone is done only experimentally as yet, as it is obviously too dangerous to do in practice, except under the strictest control (introduction of a single tubercle bacillus, followed by gradually increasing numbers—Barber and Webb). More commonly the organisms are introduced (b) alive but with their virulence reduced (“attenuated”) in one of several ways: (1) By passing the organism through another animal as is the case with smallpox vaccine derived from a calf or heifer. This method was first introduced by Jenner in 1795 and was the first practical means of preventing disease by vaccination. This word was used because material was derived from a cow—Latin vacca. (2) By drying the organism, as is done in the preparation of the vaccine for the Pasteur treatment of rabies, where the spinal cords of rabbits are dried for varying lengths of time—one to four days, Russian method, one to three days, German method, longer in this country. (It is probable that the passage of the “fixed virus” through the rabbit is as important in this procedure as the drying, since it is doubtful if the “fixed virus” is pathogenic for man.) It would be more correct to speak of this as a preventive vaccination against rabies, since the latter is one of the few diseases which is not amenable to treatment. The patient always dies if the disease develops. (3) The organism may be attenuated by growing at a temperature above the normal. This is the method used in preparing anthrax vaccine as done by Pasteur originally. (4) Instead of growing at a higher temperature the culture may be heated in such a way that it is not killed but merely weakened. Black-leg vaccines are made by this method. (5) Chemicals are sometimes added to attenuate the organisms, as was formerly done in the preparation of black-leg vaccine by Kruse’s method in Germany. The use of toxin-antitoxin mixtures in immunizing against diphtheria and in the preparation of diphtheria antitoxin from horses is an application of the same principle, though here it is the product of the organism and not the organism whose action is weakened. (6) Within the past few years the workers in the Pasteur Institute in Paris have been experimenting with vaccines prepared by treating living virulent bacteria with antisera (“sensitizing them”) so that they are no longer capable of causing the disease when introduced, but do cause the production of an active immunity. The method has been used with typhoid fever bacilli in man and seems to be successful. It remains to be tried out further before its worth is demonstrated (the procedure is more complicated and the chance for infection apparently much greater than by the use of killed cultures). The term sero-bacterins is used by manufacturers in this country to designate such bacterial vaccines. (7) Growing on artificial culture media reduces the virulence of most organisms after a longer or shorter time. This method has been tried with many organisms in the laboratory, but is not now used in practice. The difficulties are that the attenuation is very uncertain and that the organisms tend to regain their virulence when introduced into the body.
In producing active immunity against many bacterial diseases the organisms are introduced (c) dead. They are killed by heat or by chemicals, or by using both methods (Chapter XXX).
When the products of an organism are introduced the resulting immunity is against the products only and not against the organism. If the organism itself is introduced there results an immunity against it and in some cases also against the products, though the latter does not necessarily follow. Hence the immunity may be antibacterial or antitoxic or both.
Investigation as to the causes of immunity and the various methods by which it is produced has not resulted in the discovery of specific methods of treatment for as many diseases as was hoped for at one time. Just at present progress in serum therapy appears to be at a standstill, though vaccines are giving good results in many instances not believed possible a few years ago. As a consequence workers in all parts of the world are giving more and more attention to the search for specific chemical substances, which will destroy invading parasites and not injure the host (chemotherapy). Nevertheless, in the study of immunity very much of value in the treatment and prevention of disease has been learned. Also much knowledge which is of the greatest use in other lines has been accumulated. Methods of diagnosis of great exactness have resulted, applicable in numerous diseases. Ways of detecting adulteration in foods, particularly foods from animal sources, and of differentiating proteins of varied origin, as well as means of establishing biological relationships and differences among groups of animals through “immunity reactions” of blood serums have followed from knowledge gained by application of the facts or the methods of immunity research. Hence the study of “immunity problems” has come to include much more than merely the study of those factors which prevent the development of disease in an animal or result in its spontaneous recovery. A proper understanding of the principles of immunity necessitates a study of these various features and they will be considered in the discussion to follow.
Pasteur and the bacteriologists of his time discovered that bacteria cease to grow in artificial culture media after a time, because of the exhaustion of the food material in some cases and because of the injurious action of their own products in other instances. These facts were brought forward to explain immunity shortly after bacteria were shown to be the cause of certain diseases. Theories based on these observations were called (1) “Exhaustion Theory” of Pasteur, and (2) “Noxious Retention Theory” of Chauveau respectively. The fact, soon discovered, that virulent pathogenic bacteria are not uncommonly present in perfectly healthy animals, and the later discovery that immunity may be conferred by the injection of dead bacteria have led to the abandonment of both these older ideas. The (3) “Unfavorable Environment” theory of Baumgartner, i.e., bacteria do not grow in the body and produce disease because their surroundings are not suitable, in a sense covers the whole ground, though it is not true as to the first part, as was pointed out above, and is of no value as a working basis, since it offers no explanation as to what the factors are that constitute the “unfavorable environment.” Metchnikoff brought forward a rational explanation of immunity with his (4) “Cellular or Phagocytosis Theory.” As first propounded it based immunity on the observed fact that certain white blood corpuscles, phagocytes, engulf and destroy bacteria. Metchnikoff has since elaborated the original theory to explain facts of later discovery. Ehrlich soon after published his (5) “Chemical or Side-chain Theory” which seeks to explain immunity on the basis of chemical substances in the body which may in part destroy pathogenic organisms or in part neutralize their products; or in some instances there may be an absence of certain chemical substances in the body cells so that bacteria or their products cannot unite with the cells and hence can do no damage.
At the present time it is generally accepted, in this country at least, that Ehrlich’s theory explains immunity in many diseases as well as many of the phenomena related to immunity, and in other diseases the phagocytes, frequently assisted by chemical substances, are the chief factors. Specific instances are discussed in Pathogenic Bacteriologies which should be consulted. It is essential that the student should be familiar with the basic ideas of the chemical theory, not only from the standpoint of immunity, but also in order to understand the principles of a number of valuable methods of diagnosis.
The chemical theory rests on three fundamental physiological principles: (1) the response of cells to stimuli, in this connection specific chemical stimuli, (2) the presence within cells of specific chemical groups which combine with chemical stimuli and thus enable them to act on the cell, which groups Ehrlich has named receptors, and (3) the “over-production” activity of cells as announced by Weigert.
1. That cells respond to stimuli is fundamental in physiology. These stimuli may be of many kinds as mechanical, electrical, light, thermal, chemical, etc. The body possesses groups of cells specially developed to receive some of these stimuli—touch cells for mechanical stimuli, retinal cells for light, temperature nerve endings for thermal, olfactory and gustatory cells for certain chemical stimuli. Response to chemical stimuli is well illustrated along the digestive tract. That the chemical stimuli in digestion may be more or less specific is shown by the observed differences in the enzymes of the pancreatic juice dependent on the relative amounts of carbohydrates, fats, or proteins in the food, the specific enzyme in each case being increased in the juice with the increase of its corresponding foodstuff. The cells of the body, or certain of them at least, seem to respond in a specific way when substances are brought into direct contact with them, that is, without having been subjected to digestion in the alimentary tract, but injected directly into the blood or lymph stream. Cells may be affected by stimuli in one of three ways: if the stimulus is too weak, there is no effect (in reality there is no “stimulus” acting); if the stimulus is too strong, the cell is injured, or may be destroyed; if the stimulus is of proper amount then it excites the cell to increased activity, and in the case of specific chemical stimuli the increased activity, as mentioned for the pancreas, shows itself in an increased production of whatever is called forth by the chemical stimulus. In the case of many organic chemicals, the substances produced by the cells under their direct stimulation are markedly specific for the particular substance introduced.
2. Since chemical action always implies at least two bodies to react, Ehrlich assumes that in every cell which is affected by a chemical stimulus there must therefore be a chemical group to unite with this stimulus. He further states that there must be as many different kinds of these groups as there are different kinds of chemicals which stimulate the cell. Since these groups are present in the body cells to take up different kinds of chemical substances, Ehrlich calls them receptors. Since these groups must be small as compared with the cell as a whole, and must be more or less on the surface and unite readily with chemical substances he further speaks of them as “side-chains” after the analogy of compounds of the aromatic series especially. The term receptors is now generally used. As was stated above, the effect of specific chemical stimuli is to cause the production of more of the particular substance for which it is specific and in the class of bodies under discussion, the particular product is these cell receptors with which the chemical may unite.
3. Weigert first called attention to the practically constant phenomenon that cells ordinarily respond by doing more of a particular response than is actually called for by the stimulus, that there is always an “overproduction” of activity. In the case of chemical stimuli this means an increased production of the specific substance over and above the amount actually needed.
The student will better understand this theory if he recalls his fundamental physiology. Living substance is characterized, among other things, by irritability which is instability. It is in a constant, state of unstable equilibrium. Whenever the equilibrium becomes permanently stable the substance is dead. It is also continually attempting to restore disturbances in its equilibrium. Whenever a chemical substance unites with a chemical substance in the cell, a receptor, the latter is, so far as the cell is concerned, thrown out of function for that cell. The chemical equilibrium of the latter is upset. It attempts to restore this and does so by making a new receptor to take the place of the one thrown out of function. If this process is continued, i.e., if the new receptor is similarly “used up” and others similarly formed are also, then the cell will prepare a supply of these and even an excess, according to Weigert’s theory. Whenever a cell accumulates an excess of products the normal result is that it excretes them from its own substance into the surrounding lymph, whence they reach the blood stream to be either carried to the true excretory organs, utilized by other cells or remain for a longer or shorter time in the blood. Hence the excess of receptors is excreted from the cell that forms them and they become free in the blood. These free receptors are termed antibodies. They are receptors but instead of being retained in the cell are free in solution in the blood. One function of the free receptor, the antibody, is always to unite with the chemical substance which caused it to be formed. It may have additional functions. The chemical substance which caused the excess formation of receptors, antibodies, is termed an antigen for that particular kind of antibody.
To recapitulate, Ehrlich’s theory postulates specific chemical stimuli, which react with specific chemical substances in the body cells, named receptors, and that these receptors, according to Weigert, are produced in excess and hence are excreted from the cell and become free receptors in the blood and lymph. These free receptors are the various kinds of antibodies, the kind depending on the nature of the stimulus, antigen, the substance introduced. Any substance which when introduced into the body causes the formation of an antibody of any kind whatsoever is called an antigen,23 i.e., anti (body) former.
The foregoing discussion explains Ehrlich’s theory of immunity. According to this theory the manner of formation of all antibodies is the same. The kind of antibody and the manner of its action will differ with the different kinds of antigens used.
The succeeding chapters discuss some of the kinds of antibodies, the theory of their action and some practical applications. It must be borne in mind throughout the study of these, as has been stated, that every antibody has the property of uniting with its antigen whether it has any property in addition or not.
Just what antibodies are chemically has not been determined because no one has as yet succeeded in isolating them chemically pure. To the author they appear to be enzymes.
Antigens were considered by Ehrlich to be proteins or to be related to proteins. Most workers since Ehrlich have held similar views. Dr. Carl Warden of the University of Michigan has been doing much work in recent years in which he is attempting to show that the antigens are not proteins but are fats or fatty acids. Mr. E. E. H. Boyer, in his work (not yet published) in the author’s laboratory for the degree of Ph.D., received in June, 1920, succeeded in producing various antibodies from Bacterium coli antigens. In these antigens he could detect only fatty acids or salts of fatty acids. If the work of these men is confirmed, it will open up a most interesting and extremely important field in immunity and in preventive medicine. It is not apparent that the nature of the antigen would affect Ehrlich’s theory of the formation of antibodies.
The author has no doubt that eventually the formation of antibodies and the reactions between them and their antigens will be explained on the basis of physical-chemical laws, but this probably awaits the discovery of their nature.
The general characteristics of toxins have been described (Chapter XII). It has been stated that they are more or less specific in their action on cells. In order to affect a cell it is evident that a toxin must enter into chemical combination with it. This implies that the toxin molecule possesses a chemical group which can combine with a receptor of the cell. This group is called the haptophore or combining group. The toxic or injurious portion of the toxin molecule is likewise spoken of as the toxophore group. When a toxin is introduced into the body its haptophore group combines with suitable receptors in different cells of the body. If not too much of the toxin is given, instead of injuring, it acts as a chemical stimulus to the cell in the manner already described. The cell in response produces more of the specific thing, which in this instance is more receptors which can combine with the toxin, i.e., with its haptophore group. If the stimulus is kept up, more and more of these receptors are produced until an excess for the cell accumulates, which excess is excreted from the individual cell and becomes free in the blood. These free receptors have, of course, the capacity to combine with toxin through its haptophore group. When the toxin is combined with these free receptors, it cannot combine with any other receptors, e.g., those in another cell and hence cannot injure another cell. These free receptors constitute, in this case, antitoxin, so-called because they can combine with toxin and hence neutralize it. Antitoxins are specific—that is, an antitoxin which will combine with the toxin of Clostridium tetani will not combine with that of Corynebacterium diphtheriæ or of Clostridium botulinum, or of any other toxin, vegetable or animal.
When a toxin is kept in solution for some time or when it is heated above a certain temperature (different for each toxin) it loses its poisonous character. It may be shown, however, that it is still capable of uniting with antitoxin, and preventing the latter from uniting with a fresh toxin. This confirms the hypothesis that a toxin molecule has at least two groups: a combining or haptophore, and a poisoning or toxophore group. A toxin which has lost its poisonous property, its toxophore group, is spoken of as a toxoid. The theory of antitoxin formation is further supported by the fact that the proper introduction of toxoid, the haptophore group, and hence the real stimulus, can cause the production of antitoxin to a certain extent at least.
The close relationship between toxins and enzymes has already been pointed out. This is still further illustrated by the fact that when enzymes are properly introduced into the tissues of an animal there is formed in the animal an antienzyme specific for the enzyme in question which can prevent its action. The structure of enzymes, as composed of a haptophore, or uniting, and a zymophore or digesting (or other activity) group, is similar to that of toxins, and enzymoids or enzymes which can combine with the substance acted on but not affect it further, have been demonstrated.
These free cell receptors, antitoxins or antienzymes, which are produced in the body by the proper introduction of toxins or enzymes, respectively, have the function of combining with these bodies but no other action. As was pointed out above, this is sufficient to neutralize the toxin or enzyme and prevent any injurious effect since they can unite with nothing else. Since these receptors are the simplest type which has been studied as yet, they are spoken of by Ehrlich as receptors of the first order. Other antibodies which are likewise free receptors of the first, order and have the function of combining only have been prepared and will be referred to in their proper connection. They are mainly of theoretical interest.
Ehrlich did a large part of his work on toxins and antitoxins with ricin, the toxin of the castor-oil bean, abrin, from the jequirity bean, robin from the locust tree, and with the toxins and antitoxins for diphtheria and tetanus. Antitoxins have been prepared experimentally for a large number of both animal and vegetable poisons, including a number for bacterial toxins. The only ones which, as yet, are of much practical importance are antivenin for snake poison, (not a true toxin, however, see p. 275), antipollenin (supposed to be for the toxin of hay fever) and the antitoxins for the true bacterial toxins of Corynebacterium diphtheriæ and Clostridium tetani.
The method of preparing antitoxins is essentially the same in all cases, though differing in minor details. For commercial purposes large animals are selected, usually horses, so that the yield of serum may be large. The animals must, of course, be vigorous, free from all infectious disease. The first injection given is either a relatively small amount of a solution of toxin or of a mixture of toxin and antitoxin. The animal shows more or less reaction, increased temperature, pulse and respiration and frequently an edema at the point of injection, unless this is made intravenously. After several days to a week or more, when the animal has recovered from the first injection, a second stronger dose is given, usually with less reaction. Increasingly large doses are given at proper intervals until the animal may take several hundred times the amount which would have been fatal if given at first. The process of immunizing a horse for diphtheria or tetanus toxin usually takes several months. Variations in time and in yield of antitoxin are individual and not predictable in any given case.
After several injections a few hundred cubic centimeters of blood are withdrawn from the jugular vein and serum from this is tested for the amount of antitoxin it contains. When the amount is found sufficiently large (250 “units” at least for diphtheria per cc.)24 then the maximum amount of blood is collected from the jugular with sterile trocar and cannula. The serum from this blood with the addition of an antiseptic (0.5 per cent. phenol, tricresol, etc.) constitutes “antidiphtheritic serum” or “antitetanic serum,” etc. All sera which are put on the market must conform to definite standards of strength expressed in “units” as determined by the U. S. Hygienic Laboratory. In reality a “unit” of diphtheria antitoxin in the United States is an amount equivalent to 1 cc. of a given solution of a standard diphtheria antitoxin which is kept at the above-mentioned laboratory. This statement, of course, gives no definite idea as to the amount of antitoxin actually in a “unit.” Specifically stated, a “unit” of antitoxin contains approximately the amount which would protect a 250 gram guinea-pig from 100 minimum lethal doses of diphtheria toxin, or protect 100 guinea-pigs weighing 250 grams each from one minimum lethal dose each. The minimum lethal dose (M. L. D.) of diphtheria toxin is the least amount that will kill a guinea-pig of the size mentioned within four days. Since toxins on standing change into toxoids to a great extent, the amount, of antitoxin in a “unit,” though protecting against 100 M. L. D., in reality would protect against about 200 M. L. D. of toxin containing no toxoid.
The official unit for tetanus antitoxin is somewhat different, since it is standardized against a standard toxin which is likewise kept at the Hygienic Laboratory. The unit is defined as “ten times the amount of antitoxin necessary to protect a 350 g. guinea-pig for 96 hours against the standard test dose” of the standard toxin. The standard test dose is 100 M. L. D. of toxin for a 350 g. guinea-pig. To express it another way, one could say that a “unit” of tetanus antitoxin would protect one thousand 350 g. guinea-pigs from 1 M. L. D. each of standard tetanus toxin.
Various methods have been devised for increasing the amount of antitoxin in 1 cc. of solution by precipitating out portions of the blood-serum proteins and at the same time concentrating the antitoxin in smaller volume. It is not considered necessary in a work of this character to enter into these details nor to discuss the process of standardizing antitoxin so that the exact amount of “units” per cc. may be known.
Charrin and Rogers appear to have been the first (1889) to observe the clumping together of bacteria (Pseudomonas pyocyanea) when mixed with the blood serum of an animal immunized against them. Gruber and Durham (1896) first used the term “agglutination” in this connection and called the substance in the blood-serum “agglutinin.” Widal (1896) showed the importance of the reaction for diagnosis by testing the blood serum of an infected person against a known culture (typhoid fever).
It is now a well-known phenomenon that the proper injection of cells of any kind foreign to a given animal will lead to the accumulation in the animal’s blood of substances which will cause a clumping together of the cells used when suspended in a suitable liquid. The cells settle out of such suspension much more rapidly than they would otherwise do. This clumping is spoken of as “agglutination” and the substances produced in the animal are called “agglutinins.” If blood cells are injected then “hemagglutinins” result: if bacterial cells “bacterial agglutinins” for the particular organism used as “glanders agglutinin” for Pfeifferella mallei, “abortion agglutinin” for Bacterium abortus, “typhoid agglutinin” for Bacterium typhosum, etc.
The phenomenon may be observed either under the microscope or in small test-tubes, that is, either microscopically or macroscopically.
In this case the cells introduced, or more properly, some substances within the cells, act as stimuli to the body cells of the animal injected to cause them to produce more of the specific cell receptors which respond to the stimulus. The substance within the introduced cell which acts as a stimulus (antigen) to the body cells is called an “agglutinogen.” That “agglutinogen” is present in the cell has been shown by injecting animals experimentally with extracts of cells (bacterial and other cells) and the blood serum of the animal injected showed the presence of agglutinin for the given cell. It will be noticed that the receptors which become the free agglutinins have at least two functions, hence at least two chemical groups. They must combine with the foreign cells and also bring about their clumping together, their agglutination. Hence it can be stated technically that an agglutinin possesses a haptophore group and an agglutinating group.
It is probable that the agglutination, the clumping, is a secondary phenomenon depending on the presence of certain salts and that the agglutinin acts on its antigen as an enzyme, possibly a “splitting” enzyme. This is analogous to what occurs in the curdling of milk by rennet and in the coagulation of blood. This probability is substantiated by the fact that suspensions of bacteria may be “agglutinated” by appropriate strengths of various acids.
The formation of agglutinin in the body for different bacteria does not as yet appear to be of any special significance in protecting the animal from the organism, since the bacteria are not killed, even though they are rendered non-motile, if of the class provided with flagella, and are clumped together. The fact that such bodies are formed, however, is of decided value in the diagnosis of disease, and also in the identification of unknown bacteria.
In many bacterial diseases, agglutinins for the particular organism are present in the blood serum of the affected animal. Consequently if the blood serum of the animal be mixed with a suspension of the organism supposed to be the cause of the disease and the latter be agglutinated, one is justified in considering it the causative agent, provided certain necessary conditions are fulfilled. In the first place it must be remembered that the blood of normal animals frequently contains agglutinins (“normal agglutinins”) for many different bacteria when mixed with them in full strength. Hence the serum must always be diluted with physiological salt solution (0.85 per cent.). Further, closely related bacteria may be agglutinated to some extent by the same serum. It is evident that if they are closely related, their protoplasm must contain some substances of the same kind to account for this relationship. Since some of these substances may be agglutinogens, their introduction into the animal body will give rise to agglutinins for the related cells, as well as for the cell introduced. The agglutinins for the cell introduced “chief agglutinins,” will be formed in larger quantity, since a given bacterial cell must contain more of its own agglutinogen than that of any other cell. By diluting the blood serum from the animal to be tested the agglutinins for the related organisms (so-called “coagglutinins” or “partial agglutinins”) will become so much diminished as to show no action, while the agglutinin for the specific organism is still present in an amount sufficient to cause its clumping. Agglutinins are specific for their particular agglutinogens, but since a given blood serum may contain many agglutinins, the serum’s specificity for a given bacterium can be determined only by diluting it until this bacterium alone is agglutinated. Hence the necessity of diluting the unknown serum in varying amounts when testing against several known bacteria to determine for which it is specific, i.e., which is the cause of the disease in the animal.
The agglutinins in the serum may be removed from it by treating it with a suspension of the cells for which agglutinins are present. If the “chief” cell is used all the agglutinins will be absorbed. If related cells are used, only the agglutinins for this particular kind are removed. These “absorption tests” furnish another means of determining specificity of serum, or rather of determining the “chief agglutinin” present.
Just as an unidentified disease in an animal may be determined by testing its serum as above described against known kinds of bacteria, so unknown bacteria isolated from an animal, from water, etc., may be identified by testing them against the blood sera of different animals, each of which has been properly inoculated with a different kind of known bacteria. If the unknown organism is agglutinated by the blood of one of the animals in high dilution, and not by the others, evidently the bacterium is the same as that with which the animal has been inoculated, or immunized, as is usually stated. This method of identifying cultures of bacteria is of wide application, but is used practically only in those cases where other methods of identification are not readily applied, and especially where other methods are not sufficient as in the “intestinal group” of organisms in human practice.
The diagnosis of disease in an animal by testing its serum is also a valuable and much used procedure. This is the method of the “Widal” or “Gruber-Widal” test for typhoid fever in man and is used in veterinary practice in testing for glanders, contagious abortion, etc. In some cases a dilution of the serum of from 20 to 50 times is sufficient for diagnosis (Malta fever), in most cases, however, 50 times is the lowest limit. Evidently the greater the dilution, that is, the higher the “titer,” the more specific is the reaction.
Since agglutinins act on bacteria, probably through the presence of substances within the bacterial cell, it is reasonable to expect that if these substances be dissolved out of the cell, there would be some reaction between their (colloidal) solution and the same serum. As a matter of fact Kraus (1897) showed that broth cultures freed from bacteria by porcelain filters do show a precipitate when mixed with the serum of an animal immunized against the particular bacterium and that the reaction is specific under proper conditions of dilution. It was not long after Kraus’s work until the experiments were tried of “immunizing” an animal not against a bacterium or its filtered culture, but against (colloidal) solutions of proteins, such as white of egg, casein of milk, proteins of meat and of blood serum, vegetable proteins, etc. It was ascertained that in all these cases the animal’s serum contains a substance which causes a precipitate with solutions of the protein used for immunization. The number of such precipitating serums that have been made experimentally is very large and it appears that protein from any source when properly introduced into the blood or tissues of an animal will cause the formation of a precipitating substance for its solutions. This substance is known, technically as a “precipitin.” The protein used as antigen to stimulate its formation, or some part of the protein molecule (haptophore group), which acts as stimulus to the cell is spoken of as a “precipitinogen,” both terms after the analogy of “agglutinin” and “agglutinogen.” In fact the specific precipitation and agglutination are strictly analogous phenomena. Precipitins act on proteins in (colloidal) solution and cause them to settle out, agglutinins act on substances within cells which cells are in suspension in a fluid and cause the cells to settle out. Ehrlich’s theory of the formation of precipitins is similar to that of agglutinins, and need not be repeated. Substitute the corresponding words in the theory of formation of agglutinins as above given and the theory applies.
The precipitin reaction has not found much practical use in bacteriology largely because the “agglutination test” takes its place as simpler of performance and just as accurate. The reaction is, however, generally applicable to filtrates of bacterial cultures and could be used if needed. The so-called “mallease” reaction in glanders is an instance.
Precipitins find their greatest usefulness in legal medicine and in food adulteration work. As was noted above, if animals, rabbits for example, are immunized with the blood of another animal (human beings) precipitins are developed which are specific for the injected blood with proper dilution. This forms an extremely valuable means of determining the kind of blood present in a given spot shown by chemical and spectroscopic tests to be blood and has been adopted as a legal test in countries where such rules of procedure are applied. Similarly the test has been used to identify the different kinds of meat in sausage, and different kinds of milk in a mixture. An extract of the sausage is made and tested against the serum of an animal previously treated with extract of horse meat, or hog meat, or beef, etc., the specific precipitate occurring with the specific serum. Such reactions have been obtained where the protein to be tested was diluted 100,000 times and more. Biological relationships and differences have been detected by the reaction. Human immune serum shows no reaction with the blood of any animals except to a slight extent with that of various monkeys, most with the higher, very slight with the lower Old World and scarcely any with New World monkeys.
It is a fact of theoretical interest mainly that if agglutinins and precipitins themselves be injected into an animal they will act as antigens and cause the formation of antiagglutinins or antiprecipitins, which are therefore receptors of the first order since they simply combine with these immune bodies to neutralize their action, have only a combining or haptophore group. Also if agglutinins or precipitins be heated to the proper temperature they may retain their combining power but cause no agglutination or precipitation, i.e., they are converted into agglutinoid or precipitinoid respectively after the analogy of toxin and toxoid.
Precipitins like agglutinins possess at least two groups—a combining or haptophore group and a precipitating (sometimes called zymophore) group. Hence they are somewhat more complex than antitoxins or antienzymes which have a combining group only. For this reason Ehrlich classes agglutinins and precipitins as receptors of the second order.
Before Koch definitely proved bacteria capable of causing disease several physiologists had noted that the red corpuscles of certain animals were destroyed by the blood of other animals (Creite, 1869, Landois, 1875), and Traube and Gescheidel had shown that freshly drawn blood destroys bacteria (1874). It was not until about ten years afterward that this action of the blood began to be investigated in connection with the subject of immunity. Von Fodor (1885) showed that saprophytic bacteria injected into the blood are rapidly destroyed. Flügge and his pupils, especially Nuttall in combating Metchnikoff’s theory of phagocytosis, announced in 1883, studied the action of the blood on bacteria and showed its destructive effect (1885–57). Nuttall also showed that the blood lost this power if heated to 56°. Buchner (1889) gave the name “alexin” (from the Greek “to ward off”) to the destroying substance and showed that the substance was present in the blood serum as well as in the whole blood, and that when the serum lost its power to dissolve, this could be restored by adding fresh blood. Pfeiffer (1894) showed that the destructive power of the blood of animals immunized against bacteria (cholera and typhoid) was markedly specific for the bacteria used. He introduced a mixture of the blood and the bacteria into the abdominal cavity of the immunized animal or of a normal one of the same species and noted the rapid solution of the bacteria by withdrawing portions of the peritoneal fluid and examining them (“Pfeiffer’s phenomenon”). Belfanti and Carbone and especially Bordet (1898) showed the specific dissolving action of the serum of one animal on the blood corpuscles of another animal with which it had been injected. Since this time the phenomenon has been observed with a great variety of cells other than red blood corpuscles and bacteria—leukocytes, spermatozoa, cells from liver, kidney, brain, epithelia, etc., protozoa, and many vegetable cells.
It is therefore a well-established fact that the proper injection of an animal with almost any cell foreign to it will lead to the blood of the animal injected acquiring the power to injure or destroy cells of the same kind as those introduced. The destroying power of the blood has been variously called its “cytotoxic” or “cytolytic” power, though the terms are not strictly synonymous since “cytotoxic” means “cell poisoning” or “injuring,” while “cytolytic” means “cell dissolving.” The latter term is the one generally used and there is said to be present in the blood a specific “cytolysin.” The term is a general one and a given cytolysin is named from the cell which is dissolved, as a bacteriolysin, a hemolysin (red-corpuscle-lysin), epitheliolysin, nephrolysin (for kidney cells), etc. If the cell is killed but not dissolved the suffix “cidin” or “toxin” is frequently used as “bacteriocidin,” “spermotoxin,” “neurotoxin,” etc.
The use of the term “cytolysin” is also not strictly correct, though convenient, for the process is more complex than if one substance only were employed. As was stated above, the immune serum loses its power to dissolve the cell if it is heated to 55° to 56° for half an hour, it is inactivated. But if there be added to the heated or inactivated serum a small amount of normal serum (which contains only a very little cytolytic substance, so that it has no dissolving power when so diluted) the mixture again becomes cytolytic. It is evident then that in cytolysis there are two distinct substances involved, one which is present in all serum, normal or immune, and the other present only in the immune cytolytic serum. This may be more apparent if the facts are arranged in the following form:
Therefore, there is something in heated immune serum necessary for cell dissolving and something different in diluted normal serum which is necessary. This latter something is present in unheated immune serum also, and is destroyed by heat. Experiment has shown that it is the substance present in all serum both normal and immune that is the true dissolving body, while the immune substance serves to unite this body to the cell to be destroyed, i.e., to the antigen. Since the immune body has therefore two uniting groups, one for the dissolving substance and one for the cell to be dissolved, Ehrlich calls it the “amboceptor.” He also uses the word “complement” to denote the dissolving substance, giving the idea that it completes the action of dissolving after it has been united to the cell by the amboceptor, thus replacing Buchner’s older term “alexin” for the same dissolving body.
The theory of formation of amboceptors is similar to that for the formation of the other types of antibodies. The cell introduced contains some substance, which acts as a chemical stimulus to some of the body cells provided with proper receptors so that more of these special receptors are produced, and eventually in excess so that they become free in the blood and constitute the free amboceptors. It will be noticed that these free receptors differ from either of the two kinds already described in that they have two uniting groups, one for the antigen (cell introduced) named cytophil-haptophore, the other for the complement, complementophil haptophore. Hence amboceptors are spoken of as receptors of the third order. They have no other function than that of this double combining power. The action which results is due to the third body—the complement. It will be readily seen that complement must possess at least two groups, a combining or haptophore group which unites with the amboceptor, and an active group which is usually called the zymophore or toxophore group. Complements thus resemble either toxins, where the specific cell (antigen) is injured or killed, or enzymes, in case the cell is likewise dissolved. This action again shows the close relation between toxins and enzymes. Complement may lose its active group in the same way that toxin does and becomes then complementoid. Complement is readily destroyed in blood or serum by heating it to 55° to 56° for half an hour, and is also destroyed spontaneously when serum stands for a day or two, less rapidly at low temperature than at room temperature.
Amboceptors appear to be specific in the same sense that agglutinins are. That is, if a given cell is used to immunize an animal, the animal’s blood will contain amboceptors for the cell used and also for others closely related to it. Immunization with spermatozoa or with epithelial or liver cells gives rise to amboceptors for these cells and also for red blood corpuscles and other body cells. A typhoid bactericidal serum has also some dissolving effect on colon bacilli, etc. Hence a given serum may contain a chief amboceptor and a variety of “coamboceptors,” or one amboceptor made up of a number of “partial amboceptors” each specific for its own antigen (“amboceptorogen”). Amboceptors may combine with other substances than antigen and complement, as is shown by their union with lecithin and other “lipoids,” though these substances seem capable of acting as complement in causing solution of blood corpuscles.
As to whether complements are numerous, as Ehrlich claims, or there is only one complement, according to Buchner and others, need not be discussed here. In the practical applications given later as means of diagnosis it is apparent that all the complement or complements are capable of uniting with at least two kinds of amboceptors.
If complement be injected into an animal it may act as an antigen and give rise to the formation of anticomplement which may combine with it and prevent its action and is consequently analogous to antitoxin. If amboceptors as antigen are injected into an animal there will be formed by the animal’s cells antiamboceptors. As one would expect, there are two kinds of antiamboceptors, one for each of its combining groups, since it has been stated that it is always the combining group of any given antigen that acts as the cell stimulus. Hence we may have an “anticytophil amboceptor” or an “anticomplementophil amboceptor.” These antiamboceptors and the anticomplements are analogous to antitoxin, antiagglutinin, etc., and hence are receptors of the first order.
A practical use of antiamboceptors is in antisnake venoms. Snake poisons appear to contain only amboceptors for different cells of the body. In the most deadly the amboceptor is specific for nerve cells (cobra), in others for red corpuscles, or for endothelial cells of the bloodvessels (rattlesnake). The complement is furnished by the blood of the individual bitten, that is, in a sense the individual poisons himself, since he furnishes the destroying element. The antisera contain antiamboceptors which unite with the amboceptor introduced and prevent it joining to cells and thus binding the complement to the cells and destroying them. With this exception these antibodies are chiefly of theoretical interest.
The discovery of the possibility of producing a strongly bactericidal serum in the manner above described aroused the hope that such sera would prove of great value in passive immunization and serum treatment of bacterial diseases. Unfortunately such expectations have not been realized and no serum of this character of much practical importance has been developed as yet (with the possible exception of Flexner’s antimeningococcus serum in human practice. What hog cholera serum is remains to be discovered).
The reasons for the failure of such sera are not entirely clear. The following are some that have been offered: (1) Amboceptors do not appear to be present in very large amount so that relatively large injections of blood are necessary, which is not without risk in itself. (2) Since the complement is furnished by the blood of the animal to be treated, there may not be enough of this to unite with a sufficient quantity of amboceptor to destroy all the bacteria present, hence the disease is continued by those that escape. (3) Or the complement may not be of the right kind to unite with the amboceptor introduced, since this is derived from the blood of a heterologous (“other kind”) species. In hog-cholera serum, if it is bactericidal, this difficulty is removed by using blood of a homologous (“same kind”) animal. Hence Ehrlich suggested the use of apes for preparing bactericidal sera for human beings. The good results which have been reported in the treatment of human beings with the serum of persons convalescing from the same disease indicate that this lack of proper complement for the given amboceptor is probably a chief factor in the failure of sera from lower animals. (4) The bacteria may be localized in tissues (lymph glands), within cavities (cranial, peritoneal), in hollow organs (alimentary tract), etc., so that it is not possible to get at them with sufficient serum to destroy all. This difficulty is obviated by injecting directly into the spinal canal when Flexner’s antimeningococcus serum is used. (5) Even if the bacteria are dissolved it does not necessarily follow that their endotoxins are destroyed. These may be merely liberated and add to the danger of the patient, though this does not appear to be a valid objection. (6) Complement which is present in such a large excess of amboceptor may just as well unite with amboceptor which is not united to the bacteria to be destroyed as with that which is, and hence be actually prevented from dissolving the bacteria. Therefore it is difficult to standardize the serum to get a proper amount of amboceptor for the complement present.
Although little practical use has been made of bactericidal sera, the discovery of receptors of this class and the peculiar relations between the antigen, amboceptor and complement have resulted in developing one of the most delicate and accurate methods for the diagnosis of disease and for the recognition of small amounts of specific protein that is in use today.
This method is usually spoken of as the “complement-fixation” or the “complement-deviation test” (“Wassermann test” in syphilis) and is applicable in a great variety of microbial diseases, but it is of practical importance in those diseases only where other methods are uncertain—syphilis in man, concealed glanders in horses, contagious abortion in cattle, etc. A better name would be the “Unknown Amboceptor Test” since it is the amboceptor that is searched for in the test by making use of its power to “fix” complement.
The principle is the same in all cases. The method depends, as indicated above, on the ability of complement to combine with at least two amboceptor-antigen systems, and on the further fact that if the combination with one amboceptor-antigen system is once formed, it does not dissociate so as to liberate the complement for union with the second amboceptor-antigen system. If an animal is infected with a microörganism and a part of its defensive action consists in destroying the organisms in its blood or lymph, then it follows from the above discussion of cytolysins that there will be developed in the blood of the animal amboceptor specific for the organism in question. If the presence of this specific amboceptor can be detected, the conclusion is warranted that the organism for which it is specific is the cause of the disease. Consequently what is sought in the “complement-fixation test” is a specific amboceptor. In carrying out the test, blood serum from the suspected animal is collected, heated at 56° for half an hour to destroy any complement it contains and mixed in definite proportions with the specific antigen and with complement. The antigen is an extract of a diseased organ (syphilitic fetal liver, in syphilis), a suspension of the known bacteria, or an extract of these bacteria. Complement is usually derived from a guinea-pig, since the serum of this animal is higher in complement than that of most animals. The blood of the gray rat contains practically as much. If the specific amboceptor is present, that is, if the animal is infected with the suspected disease, the complement will unite with the antigen-amboceptor system and be “fixed,” that is, be no longer capable of uniting with any other amboceptor-antigen system. No chemical or physical means of telling whether this union has occurred or not, except as given below, has been discovered as yet, though doubtless will be by physico-chemical tests, nor can the combination be seen. Hence an “indicator,” as is so frequently used in chemistry, is put into the mixture of antigen-amboceptor-complement after it has been allowed to stand in the incubator for one-half to one hour to permit the union to become complete. The “indicator” used is a mixture of sheep’s corpuscles and the heated (“inactivated”) blood serum of a rabbit which has been injected with sheep’s blood corpuscles and therefore contains a hemolytic amboceptor specific for the corpuscles which is capable also of uniting with complement. The indicator is put into the first mixture and the whole is again incubated and examined. If the mixture is clear and colorless with a deposit of red corpuscles at the bottom, that would mean that the complement had been bound to the first complex, since it was not free to unite with the second sheep’s corpuscles (antigen)—rabbit serum (hemolytic amboceptor) complex—and destroy the corpuscles. Hence if the complement is bound in the first instance, the specific amboceptor for the first antigen must have been present in the blood, that is, the animal was infected with the organism in question. Such a reaction is called a “positive” test.
On the other hand, if the final solution is clear but of a red color, that would mean that complement must have united with the corpuscles—hemolytic amboceptor system—and destroyed the corpuscles in order to cause the clear red solution of hemoglobin. If complement united with this system it could not have united with the first system, hence there was no specific amboceptor there to bind it; no specific amboceptor in the animal’s blood, means no infection. Hence a red solution is a “negative test.”
The scheme for the test may be outlined as follows:
| Antigen (specific for the amboceptor sought) | + | Patient’s Serum, heated (unknown amboceptor) | + | Complement (derived from guinea pig’s serum) |
Incubate one-half hour in a water bath or one hour in an incubator.
Then add the indicator which is
| Antigen (red blood corpuscles) | + | Amboceptor (for corpuscles, serum of a rabbit immunized against the red corpuscles) |
Incubate as above.
In practice all the different ingredients must be accurately tested, standardized and used in exact quantities, and tests must also be run as controls with a known normal blood of an animal of the same species as the one examined and with a known positive blood.
It should be stated that in one variety of the Complement Fixation Test, namely, the “Wassermann Test for Syphilis” in human beings, an antigen is used which is not derived from the specific organism (Treponema pallidum) which causes the disease nor even from syphilitic tissue. It has been determined that alcohol will extract from certain tissues, human or animal, substances which act specifically in combining with the syphilitic amboceptor present in the blood. Alcoholic extracts of beef heart are most commonly used. Details of this test may be learned in the advanced course in Immunity and Serum Therapy.
The complement-fixation test might be applied to the determination of unknown bacteria, using the unknown culture as antigen and trying it with the sera of different animals immunized against a variety of organisms, some one of which might prove to furnish specific amboceptor for the unknown organism and hence indicate what it is. The test used in this way has not been shown to be a practical necessity and hence is rarely employed. It has been used, however, to detect traces of unknown proteins, particularly blood-serum proteins, in medico-legal cases in exactly the above outlined manner and is very delicate and accurate.
It has been mentioned that Metchnikoff, in a publication in 1883, attempted to explain immunity on a purely cellular basis. It has been known since Haeckel’s first observation in 1858 that certain of the white corpuscles do engulf solid particles that may get into the body, and among them bacteria. Metchnikoff at first thought that this engulfing and subsequent intracellular digestion of the microörganisms were sufficient to protect the body from infection. The later discoveries (discussed in considering Ehrlich’s theory of immunity) of substances present in the blood serum and even in the blood plasma which either destroy the bacteria or neutralize their action have caused Metchnikoff to modify his theory to a great extent. He admitted the presence of these substances, though giving them other names, but ascribed their formation to the phagocytes or to the same organs which form the leukocytes—lymphoid tissue generally, bone marrow. It is not within the province of this work to attempt to reconcile these theories, but it may be well to point out that Ehrlich’s theory is one of chemical substances and that the origin of these substances is not an essential part of the theory, so that the two theories, except in some minor details, are not necessarily mutually exclusive.
Sir A. E. Wright and Douglas, in 1903, showed that even in those instances where immunity depends on phagocytosis, as it certainly does in many cases, the phagocytes are more or less inactive unless they are aided by chemical substances present in the blood. These substances act on the bacteria, not on the leukocytes, and change them in such a way that they are more readily taken up by the phagocytes. Wright proposed for these bodies the name opsonin, derived from a Greek word signifying “to prepare a meal for.” Neufeld and Rimpau at about the same time (1904), in studying immune sera, observed substances of similar action in these sera and proposed the name bacteriotropins, or bacteriotropic substances. There is scarcely a doubt that the two names are applied to identical substances and that Wright’s name opsonin should have preference.
The chemical nature of opsonins is not certainly determined, but they appear to be a distinct class of antibodies and to possess two groups, a combining or haptophore and a preparing or opsonic group and hence are similar to antibodies of Ehrlich’s second order—agglutinins and precipitins. Wright also showed that opsonins are just as specific as agglutinins are—that is, a micrococcus opsonin prepares micrococci only for phagocytosis and not streptococci or any other bacteria.
Wright showed that opsonins for many bacteria are present in normal serum and that in the serum of an animal which has been immunized against such bacteria the opsonins are increased in amount. Also that in a person infected with certain bacteria the opsonins are either increased or diminished, depending on whether the progress of the infection is favorable or unfavorable. The opsonic power of a serum normal or otherwise is determined by mixing an emulsion of fresh leukocytes in normal saline solution with a suspension of the bacteria and with the serum to be tested. The leukocytes must first be washed in several changes of normal salt solution to free them from any adherent plasma or serum. The mixture is incubated for about fifteen minutes and then slides are made, stained with a good differential blood stain, Wright’s or other, and the average number of bacteria taken up by at least fifty phagocytes taken in order in a field is determined by counting under the microscope. The number so obtained Wright calls the phagocytic index of the serum tested. The phagocytic index of a given serum divided by the phagocytic index of a normal serum gives the opsonic index of the serum tested. Assuming the normal opsonic index to be 1, Wright asserts that in healthy individuals the range should be not more than from 0.8 to 1.2, and that an index below 0.8 may show a great susceptibility for the organism tested, infection with the given organism if derived from the individual, or improper dosage in case attempts have been made to immunize by using killed cultures, vaccines, of the organism.
On the occasion of the author’s visit to Wright’s clinic (1911) he stated that he used the determination of the opsonic index chiefly as a guide to the dosage in the use of vaccines.
Most workers outside the Wright school have failed to recognize any essential value of determinations of the opsonic index in the use of vaccines. Some of the reasons for this are as follows: The limit of error in phagocytic counts may be as great as 50 per cent. in different series of fifty, hence several hundred must be counted, which adds greatly to the tediousness and time involved; the variation in apparently healthy individuals is frequently great, hence the “normal” is too uncertain; finally the opsonic index and the clinical course of the disease do not by any means run parallel. Undoubtedly the method has decided value in the hands of an individual who makes opsonic determinations his chief work, as Wright’s assistants do, but it can scarcely be maintained at the present time that such determinations are necessary in vaccine therapy. Nevertheless that opsonins actually exist and that they play an essential part in phagocytosis, and hence in immunity, is now generally recognized.
Whether determinations of opsonic index are useful or not is largely a matter of individual opinion, but there is scarcely room to doubt that Wright has conferred a lasting benefit by his revival of the use of dead cultures of bacteria, bacterial vaccines, both for protective inoculation and for treatment. It is perhaps better to use the older terms “vaccination” and “vaccine” (though the cow, vacca, is not concerned) than to use Wright’s term “opsonic method” in this connection, bearing in mind that the idea of a vaccine is that it contains the causative organism of the infection as indicated on p. 253.
As early as 1880 Touissant proposed the use of dead cultures of bacteria to produce immunity. But because injections of such cultures were so frequently followed by abscess formation, doubtless due to the high temperatures used to kill the bacteria, the method was abandoned. Further, Pasteur and the French school persistently denied the possibility of success with such a procedure, and some of them even maintain this attitude at the present time. The successes of Wright and the English school which are being repeated so generally wherever properly attempted, leave no doubt in the unprejudiced of the very great value of the method and have unquestionably opened a most promising field both for preventive inoculation and for treatment in many infectious diseases. That the practice is no more universally applicable than are immune serums and that it has been and is still being grossly overexploited is undoubted.
The use of a vaccine is based on two fundamental principles. The first of these is that the cell introduced must not be in a condition to cause serious injury to the animal by its multiplication and consequent elaboration of injurious substances. The second is that, on the other hand, it must contain antigens in such condition that they will act as stimuli to the body cells to produce the necessary antibodies, whether these be opsonins, bactericidal substances, or anti-endotoxins. In the introduction of living organisms there is always more or less risk of the organism not being sufficiently attenuated and hence of the possibility of its producing too severe an infection. In using killed cultures, great care must be exercised in destroying the organisms, so that the antigens are not at the same time rendered inactive. Hence in the preparation of bacterial vaccines by Wright’s method the temperature and the length of time used to kill the bacteria are most important factors. This method is in general to grow the organisms on an agar medium, rub off the culture and emulsify in sterile normal salt solution (0.85 per cent. NaCl). The number of bacteria per cc. is determined by staining a slide made from a small volume of the emulsion mixed with an equal volume of human blood drawn from the finger and counting the relative number of bacteria and of red blood corpuscles. Since the corpuscles are normally 5,000,000 per c.mm., a simple calculation gives the number of bacteria. The emulsion of bacteria is then diluted so that a certain number of millions shall be contained in each cc., “standardized” as it is called, then heated to the proper temperature for the necessary time and it is ready for use. A preservative, as 0.5 per cent. phenol, tricresol, etc., is added unless the vaccine is to be used up at once. The amounts of culture, salt solution, etc., vary with the purpose for which the vaccine is to be used, from one or two agar slant cultures and a few cc. of solution, when a single animal is to be treated, to bulk agar cultures and liters of solution as in preparing antityphoid vaccine on a large scale.
Agar surface cultures are used so that there will be as little admixture of foreign protein as possible (see Anaphylaxis, p. 289 et seq.). Normal saline solution is isotonic with the body cells and hence is employed as the vehicle.
Lipovaccines.—The suspension of bacteria in neutral oil was first used by Le Moignac and Pinoy who gave the name “lipovaccines” (λιπος = fat) to them. It was claimed that the reaction following injection of these vaccines was less severe than with saline vaccines in many instances; also, that the bacteria were much more slowly absorbed. For these two reasons it was hoped that much larger numbers of bacteria could be injected at one dose and one injection would suffice instead of three or more as ordinarily used. The technique of preparation, standardization and killing of the organisms has not as yet been sufficiently well established to warrant the general substitution of lipovaccines for ordinary saline suspensions.
Vaccines are either “autogenous” or “stock.” An “autogenous” vaccine is a vaccine that is made from bacteria derived from the individual or animal which it is desired to vaccinate and contains not only the particular organism but the particular strain of that organism which is responsible for the lesion. Stock vaccines are made up from organisms like the infective agent in a given case but derived from some other person or animal or from laboratory cultures. Commercial vaccines are “stock” vaccines and are usually “polyvalent” or even “mixed.” A “polyvalent” vaccine contains several strains of the infective agent and a “mixed” contains several different organisms.
Stock vaccines have shown their value when used as preventive inoculations, notably so in typhoid fever in man, anthrax and black-leg in cattle. The author is strongly of the opinion, not only from the extended literature on the subject, but also from his own experience in animal, and especially in human cases, that stock vaccines are much inferior and much more uncertain in their action when used in the treatment of an infection, than are autogenous vaccines. This applies particularly to those instances in which pneumococci, streptococci, micrococci, and colon bacilli are the causative agents but to others as well. The following are some of the reasons for this opinion: The above organisms are notoriously extremely variable in their virulence. While there is no necessarily close connection between virulence and antigenic property, yet since virulence is so variable, it is rational to assume that antigenic property is also extremely variable. Individuals vary just as much in susceptibility and hence in reactive power, and generally speaking, an individual will react better in the production of antibodies to a stimulus to which he has been more or less subjected, i.e., to organisms derived from his own body.
In the preparation of a vaccine great care must be used in heating so that the organisms are killed, but the antigens are not destroyed. Many of the enzymes present in bacteria, especially the proteolytic ones, are not any more sensitive to heat than are the antigens, hence are not destroyed entirely. Therefore a vaccine kept in stock for a long time gradually has some of its antigens destroyed by the uninjured enzymes present with them, and so loses in potency. Therefore in treating a given infection it is well to make up a vaccine from the lesion, use three or four doses and if more are necessary make up a new vaccine.
If the above statements are borne in mind and vaccines are made and administered accordingly, the author is well satisfied that much better results will be secured.
In accordance with the theory on which the use of vaccines is based, i.e., that they stimulate the body cells to produce immunizing antibodies, it is clear that they are especially suitable in those infections in which the process is localized and should not be of much value in general infections. In the latter case the cells of the body are stimulated to produce antibodies by the circulating organisms, probably nearly to their limit, hence the introduction of more of the same organisms, capable of stimulating though dead, is apt to overtax the cells and do more harm than good. It is not possible to tell accurately when this limit is reached, but the clinical symptoms are a guide. If vaccines are used at all in general infections they should be given in the early stages and in small doses at first with close watch as to the effect. In localized infections only the cells in the immediate neighborhood are much stimulated, hence the introduction of a vaccine calls to their aid cells in the body generally, and much more of the resulting antibodies are carried to the lesion in question. Manifestly surgical procedures such as incision, drainage, washing away of dead and necrotic tissue with normal saline solution, not necessarily antiseptics, will aid the antibodies in their action and are to be recommended where indicated.
In the practical application of any remedy the dosage is most important. Unfortunately there is no accurate method of determining this with a vaccine. Wright recommended determining the number of the organisms per cc. as before mentioned, and his method or some modification of it is still in general use. From what was said with regard to variation, both in organisms and in individuals, it can be seen that the number of organisms is at least only a very rough guide. This is further illustrated by the doses of micrococcus (staphylococcus) vaccines recommended by different writers, which vary from 50,000,000 to 2,000,000,000 per cc. The author is decidedly of the opinion that there is no way of determining the dosage of a vaccine in the treatment of any given case except by the result of the first dose. Hence it is his practice to make vaccines of a particular organism of the same approximate strength, and to give a dose of a measured portion of a cubic centimeter, judging the amount by what the individual or animal can apparently withstand, without too violent a reaction. If there is no local or general reaction or if it is very slight and there is no effect on the lesion, the dose is too small. If there is a violent local reaction with severe constitutional symptoms clinically, and the lesion appears worse, the dose is too large. There should be some local reaction and some general, but not enough to cause more than a slight disturbance, easy to judge in human subjects, more difficult in animals. In cases suitable for vaccine treatment no serious results should follow from a properly prepared vaccine, though the process of healing may be delayed temporarily. Wright claimed, and many have substantiated him, that always following a vaccination there is a period when the resistance of the animal is diminished. This is called the “negative phase,” and Wright considered this to last as long as the opsonic index remained low, and when this latter began to increase the stage of the “positive” or favorable phase was reached. As has been stated the opsonic index is pretty generally regarded as of doubtful value, though the existence of a period of lowered resistance is theoretically probable from the fact that antibodies already present in the blood will be partially used up in uniting with the vaccine introduced and that the body cells are called upon suddenly to do an extra amount of work and it takes them some time to adapt themselves. This time, the “negative phase,” is much better determined by the clinical symptoms, general and especially local. It is good practice to begin with a dose relatively small. The result of this is an indication of the proper dosage and also prepares the patient for a larger one. The second dose should follow the first not sooner than three or four days, and should be five to seven days if the first reaction is severe. These directions are not very definite, but clinical experience to date justifies them. It is worth the time and money to one who wishes to use vaccines to learn from one who has had experience both in making and administering them, and then to remember that each patient is an individual case, for the use of vaccines as well as for any other kind of treatment.
Opsonins have been shown to be specific substances which act on bacteria in such a way as to render them more readily taken up by the leukocytes. By analogy one might expect to find bacteria secreting specific substances which would tend to counteract the destructive action of the phagocytes and bactericidal substances. Bail and his co-workers claim to have demonstrated such substances in exudates in certain diseases and have given the distinctive name “aggressins” to them. By injecting an animal with “aggressins,” antiaggressins are produced which counteract their effects and thus enable the bacteria to be destroyed. The existence of such specific bodies is not generally accepted as proved. The prevailing idea is that bacteria protect themselves in any given case by the various toxic substances that they produce, and that “aggressins” as a special class of substances are not formed.
Dallera, in 1874, and a number of physiologists of that period, observed peculiar skin eruptions following the transfusion of blood, that is, the introduction of foreign proteins. In the years subsequent to the introduction of diphtheria antitoxin (1890) characteristic “serum rashes” were not infrequently reported, sometimes accompanied by more or less severe general symptoms and occasionally death—a train of phenomena to which the name “serum sickness” was later applied, since it was shown that it was the horse serum (foreign protein) that was the cause, and not the antitoxin itself. In 1898 Richet and Hericourt noticed that some of the dogs which they were attempting to immunize against toxic eel serum not only were not immunized but suffered even more severely after the second injection. They obtained similar results with an extract of mussels which contain a toxin. Richet gave the name “anaphylaxis” (“no protection”) to this phenomenon to distinguish it from immunity or prophylaxis (protection).
All the above-mentioned observations led to no special investigations as to their cause. In 1903, Arthus noticed abscess formation, necrosis and sloughing following several injections of horse serum in immediately adjacent parts of the skin in rabbits (“Arthus’ phenomenon”). Theobald Smith, in 1904, observed the death of guinea-pigs following properly spaced injections of horse serum. This subject was investigated by Otto and by Rosenau and Anderson in this country and about the same time von Pirquet and Schick were making a study of serum rashes mentioned above. The publications of these men led to a widespread study of the subject of injections of foreign proteins. It is now a well-established fact that the injection into an animal of a foreign protein—vegetable, animal or bacterial, simple or complex—followed by a second injection after a proper length of time leads to a series of symptoms indicating poisoning, which may be so severe as to cause the death of the animal. Richet’s term “anaphylaxis” has been applied to the condition of the animal following the first injection and indicates that it is in a condition of supersensitiveness for the protein in question. The animal is said to be “sensitized” for that protein.25 The sensitization is specific since an animal injected with white of chicken’s egg reacts to a second injection of chicken’s egg only and not pigeon’s egg or blood serum or any other protein. The specific poisonous substance causing the symptoms has been called “anaphylotoxin” though what it is, is still a matter of investigation. It is evident that some sort of an antibody results from the first protein injected and that it is specific for its own antigen.
A period of ten days is usually the minimum time that must elapse between the first and second injections in guinea-pigs in order that a reaction may result, though a large primary dose requires much longer. If the second injection is made within less time no effect follows, and after three or more injections at intervals of about one week the animal fails to react at all, it has become “immune” to the protein. Furthermore, after an animal has been sensitized by one injection and has reacted to a second, then, if it does not die from the reaction, it fails to react to subsequent injections. In this latter case it is said to be “antianaphylactic.”
It must be remembered that proteins do not normally get into the circulation except by way of the alimentary tract. Here all proteins that are absorbed are first broken down to their constituent amino-acids, absorbed as such and these are built up into the proteins characteristic of the animal’s blood. Hence when protein as such gets into the blood it is a foreign substance to be disposed of. The blood contains proteolytic enzymes for certain proteins normally. It is also true that the body cells possess the property of digesting the proteins of the blood and building them up again into those which are characteristic of the cell. Hence it appears rational to assume that the foreign proteins act as stimuli to certain cells to produce more of the enzymes necessary to decompose them, so that they may be either built up into cell structure or eliminated as waste. If in this process of splitting up of protein a poison were produced, then the phenomena of “anaphylaxis” could be better understood. As a matter of fact Vaughan and his co-workers have shown that by artificially splitting up proteins from many different sources—animal, vegetable, pathogenic and saprophytic bacteria—a poison is produced which appears to be the same in all cases and which causes the symptoms characteristic of anaphylaxis. On the basis of these facts it is seen that anaphylaxis is simply another variety of immunity. The specific antibody in this case is an enzyme which decomposes the protein instead of precipitating it. The enzyme must be specific for the protein since these differ in constitution. Vaughan even goes so far as to say that the poison is really the central ring common to all proteins and that they differ only in the lateral groups or side chains attached to this central nucleus. The action of the enzyme in this connection would be to split off the side chains, and since these are the specific parts of the protein, the enzyme must be specific for each protein. The pepsin of the gastric juice and the trypsin of the pancreas split the native proteins only to peptones. As is well known, these when injected in sufficient quantity give rise to poisonous symptoms, and will also give rise to anaphylaxis under properly spaced injections. They do not poison normally because they are split by the intestinal erepsin to amino-acids and absorbed as such. Whether Vaughan’s theory of protein structure is the true one or not remains to be demonstrated. It is not essential to the theory of anaphylaxis above outlined, i.e., a phenomenon due to the action of specific antibodies which are enzymes. On physiological grounds this appears the most rational of the few explanations of anaphylaxis that have been offered and was taught by the author before he had read Vaughan’s theory along the same lines.
On the basis of the author’s theory the phenomena of protein immunity and antianaphylaxis may be explained in the following way which the author has not seen presented. The enzymes necessary to decompose the injected protein are present in certain cells and are formed in larger amount by those cells to meet the increased demand due to injection of an excess of protein. They are retained in the cell for a time at least. If a second dose of protein is given before the enzymes are excreted from the cells as waste, this is digested within the cells in the normal manner. If a third dose is given, the cells adapt themselves to this increased intracellular digestion and it thus becomes normal to them. Hence the immunity is due to this increased intracellular digestion.
On the other hand, if the second injection is delayed long enough, then the excess enzyme, but not all, is excreted from the cells and meets the second dose of protein in the blood stream and rapidly decomposes it there, so that more or less intoxication from the split products results. This uses up excess enzyme, hence subsequent injections are not digested in the blood stream but within the cells as before. So that “antianaphylaxis” is dependent on the exhaustion of the excess enzyme in the blood, and the condition is fundamentally the same as protein immunity, i.e., due to intracellular digestion in each case.
As has been indicated “serum sickness” and sudden death following serum injections are probably due to a sensitization of the individual to the proteins of the horse in some unknown way. Probably hay fever urticarial rashes and idiosyncrasies following the ingestion of certain foods—strawberries, eggs, oysters, etc., are anaphylactic phenomena.
In medical practice the reaction is used as a means of diagnosis in certain diseases, such as the tuberculin test in tuberculosis, the mallein test in glanders. The individual or animal with tuberculosis becomes sensitized to certain proteins of the tubercle bacillus and when these proteins in the form of tuberculin are introduced into the body a reaction results, local or general, according to the method of introduction. The practical facts in connection with the tuberculin test are also in harmony with the author’s theory of anaphylaxis as above outlined. Milder cases of tuberculosis give more vigorous reactions because the intracellular enzymes are not used up rapidly enough since the products of the bacillus are secreted slowly in such cases. Hence excess of enzyme is free in the blood and the injection of the tuberculin meets it there and a vigorous reaction results. In old, far-advanced cases, no reaction occurs, because the enzymes are all used in decomposing the large amount of tuberculous protein constantly present in the blood. The fact that an animal which has once reacted fails to do so until several months afterward likewise depends on the fact that the excess enzyme is used in the reaction and time must elapse for a further excess to accumulate.
The anaphylactic reaction has been made use of in the identification of various types of proteins and is of very great value since the reaction is so delicate, particularly when guinea-pigs are used as test animals. Wells has detected the 0.000,001 g. of protein by this test. It is evident that the test is applicable in medico-legal cases and in food examination and has been so used.
| Antigen | Antibody | Action of Antibody | Class of Receptor |
|---|---|---|---|
| Toxin | Antitoxin | Combines with toxin and hence prevents toxin from uniting with a cell and injuring it, i.e., neutralizes toxin. | I. |
| Enzyme | Antienzyme | Combines with enzyme and thus prevents enzyme from uniting with anything else and showing its action, i.e., neutralizes enzyme. | I. |
| Solution of protein | Precipitin | Unites with its antigen and causes its precipitation from solution. | II. |
| Solution of protein | ? | Causes phenomenon of anaphylaxis(?) | (?) |
| Suspension of cells | Agglutinin | Unites with its antigen causes its clumping together and settling out of suspension. | II. |
| Suspension of cells | Opsonin | Unites with its antigen and makes the cells more easily taken up by phagocytes. | II. (?) |
| Suspension of cells | Amboceptor | Unites with its antigen and also with complement which latter then dissolves the antigen. | III. |
| Precipitin | Antiprecipitin | Neutralizes precipitin. | I. |
| Agglutinin | Antiagglutinin | Neutralizes agglutinin. | I. |
| Opsonin | Antiopsonin | Neutralizes opsonin. | I. |
| Amboceptor | Antiamboceptor (two kinds) | Neutralizes amboceptor. | I. |
| Complement | Anticomplement | Neutralizes complement. | I. |
The discussion of “immunity problems” in the preceding chapters serves to show that protection from disease either as a condition natural to the animal or as an acquired state is dependent on certain properties of its body cells or fluids, or both. The actual factors so far as at present known may be summarized as follows:
1. Antitoxins which neutralize true toxins; shown to exist for very few diseases.
2. Cytolytic substances which destroy the invading organism: in reality two substances; amboceptor, which is specific, and complement, the real dissolving enzyme.
3. Phagocytosis or the destruction of the invading organisms within the leukocytes.
4. Opsonins which render the bacteria more readily taken up by the phagocytes.
5. Enzymes other than complement possibly play a part in the destruction of some pathogenic organisms or their products. This remains to be more definitely established.
6. It is possible that in natural immunity there might be no receptors in the body cells to take up the organisms or their products, or the receptors might be present in certain cells but of a very low chemical affinity, so that combination does not occur. It is even highly probable that many substances formed by invading organisms which might injure specialized cells, such as those of glandular, nervous or muscle tissue, have a more rapid rate of reaction with, or a stronger affinity for, lower unspecialized cells, such as connective and lymphoid tissue, and unite with these so that their effects are not noticed.
The importance of these different, factors varies in different diseases and need not be considered in this connection.
The question “which of the body cells are engaged in the production of antibodies” is not uncommonly asked. On physiological grounds it would not seem reasonable that the highly specialized tissues above mentioned could take up this work, even though they are the ones which suffer the greatest injury in disease. Hence it is to be expected that the lower or unspecialized cells are the source, and it has been shown that the antibodies are produced by the phagocytes (though not entirely as Metchnikoff maintained), by lymphoid tissue generally, by the bone marrow and also by connective-tissue cells, though in varying degrees.
Since immunity depends on the activity of the body cells it is evident that one of the very best methods for avoiding infectious diseases is to keep these cells up to their highest state of efficiency, to keep in “good health.” Hence good health means not only freedom from disease but also protection against disease.
Prepared by Committee on Methods of Identification of Bacterial Species.—F. D. Chester, F. P. Gorham, Erwin F. Smith.
Endorsed by the Society for general use at the Annual Meeting, December, 1907.
(1) For decimal system of group numbers see Table I. This will be found useful as a quick method of showing close relationships inside the genus, but is not a sufficient characterization of any organism.
(2) The morphological characters shall be determined and described from growths obtained upon at least one solid medium (nutrient agar) and in at least one liquid medium (nutrient broth). Growths at 37° C. shall be in general not older than twenty-four to forty-eight hours, and growths at 20° C. not older than forty-eight to seventy-two hours. To secure uniformity in cultures, in all cases preliminary cultivation shall be practised as described in the revised Report of the Committee on Standard Methods of the Laboratory Section of the American Public Health Association, 1905.
(3) The observation of cultural and biochemical features shall cover a period of at least fifteen days and frequently longer, and shall be made according to the revised Standard Methods above referred to. All media shall be made according to the same Standard Methods.
(4) Gelatin stab cultures shall be held for six weeks to determine liquefaction.
(5) Ammonia and indol tests shall be made at end of tenth day, nitrite tests at end of fifth day.
(6) Titrate with N/20 NaOH, using phenolphthalein as an indicator; make titrations at same time from blank. The difference gives the amount of acid produced.
The titration should be done after boiling to drive off any CO2 present in the culture.
(7) Generic nomenclature shall begin with the year 1872 (Cohn’s first important paper).
Species nomenclature shall begin with the year 1880 (Koch’s discovery of the pour plate method for the separation of organisms).
(8) Chromogenesis shall be recorded in standard color terms.
| 100.0000000 | Endospores produced |
| 200.0000000 | Endospores not produced |
| 10.0000000 | Aërobic (strict) |
| 20.0000000 | Facultative anaërobic |
| 30.0000000 | Anaërobic (strict) |
| 1.0000000 | Gelatin liquefied |
| 2.0000000 | Gelatin not liquefied |
| 0.1000000 | Acid and gas from dextrose |
| 0.2000000 | Acid without gas from dextrose |
| 0.3000000 | No acid from dextrose |
| 0.4000000 | No growth with dextrose |
| 0.0100000 | Acid and gas from lactose |
| 0.0200000 | Acid without gas from lactose |
| 0.0300000 | No acid from lactose |
| 0.0400000 | No growth with lactose |
| 0.0010000 | Acid and gas from saccharose |
| 0.0020000 | Acid without gas from saccharose |
| 0.0030000 | No acid from saccharose |
| 0.0040000 | No growth with saccharose |
| 0.0001000 | Nitrates reduced with evolution of gas |
| 0.0002000 | Nitrates not reduced |
| 0.0003000 | Nitrates reduced without gas formation |
| 0.0000100 | Fluorescent |
| 0.0000200 | Violet chromogens |
| 0.0000300 | Blue chromogens |
| 0.0000400 | Green chromogens |
| 0.0000500 | Yellow chromogens |
| 0.0000600 | Orange chromogens |
| 0.0000700 | Red chromogens |
| 0.0000800 | Brown chromogens |
| 0.0000900 | Pink chromogens |
| 0.0000000 | Non-chromogenics |
| 0.0000010 | Diastasic action on potato starch, strong |
| 0.0000020 | Diastasic action on potato starch, feeble |
| 0.0000030 | Diastasic action on potato starch, absent |
| 0.0000001 | Acid and gas from glycerin |
| 0.0000002 | Acid without gas from glycerin |
| 0.0000003 | No acid from glycerin |
| 0.0000004 | No growth with glycerin |
The genus according to the system of Migula is given its proper symbol which precedes the number thus:(7)
| Bacillus coli (Esch.) Mig. | becomes B. | 222.111102 |
| Bacillus alcaligenes Petr. | becomes B. | 212.333102 |
| Pseudomonas campestris (Pam.) Sm. | becomes Ps. | 211.333151 |
| Bacterium suicida Mig. | becomes Bact. | 222.232103 |
Source..................................... Date of Isolation.................... Name..................................... Group No.(1)...............
NOTE—Underscore required terms. Observe notes and glossary of terms on opposite side of card.
| Agar Hanging-block | Orientation (grouping)............... |
| Chains (No. of elements)............... | |
| Short chains, long chains | |
| Orientation of chains, parallel, irregular. |
| Agar Hanging-block | Orientation (grouping)............... |
| Chains (No. of elements)............... | |
| Orientation of chains, parallel, irregular. |
| 1. Fermentation-tubes containing peptone-water or sugar-tree bouillon and | Dextrose | Saccharose | Lactose | Maltose | Glycerin | Mannit |
| Gas production, in per cent. | ||||||
| (H/CO2) | ||||||
| Growth in closed arm | ||||||
| Amount of acid produced 1d. | ||||||
| Amount of acid produced 2d. | ||||||
| Amount of acid produced 3d. |
| Substance | Method used | Minutes | Temperature | Killing quantity | Amt. required to restrain growth |
| BRIEF CHARACTERIZATION. Mark + or 0, and when two terms occur on a line erase the one which does not apply unless both apply. |
|||
|---|---|---|---|
| MORPHOLOGY(2) | Diameter over 1µ | ||
| Chains, filaments | |||
| Endospores | |||
| Capsules | |||
| Zooglea, Pseudozooglea | |||
| Motile | |||
| Involution forms | |||
| Gram’s stain | |||
| CULTURAL FEATURES(3) | Broth | Cloudy, turbid | |
| Ring | |||
| Pellicle | |||
| Sediment | |||
| Agar | Shining | ||
| Dull | |||
| Wrinkled | |||
| Chromogenic | |||
| Gel. Plate | Round | ||
| Proteus-like | |||
| Rhizoid | |||
| Filamentous | |||
| Curled | |||
| Gel. Stab. | Surface growth | ||
| Needle growth | |||
| Potato | Moderate, absent | ||
| Abundant | |||
| Discolored | |||
| Starch destroyed | |||
| Grows at 37° C. | |||
| Grows in Cohn’s sol. | |||
| Grows in Uschinsky’s sol. | |||
| BIOCHEMICAL FEATURES | Liquifaction | Gelatin(4) | |
| Blood-serum | |||
| Casein | |||
| Milk | Acid curd | ||
| Rennet curd | |||
| Casein peptonized | |||
| Indol(3) | |||
| Hydrogen sulphide | |||
| Ammonia(3) | |||
| Nitrates reduced(3) | |||
| Fluorescent | |||
| Luminous | |||
| DISTRIBUTION | Animal pathogen, epizoon | ||
| Plant pathogen, epiphyte | |||
| Soil | |||
| Milk | |||
| Fresh water | |||
| Salt water | |||
| Sewage | |||
| Iron bacterium | |||
| Sulphur bacterium | |||
1 Sir H. A. Blake has called attention to the fact that the “mosquito theory” of malaria is mentioned in a Sanscrit manuscript of about the 6th century A.D.↩
3 Centralblatt f. Bakteriologie, etc. LXIII. 1 Abt. Orig. 1912, 4, idem LXVI. 1 Abt. Orig. 1912, 323. ↩
4 The pronunciation of this word according to English standards is kok-si; the continental pronunciation is kok-kee; the commonest American seems to be kok-ki. We prefer the latter since it is easier and more natural and should like to see it adopted. (Author.) ↩
5 With the possible exception of blue green algæ which have been found with bacteria in the above-mentioned hot springs. Seeds of many plants have been subjected to as low temperatures as those above-mentioned without apparent injury. ↩
6 It is popularly supposed that in canning fruit, vegetables, meats, etc., all the air must be removed, since the organisms which cause “spoiling” cannot grow in a vacuum. The existence of anaërobic and facultative anaërobic bacteria shows the fallacy of such beliefs. ↩
7 “By cellulose is understood a carbohydrate of the general formula C6H10O5 not soluble in water, alcohol, ether, or dilute acids but soluble in an ammoniacal solution of copper oxide. It gives with iodine and sulphuric acid a blue color and with iodine zinc chloride a violet and yields dextrose on hydrolysis.”—H. Fischer. ↩
8 The sulphur bacteria are partially prototrophic for S; probably the iron bacteria also for Fe. Some few soil bacteria have been shown to be capable of utilizing free H, and it seems certain that the bacteria associated with the spontaneous heating of coal may oxidize free C. So far as known no elements other than these six are directly available to bacteria. ↩
9 Only a few kinds of bacteria so far as known are proto-autotrophic. The nitrous and nitric organisms of Winogradsky which are so essential in the soil, and which might have been the first of all organisms so far as their food is concerned, and some of the sulphur bacteria are examples. ↩
10 The term pathogenic is also applied to certain non-parasitic saprophytic bacteria whose products cause disease conditions, as one of the organisms causing a type of food poisoning in man (Clostridium botulinum), which also probably causes “forage poisoning” in domestic animals. ↩
11 The term “fermentation” was originally used to denote the process which goes on in fruit juices or grain extracts when alcohol and gas are formed. Later it was extended to apply to the decomposition of almost any organic substance. In recent years the attempt has been made to give a chemical definition to the word by restricting its use to those changes in which by virtue of a “wandering” or rearrangement of the carbon atoms “new substances are formed which are not constitutents of the original molecule.” It may be doubted whether this restriction is justified or necessary. A definition is at present scarcely possible except when the qualifying adjective is included as “alcoholic fermentation,” “ammoniacal fermentation,” “lactic acid fermentation,” etc. ↩
12 See “Oil and Gas in Ohio,” Bownocker: Geological Survey of Ohio, Fourth Series, Bull. I, pp. 313–314. ↩
13 It is probable that this is the way “Jack o’lanterns” or “Will o’ the wisps” are ignited. Marsh gas is produced as above outlined from the vegetable and animal matter decomposing in swampy places under anaërobic conditions and likewise phosphine. These escape into the air and the “spontaneous combustion” of the phosphine ignites the marsh gas. ↩
14 Dr. H. H. Green, of Pretoria, South Africa, has isolated from “cattle dips” a bacterium that reduces arsenates to arsenites. ↩
15 Dr. Green (l. c.) has also isolated an organism which causes some deterioration of cattle dips by oxidizing arsenites to arsenates. ↩
16 It will be noted that the names of enzymes (except some of those first discovered) terminate in ase which is usually added to the stem of the name of the substance acted on, though sometimes to a word which indicates the substance formed by the action, as lactacidase, alcoholase. ↩
17 Tetanus toxin is about 120 times as poisonous as strychnin, both of which act on the same kind of nerve cells. ↩
18 In the author’s laboratory in the past ten years all sterilization except those few objects in blood and serum work which must be dry, has been done in autoclaves of the type shown in Fig. 81 which are supplied with steam from the University central heating plant. A very great saving of time is thus secured. ↩
19 The author has tested an “electric milk purifier” (Fig. 102) which was as efficient as a first-class pasteurizer and left the milk in excellent condition both chemically and as far as “cream line” was concerned. The cost of operation as compared with steam will depend on the price of electricity. ↩
20 The exact laboratory details for preparing various media are not given in this chapter. It is the object to explain the choice of different materials and the reasons for the various processes to which they are subjected. ↩
21 For a discussion of this method of standardization consult the following:
Additional references will be found in these articles. ↩
22 Term also applied to the solidification of serum in media: e.g., the Hiss inulin medium for the differentiation of pneumococci (see diplococcus of pneumonia). ↩
23 The term “antigen” is also used to designate substances which may take the place of what are supposed to be the true antigens in certain diagnostic reactions (Chapter XXIX, Complement Fixation Test for Syphilis). ↩
24 If the antitoxin is later concentrated (see last paragraph in this chapter) a serum containing as little as 175 units per cc. may be commercially profitable. ↩
| A | B | C | D | E | F | G | H | I | J | K | L | M |
| N | O | P | Q | R | S | T | U | V | W | X | Y | Z |
Punctuation has been standardised and simple typographical errors have been repaired. Hyphenation, quotation mark usage, and obsolete/variant spelling (including variant spellings of proper nouns) have been preserved as printed.
In the original book, the page numbering goes xiii, blank, unnumbered, 18. This is a printer’s error: no pages are missing.
Repeated text in tables was indicated by dittos in the original book; here, the text is copied in full.
The descriptive chart insert has been moved from between pages 216 and 217 to the end of the book.
The following changes have also been made:
End of the Project Gutenberg EBook of The Fundamentals of Bacteriology, by
Charles Bradfield Morrey
*** END OF THIS PROJECT GUTENBERG EBOOK THE FUNDAMENTALS OF BACTERIOLOGY ***
***** This file should be named 43227-h.htm or 43227-h.zip *****
This and all associated files of various formats will be found in:
http://www.gutenberg.org/4/3/2/2/43227/
Produced by Jennifer Linklater, Jason Isbell and the Online
Distributed Proofreading Team at http://www.pgdp.net
Updated editions will replace the previous one--the old editions
will be renamed.
Creating the works from public domain print editions means that no
one owns a United States copyright in these works, so the Foundation
(and you!) can copy and distribute it in the United States without
permission and without paying copyright royalties. Special rules,
set forth in the General Terms of Use part of this license, apply to
copying and distributing Project Gutenberg-tm electronic works to
protect the PROJECT GUTENBERG-tm concept and trademark. Project
Gutenberg is a registered trademark, and may not be used if you
charge for the eBooks, unless you receive specific permission. If you
do not charge anything for copies of this eBook, complying with the
rules is very easy. You may use this eBook for nearly any purpose
such as creation of derivative works, reports, performances and
research. They may be modified and printed and given away--you may do
practically ANYTHING with public domain eBooks. Redistribution is
subject to the trademark license, especially commercial
redistribution.
*** START: FULL LICENSE ***
THE FULL PROJECT GUTENBERG LICENSE
PLEASE READ THIS BEFORE YOU DISTRIBUTE OR USE THIS WORK
To protect the Project Gutenberg-tm mission of promoting the free
distribution of electronic works, by using or distributing this work
(or any other work associated in any way with the phrase "Project
Gutenberg"), you agree to comply with all the terms of the Full Project
Gutenberg-tm License available with this file or online at
www.gutenberg.org/license.
Section 1. General Terms of Use and Redistributing Project Gutenberg-tm
electronic works
1.A. By reading or using any part of this Project Gutenberg-tm
electronic work, you indicate that you have read, understand, agree to
and accept all the terms of this license and intellectual property
(trademark/copyright) agreement. If you do not agree to abide by all
the terms of this agreement, you must cease using and return or destroy
all copies of Project Gutenberg-tm electronic works in your possession.
If you paid a fee for obtaining a copy of or access to a Project
Gutenberg-tm electronic work and you do not agree to be bound by the
terms of this agreement, you may obtain a refund from the person or
entity to whom you paid the fee as set forth in paragraph 1.E.8.
1.B. "Project Gutenberg" is a registered trademark. It may only be
used on or associated in any way with an electronic work by people who
agree to be bound by the terms of this agreement. There are a few
things that you can do with most Project Gutenberg-tm electronic works
even without complying with the full terms of this agreement. See
paragraph 1.C below. There are a lot of things you can do with Project
Gutenberg-tm electronic works if you follow the terms of this agreement
and help preserve free future access to Project Gutenberg-tm electronic
works. See paragraph 1.E below.
1.C. The Project Gutenberg Literary Archive Foundation ("the Foundation"
or PGLAF), owns a compilation copyright in the collection of Project
Gutenberg-tm electronic works. Nearly all the individual works in the
collection are in the public domain in the United States. If an
individual work is in the public domain in the United States and you are
located in the United States, we do not claim a right to prevent you from
copying, distributing, performing, displaying or creating derivative
works based on the work as long as all references to Project Gutenberg
are removed. Of course, we hope that you will support the Project
Gutenberg-tm mission of promoting free access to electronic works by
freely sharing Project Gutenberg-tm works in compliance with the terms of
this agreement for keeping the Project Gutenberg-tm name associated with
the work. You can easily comply with the terms of this agreement by
keeping this work in the same format with its attached full Project
Gutenberg-tm License when you share it without charge with others.
1.D. The copyright laws of the place where you are located also govern
what you can do with this work. Copyright laws in most countries are in
a constant state of change. If you are outside the United States, check
the laws of your country in addition to the terms of this agreement
before downloading, copying, displaying, performing, distributing or
creating derivative works based on this work or any other Project
Gutenberg-tm work. The Foundation makes no representations concerning
the copyright status of any work in any country outside the United
States.
1.E. Unless you have removed all references to Project Gutenberg:
1.E.1. The following sentence, with active links to, or other immediate
access to, the full Project Gutenberg-tm License must appear prominently
whenever any copy of a Project Gutenberg-tm work (any work on which the
phrase "Project Gutenberg" appears, or with which the phrase "Project
Gutenberg" is associated) is accessed, displayed, performed, viewed,
copied or distributed:
This eBook is for the use of anyone anywhere at no cost and with
almost no restrictions whatsoever. You may copy it, give it away or
re-use it under the terms of the Project Gutenberg License included
with this eBook or online at www.gutenberg.org
1.E.2. If an individual Project Gutenberg-tm electronic work is derived
from the public domain (does not contain a notice indicating that it is
posted with permission of the copyright holder), the work can be copied
and distributed to anyone in the United States without paying any fees
or charges. If you are redistributing or providing access to a work
with the phrase "Project Gutenberg" associated with or appearing on the
work, you must comply either with the requirements of paragraphs 1.E.1
through 1.E.7 or obtain permission for the use of the work and the
Project Gutenberg-tm trademark as set forth in paragraphs 1.E.8 or
1.E.9.
1.E.3. If an individual Project Gutenberg-tm electronic work is posted
with the permission of the copyright holder, your use and distribution
must comply with both paragraphs 1.E.1 through 1.E.7 and any additional
terms imposed by the copyright holder. Additional terms will be linked
to the Project Gutenberg-tm License for all works posted with the
permission of the copyright holder found at the beginning of this work.
1.E.4. Do not unlink or detach or remove the full Project Gutenberg-tm
License terms from this work, or any files containing a part of this
work or any other work associated with Project Gutenberg-tm.
1.E.5. Do not copy, display, perform, distribute or redistribute this
electronic work, or any part of this electronic work, without
prominently displaying the sentence set forth in paragraph 1.E.1 with
active links or immediate access to the full terms of the Project
Gutenberg-tm License.
1.E.6. You may convert to and distribute this work in any binary,
compressed, marked up, nonproprietary or proprietary form, including any
word processing or hypertext form. However, if you provide access to or
distribute copies of a Project Gutenberg-tm work in a format other than
"Plain Vanilla ASCII" or other format used in the official version
posted on the official Project Gutenberg-tm web site (www.gutenberg.org),
you must, at no additional cost, fee or expense to the user, provide a
copy, a means of exporting a copy, or a means of obtaining a copy upon
request, of the work in its original "Plain Vanilla ASCII" or other
form. Any alternate format must include the full Project Gutenberg-tm
License as specified in paragraph 1.E.1.
1.E.7. Do not charge a fee for access to, viewing, displaying,
performing, copying or distributing any Project Gutenberg-tm works
unless you comply with paragraph 1.E.8 or 1.E.9.
1.E.8. You may charge a reasonable fee for copies of or providing
access to or distributing Project Gutenberg-tm electronic works provided
that
- You pay a royalty fee of 20% of the gross profits you derive from
the use of Project Gutenberg-tm works calculated using the method
you already use to calculate your applicable taxes. The fee is
owed to the owner of the Project Gutenberg-tm trademark, but he
has agreed to donate royalties under this paragraph to the
Project Gutenberg Literary Archive Foundation. Royalty payments
must be paid within 60 days following each date on which you
prepare (or are legally required to prepare) your periodic tax
returns. Royalty payments should be clearly marked as such and
sent to the Project Gutenberg Literary Archive Foundation at the
address specified in Section 4, "Information about donations to
the Project Gutenberg Literary Archive Foundation."
- You provide a full refund of any money paid by a user who notifies
you in writing (or by e-mail) within 30 days of receipt that s/he
does not agree to the terms of the full Project Gutenberg-tm
License. You must require such a user to return or
destroy all copies of the works possessed in a physical medium
and discontinue all use of and all access to other copies of
Project Gutenberg-tm works.
- You provide, in accordance with paragraph 1.F.3, a full refund of any
money paid for a work or a replacement copy, if a defect in the
electronic work is discovered and reported to you within 90 days
of receipt of the work.
- You comply with all other terms of this agreement for free
distribution of Project Gutenberg-tm works.
1.E.9. If you wish to charge a fee or distribute a Project Gutenberg-tm
electronic work or group of works on different terms than are set
forth in this agreement, you must obtain permission in writing from
both the Project Gutenberg Literary Archive Foundation and Michael
Hart, the owner of the Project Gutenberg-tm trademark. Contact the
Foundation as set forth in Section 3 below.
1.F.
1.F.1. Project Gutenberg volunteers and employees expend considerable
effort to identify, do copyright research on, transcribe and proofread
public domain works in creating the Project Gutenberg-tm
collection. Despite these efforts, Project Gutenberg-tm electronic
works, and the medium on which they may be stored, may contain
"Defects," such as, but not limited to, incomplete, inaccurate or
corrupt data, transcription errors, a copyright or other intellectual
property infringement, a defective or damaged disk or other medium, a
computer virus, or computer codes that damage or cannot be read by
your equipment.
1.F.2. LIMITED WARRANTY, DISCLAIMER OF DAMAGES - Except for the "Right
of Replacement or Refund" described in paragraph 1.F.3, the Project
Gutenberg Literary Archive Foundation, the owner of the Project
Gutenberg-tm trademark, and any other party distributing a Project
Gutenberg-tm electronic work under this agreement, disclaim all
liability to you for damages, costs and expenses, including legal
fees. YOU AGREE THAT YOU HAVE NO REMEDIES FOR NEGLIGENCE, STRICT
LIABILITY, BREACH OF WARRANTY OR BREACH OF CONTRACT EXCEPT THOSE
PROVIDED IN PARAGRAPH 1.F.3. YOU AGREE THAT THE FOUNDATION, THE
TRADEMARK OWNER, AND ANY DISTRIBUTOR UNDER THIS AGREEMENT WILL NOT BE
LIABLE TO YOU FOR ACTUAL, DIRECT, INDIRECT, CONSEQUENTIAL, PUNITIVE OR
INCIDENTAL DAMAGES EVEN IF YOU GIVE NOTICE OF THE POSSIBILITY OF SUCH
DAMAGE.
1.F.3. LIMITED RIGHT OF REPLACEMENT OR REFUND - If you discover a
defect in this electronic work within 90 days of receiving it, you can
receive a refund of the money (if any) you paid for it by sending a
written explanation to the person you received the work from. If you
received the work on a physical medium, you must return the medium with
your written explanation. The person or entity that provided you with
the defective work may elect to provide a replacement copy in lieu of a
refund. If you received the work electronically, the person or entity
providing it to you may choose to give you a second opportunity to
receive the work electronically in lieu of a refund. If the second copy
is also defective, you may demand a refund in writing without further
opportunities to fix the problem.
1.F.4. Except for the limited right of replacement or refund set forth
in paragraph 1.F.3, this work is provided to you 'AS-IS', WITH NO OTHER
WARRANTIES OF ANY KIND, EXPRESS OR IMPLIED, INCLUDING BUT NOT LIMITED TO
WARRANTIES OF MERCHANTABILITY OR FITNESS FOR ANY PURPOSE.
1.F.5. Some states do not allow disclaimers of certain implied
warranties or the exclusion or limitation of certain types of damages.
If any disclaimer or limitation set forth in this agreement violates the
law of the state applicable to this agreement, the agreement shall be
interpreted to make the maximum disclaimer or limitation permitted by
the applicable state law. The invalidity or unenforceability of any
provision of this agreement shall not void the remaining provisions.
1.F.6. INDEMNITY - You agree to indemnify and hold the Foundation, the
trademark owner, any agent or employee of the Foundation, anyone
providing copies of Project Gutenberg-tm electronic works in accordance
with this agreement, and any volunteers associated with the production,
promotion and distribution of Project Gutenberg-tm electronic works,
harmless from all liability, costs and expenses, including legal fees,
that arise directly or indirectly from any of the following which you do
or cause to occur: (a) distribution of this or any Project Gutenberg-tm
work, (b) alteration, modification, or additions or deletions to any
Project Gutenberg-tm work, and (c) any Defect you cause.
Section 2. Information about the Mission of Project Gutenberg-tm
Project Gutenberg-tm is synonymous with the free distribution of
electronic works in formats readable by the widest variety of computers
including obsolete, old, middle-aged and new computers. It exists
because of the efforts of hundreds of volunteers and donations from
people in all walks of life.
Volunteers and financial support to provide volunteers with the
assistance they need are critical to reaching Project Gutenberg-tm's
goals and ensuring that the Project Gutenberg-tm collection will
remain freely available for generations to come. In 2001, the Project
Gutenberg Literary Archive Foundation was created to provide a secure
and permanent future for Project Gutenberg-tm and future generations.
To learn more about the Project Gutenberg Literary Archive Foundation
and how your efforts and donations can help, see Sections 3 and 4
and the Foundation information page at www.gutenberg.org
Section 3. Information about the Project Gutenberg Literary Archive
Foundation
The Project Gutenberg Literary Archive Foundation is a non profit
501(c)(3) educational corporation organized under the laws of the
state of Mississippi and granted tax exempt status by the Internal
Revenue Service. The Foundation's EIN or federal tax identification
number is 64-6221541. Contributions to the Project Gutenberg
Literary Archive Foundation are tax deductible to the full extent
permitted by U.S. federal laws and your state's laws.
The Foundation's principal office is located at 4557 Melan Dr. S.
Fairbanks, AK, 99712., but its volunteers and employees are scattered
throughout numerous locations. Its business office is located at 809
North 1500 West, Salt Lake City, UT 84116, (801) 596-1887. Email
contact links and up to date contact information can be found at the
Foundation's web site and official page at www.gutenberg.org/contact
For additional contact information:
Dr. Gregory B. Newby
Chief Executive and Director
gbnewby@pglaf.org
Section 4. Information about Donations to the Project Gutenberg
Literary Archive Foundation
Project Gutenberg-tm depends upon and cannot survive without wide
spread public support and donations to carry out its mission of
increasing the number of public domain and licensed works that can be
freely distributed in machine readable form accessible by the widest
array of equipment including outdated equipment. Many small donations
($1 to $5,000) are particularly important to maintaining tax exempt
status with the IRS.
The Foundation is committed to complying with the laws regulating
charities and charitable donations in all 50 states of the United
States. Compliance requirements are not uniform and it takes a
considerable effort, much paperwork and many fees to meet and keep up
with these requirements. We do not solicit donations in locations
where we have not received written confirmation of compliance. To
SEND DONATIONS or determine the status of compliance for any
particular state visit www.gutenberg.org/donate
While we cannot and do not solicit contributions from states where we
have not met the solicitation requirements, we know of no prohibition
against accepting unsolicited donations from donors in such states who
approach us with offers to donate.
International donations are gratefully accepted, but we cannot make
any statements concerning tax treatment of donations received from
outside the United States. U.S. laws alone swamp our small staff.
Please check the Project Gutenberg Web pages for current donation
methods and addresses. Donations are accepted in a number of other
ways including checks, online payments and credit card donations.
To donate, please visit: www.gutenberg.org/donate
Section 5. General Information About Project Gutenberg-tm electronic
works.
Professor Michael S. Hart was the originator of the Project Gutenberg-tm
concept of a library of electronic works that could be freely shared
with anyone. For forty years, he produced and distributed Project
Gutenberg-tm eBooks with only a loose network of volunteer support.
Project Gutenberg-tm eBooks are often created from several printed
editions, all of which are confirmed as Public Domain in the U.S.
unless a copyright notice is included. Thus, we do not necessarily
keep eBooks in compliance with any particular paper edition.
Most people start at our Web site which has the main PG search facility:
www.gutenberg.org
This Web site includes information about Project Gutenberg-tm,
including how to make donations to the Project Gutenberg Literary
Archive Foundation, how to help produce our new eBooks, and how to
subscribe to our email newsletter to hear about new eBooks.